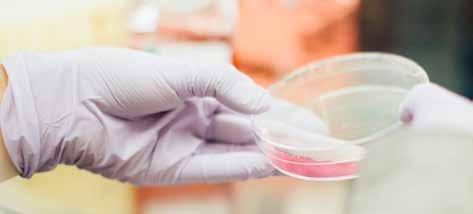

auf jeder Seite oben einfach daraufklicken und du kommst zur Webseite
![]()

auf jeder Seite oben einfach daraufklicken und du kommst zur Webseite
© 2025 Kurt Beutler
Alle Rechte vorbehalten. Kein Teil dieser Publikation darf ohne schriftliche Genehmigung des Herausgebers in irgendeiner Form reproduziert und unter Verwendung elektronischer Systeme verarbeitet, vervielfältigt oder verbreitet werden. e-book Version: deutsch 7 (-ho-) 8. Juli 2025 Herausgeber: Projekt-Team historychanger.info
Bildquellen: unsplash, pexels, canva, pixabay
Grundsätzlich ist das e-book frei. Gerne empfehlen wir für das gesamte Projekt welches Unterhalt benötigt und in weiteren Sprachen angedacht ist eine freie Spende.
Anfragen sind über die Webseite historychanger.info möglich.
History changer
Diese Buttons findest du an verschiedenen Orten im «e-book». Sie leiten dich beim Draufklicken zum passenden Thema auf der Webseite.
a)
2.1.)
Dank gehört dem Projekt-Team, welches mich beauftragte, dieses Buch als Ergänzung zur Webseite (historychanger.info) zu verfassen.
Ganz besonderen Dank meinen Freunden der MEOS (www.meos.ch), die mich freigestellt haben, das zu tun, was mir wirklich auf dem Herzen lag.

Quelle: unsplash / jon tyson
«Lügen haben kurze Beine», sagt man. Das ist allerdings leider nicht immer so. Es gibt Lügen bzw. Irrtümer, die über Jahrhunderte bestehen bleiben. Doch irgendeinmal werden sie aufgedeckt.
In diesem Buch wird erklärt, dass die Entstehung der modernen Welt ganz anders ablief, als es normalerweise dargestellt wird. So sehr sogar, dass wir dieses Buch und die dazugehörige Webseite «historychanger.info» nennen.
Natürlich bin ich nicht der Erste, der zu dieser Erkenntnis kommt. Ich habe dicke Bücher durchstudiert. Ihr wisst, wie das ist mit Geschichtsbüchern. Detail um Detail. Das Problem ist, dass die meisten Schreiber extrem in die Einzelheiten gehen und derart dicke Bände geschrieben haben, dass nur wenige Leute ihre wertvollen Gedanken überhaupt lesen. Für diejenigen Leser, welche sich trotzdem für die Details interessieren, haben wir einige dieser Bücher am Ende der Webseite aufgelistet. (Link zur Liste anklicken)
Mein Anliegen ist, so kurz wie möglich, aber trotzdem kompetent zu schreiben. Für Leser, die Mühe haben, sich zu konzentrieren, oder zeitlich begrenzt sind, ist es auch möglich, nur einzelne Kapitel durchzugehen. Darum werde ich jetzt gleich beginnen und zwar mit sechs grundlegenden Irrtümern. Diese sind derart verbreitet, dass sogar Journalisten und Lehrer sie oft einfach wiederholen, ohne auch nur darüber nachzudenken, ob sie denn auch wirklich stimmen.
Danach werden wir sehen, dass der Weg zur modernen Welt schwieriger war als manche es sich vorstellen. Das kann man sich so wie eine Treppe vorstellen. Es gab keine Abkürzungen. Man musste eine Stufe um die andere nehmen.
Insgesamt werden wir ein Rätsel zu lösen haben, nämlich weshalb es ausgerechnet das kleine Europa, bzw. ein Teil davon war, der die Welt total verändert hat. Unglaublich nicht nur, welche Erfindungen hier gemacht wurden, sondern auch die Menschenrechte, die zum ersten Mal in der Menschheitsgeschichte durchgesetzt wurden.
Was in Europa selbstverständlich ist, bleibt allerdings in den meisten Ländern dieser Welt ein Traum. Deswegen zieht es die Menschen hierhin. Doch woher kommen die Werte, die uns so wichtig sind? Wieso sind sie hier Allgemeingut geworden, während sie anderswo bis heute völlig abgelehnt werden?
Egal wie man es dreht und wendet: Die Bibel ist nicht wegzudenken aus der Geschichte Europas. Darum kommen wir dann auf sie zu sprechen. Sie ist einerseits nach wie vor das einflussreichste Buch, andererseits belächelt und verspottet. Was spricht für ihre Glaubwürdigkeit? Wenn sie nach wie vor wertvoll ist, wieso ist sie dann derart verachtet? Was wird geschehen, falls Europa sich ganz davon wegwendet?

Man könnte natürlich noch viele andere Irrtümer über die Geschichte Europas untersuchen. Wir beschränken uns hier auf sechs, die aber in dem Sinn fundamental sind, dass sie unser Bild über die Vergangenheit total verändern. Einerseits könnte man denken, dass es keine grosse Rolle spielt, ob es alte Griechen oder andere Leute waren, welche die Demokratie erfanden. Doch wenn wir den Wert der Demokratie erkennen, dann ist es wichtig zu wissen, woher so viel Gutes in unsere Kultur gekommen ist. Denn falls wir uns in diesem Bereich irren, stehen wir in grösster Gefahr, unser politisches System und damit Sicherheit und Wohlstand zu verlieren.

Lehrer, Autoren und der Volksmund erzählen landauf und ab, dass die alten Griechen die Demokratie erfunden hätten, und der Beweis dafür scheint einfach: Schliesslich stammt ja das Wort Demokratie «Volksherrschaft» aus dem Griechischen. Leider macht sich kaum jemand die Mühe, zu prüfen, was denn damals eigentlich unter Demokratie verstanden wurde. Wer nämlich genauer hinschaut, merkt, dass wir da einem grossen Missverständnis auf den Leim gegangen sind. Eine wirkliche Demokratie kann es damals unmöglich gegeben haben, denn diese benötigt mehrere Voraussetzungen. Eigentlich sollten wir aus unserer eigenen Erfahrung wissen, dass es gar nicht so einfach ist, eine wirkliche Demokratie hinzukriegen, denn dies ist bis zum heutigen Tag sogar in unserer modernen Welt eine Seltenheit.
Dies wird schon bei der ersten Bedingung klar. Absolute Notwendigkeit ist die Überzeugung, dass alle Menschen gleichwertig seien. Doch leider war diese Idee im gesamten Altertum noch nicht vorhanden. So verherrlichten auch die alten Griechen beispielsweise Philosophen und Erstgeborene nobler Familien, während sie alle körperlich Arbeitenden, Zweitgeborenen, Frauen und Sklaven verachteten und benachteiligten.
Die zweite Voraussetzung ist die Überzeugung, dass es allgemeine Menschenrechte geben muss, die ausnahmslos für alle Bürger gelten. Diese zwei Bedingungen bauen auf einander auf. Doch auch dies gab es bei den alten Griechen nicht, denn Sklaven hatten natürlich niemals die gleichen Rechte wie freie Bürger.
Zur Demokratie gehört weiter die Gewaltentrennung. Das ist das Gegenteil des Alleinherrschers, der selber das Gesetz und zugleich dessen Ausführung ist. Zudem kann er seine eigenen Gesetze auch wieder übergehen, wenn er will und jederzeit jeden beliebigen Bürger vernichten. Er benutzt Gesetze nur zum Alibi, erlaubt ihnen aber nicht, die Mitmenschen wirklich zu schützen. Niemand kann ihn zur Rechenschaft ziehen. Die Demokratie dagegen schützt die Rechte jedes Bürgers, weil sie die Macht der einzelnen Politiker ausnahmslos begrenzt, indem sie diese auf verschiedene Personen aufteilt. Zudem kann jeder zur Rechenschaft gezogen werden, auch der Höchste. Da gibt es zum Einen Parlamentarier, welche Gesetze nur beschliessen, und zwar als Gruppe. Nicht sie, sondern andere Personen sind die Ausführenden. Dazu gibt es noch unabhängige Richter, welche alles überwachen. Das alles geschieht idealerweise auf mehreren Ebenen (Stadt, Bundesland, Bund).
Zudem sind alle diese Politiker nur zeitlich begrenzt in der Regierung. Regelmässig werden sie durch andere ersetzt.
Warum so kompliziert, wenn es doch auch viel einfacher ginge? Die Motivation zu diesem komplexen System kommt daher, dass man niemandem über den Weg traut. Dieses System wird nur von Menschen befürwortet, welche erkannt haben, dass es gefährlich ist, jemandem zu viel Macht zu geben, der dann plötzlich alles an sich reisst. Die vierte absolut notwendige Voraussetzung für die Demokratie ist also die Überzeugung, dass jeder, auch der beste Mensch potenziell korrupt sein könnte. Wer meint, dass es absolut gute Menschen gibt, wird nicht die Demokratie, sondern eine Alleinherrschaft wählen und den seiner Ansicht nach besten Menschen auf den Thron setzen. Nur wenn ich überzeugt bin, dass absolut jeder Mensch, ich eingeschlossen, zu gefährlichem Egoismus neigt, und jedermanns Macht begrenzt werden muss, machen Gewaltentrennung und Demokratie Sinn.
In vielen Teilen der Welt sind alle Versuche, Demokratien zu errichten, fehlgeschlagen. Man stürzte zwar Diktatoren, doch die neuen Regierungen wurden gleich wieder korrupt. Warum? Weil die oben beschriebenen Voraussetzungen fehlten. Es wurden Wahlen organisiert, Gewaltentrennung befohlen, Parlamente und Minister eingesetzt, aber es war alles auf Sand
gebaut. Wieso? Weil die Menschen nach wie vor ihre eigenen Verwandten, ihren eigenen Stamm und ihre eigene Religion über die anderen stellten. Die Bereitschaft, Andersartigen fair und ehrlich gleiche Rechte zu geben, war und ist ganz einfach nicht vorhanden. Als gleichwertig werden nur die eigenen Leute angesehen und nur sie erhalten garantiertes Anrecht auf Menschenrechte. So wird das scheinbar demokratische System nur zu einem Theater.
Der Muslim z.B. glaubt, dass Mohammed in Alleinherrschaft ein absolut gerechtes Reich errichtet habe. Was soll er da mit dem ganzen Krimskrams der Demokratie anfangen, wenn es doch viel einfacher wäre, einen neuen Kalifen einzusetzen, der alles richtig macht?! Ein Blick auf die Geschichte vergangener Kalifen, ihre Machtkämpfe, Brudermorde und Bürgerkriege lässt allerdings grosse Zweifel aufkommen, ob sie die Idealherrscher waren, die manche sich vorstellen. Ähnlich ging es in der kommunistischen Welt, wo man von der Überzeugung ausging, dass Kapitalisten das Problem seien. Der Arbeiterschicht dagegen könne man die Macht bedenkenlos in die Hand geben. Die würden automatisch Gutes tun. Das war allerdings ein fataler Irrtum, denn das Resultat waren Dutzende Millionen von Toten.
Es war eben nicht ein Muslim und kein Kommunist, der die Demokratie erfand. Die erste Voraussetzung, nämlich die Überzeugung, dass jeder Mensch ein Anrecht auf Grundrechte habe, entstand erstmals in der Weltgeschichte in Europa, ausgerechnet im vermeintlich «finsteren» Mittelalter, und wurde erstmalig schon bei der sogenannten gregorianischen Reform ausgesät. Damals drängte die katholische Kirche die Fürsten, sogar ihren Sklaven grundlegende Rechte zu geben, und wehrte sich für die Benachteiligten. Auch wenn die praktische Umsetzung auf sich warten liess, wurde später diese Forderung von verschiedenen Seiten so lange immer und immer wieder hervorgeholt, bis sie sich über Jahrhunderte fest ins europäische Denken eingeprägt hatte. Davon werden wir später noch sprechen.
Doch Grundrechte garantieren noch nicht gleiche Rechte. Auch die zweite Voraussetzung, die Forderung, dass jeder Mensch Anrecht auf gleiche Rechte habe, wurde bereits früh formuliert. Sie blieb aber lange ein Papiertiger. Wirklich einflussreich wurde sie erst seit dem 17. Jhd. als der englische Arzt John Locke erneut propagierte, dass ausnahmslos jeder Mensch Recht auf Leben, auf Eigentum, und auf Meinungsfreiheit haben
müsse. Diese drei Grundrechte leitete er detailliert aus der Bibel ab. Er war es auch, der als vielleicht Erster erkannte, dass man zum Schutz der Bürger gesetzgebende von ausführenden Politikern trennen muss, und so die Gewaltentrennung erfand.
Obwohl sie kompliziert sind, sind Demokratien erfolgreich. Durch die Fairness, Freiheit und Stabilität, welche sie bieten, haben ihre Ökonomien wirtschaftliches und technisches Know-how entwickelt, welches die meisten anderen Staaten überflügelt. Aber sie haben einen Nachteil: Politisch bringen sie kaum Supermänner hervor. Jeder ist in seinem Einflussbereich begrenzt und muss über kurz oder lang wieder abtreten. Das widerspricht dem, was der Mensch sich eigentlich zutiefst wünscht. Demokratien widersprechen also eigentlich der menschlichen Natur und deren Egoismus und sind deshalb alles andere als selbstverständlich.
Was John Locke damals sagte, gilt bis heute: Die meisten Regierungen dieser Welt sind in Wirklichkeit nicht viel mehr als Räuber, die den grössten Teil des Volkes aussaugen. Wer nicht davon überzeugt ist, dass die Demokratie wertvoll ist, soll doch einmal hören, was Asylanten über die Menschenrechtssituation in ihren Ländern erzählen. Vielerorts kann man jederzeit von der eigenen Regierung entführt werden und für immer verschwinden, ohne dass sich jemand getrauen würde, nachzufragen. Wir kommen später zu diesen Fragen zurück. Nun kommen wir zum zweiten Irrtum über die Geschichte Europas:

Viele Menschen würden problemlos «ja» sagen, obwohl an diesem Satz nichts, aber auch gar nichts stimmt. Es war nicht im Mittelalter, es waren nicht Millionen, und es war auch nicht die Kirche. Fast alles, was der moderne Europäer über die Hexenverfolgung zu wissen glaubt, ist falsch. Zu diesem Schluss kommt beispielsweise auch eine Sendung von WDR 2 («Hexen?» 7.9.2018).
Tatsächlich stammt die Verbrennung von Zauberern von den vorchristlichen Germanen. Sie fürchteten sich vor den Machenschaften von Menschen, die mit finsteren Mächten in Kontakt waren, und wussten sich nicht anders zu helfen, als sie zu verbrennen. Es handelt sich also keineswegs um einen christlichen, sondern um einen uralten heidnischen Brauch. Und damit kommen wir gleich zur zweiten Überraschung: «Einer systematischen Hexenverfolgung wurde von kirchlicher Seite her aber jahrhundertelang ein relativ stabiler Riegel vorgeschoben». Tatsächlich gab es nach der Ankunft des Christentums etwa einen 1000-jährigen Unterbruch der Hexenverfolgungen, weil die Kirche erklärte, Hexen gebe es gemäss den Aussagen der Bibel gar nicht, also müsse man sich auch nicht vor ihnen fürchten. Angeklagte - ob Frauen oder Männer - erhielten sogar Zuflucht in Kirchen. Päpste ermahnten Edelleute, so wie etwa Papst Gregor VII den dänischen König Harald, «nicht bei der Verfolgung von Frauen mitzuma-
chen, denen man die Schuld an Unwettern, Stürmen und manchen Krankheiten gibt. Dies sei nämlich unchristlich, unmenschlich und barbarisch.» (Tagespost vom 26.8.2020). Diese und ähnliche Worte wurden im Jahr 1080, im Hochmittelalter geschrieben. Damit sei auch auf einen weiteren Mythos hingewiesen: Hexenverfolgungen fanden nicht etwa im Mittelalter statt, sondern vor und nach diesem vermeintlich finsteren Zeitalter. «Erst als zu Beginn der Neuzeit das Christentum an Prägekraft einbüsst, macht sich wieder der alte germanische Hexenglaube breit.» (WDR 2).
Ein weiterer Fehler ist, dass Hexenverfolgungen oft so dargestellt werden, als hätten sie nur in Europa stattgefunden. In Wirklichkeit handelt es sich um ein weltweites Phänomen. In der westlichen Welt hat man diese traurigen Ereignisse zwar viel häufiger dokumentiert. Doch es gibt sie auf allen Kontinenten und zwar seit Urzeiten und bis heute. Siehe etwa «Bild» vom 26.12.2017: «Hexenverfolgung im 21. Jhd.: Jedes Jahr Tausende Opfer». Der Historiker Rune Blix Hagen von der Universität Tromsö erklärt: «Allein in den vergangenen 50 Jahren wurden mehr Hexen getötet als damals in Europa (süddeutsche.de, 7. Mai 2010). Im Durchschnitt der letzten 2000 Jahre ist Europa wohl sogar der Kontinent mit den wenigsten Hexentoten.
Doch woher kommt der Hass gegen sogenannte «Hexen» überhaupt?
Geschieht das alles aus reiner Boshaftigkeit, oder nur aus Neid gegen alleinstehende Frauen? Tatsächlich sind ein Drittel der Getöteten auch Männer. Genauere Beobachtung zeigt, dass Hexenverfolgungen fast immer Volksbewegungen sind. Oft sind es ganze Dorfbevölkerungen, welche eine beschuldigte Person vor ein Gericht schleifen, oder sie gleich ohne Richter ermorden. Doch was hat sie derart fanatisiert? Oft ist nur irrationale Hysterie zu beobachten. Aber am Grund der Sache findet sich Angst. Diese hat durchaus einen logischen Grund. Das sehen wir z.B. an folgender Geschichte aus dem modernen Indien: («Netzfrauen» vom 30.April 2016): «In Neu Delhi rettete die Polizei ein entführtes vier Monate altes Mädchen und nahm drei Männer fest – darunter den Onkel der Kleinen, der sie für ein Opferritual an einen Hexer verkauft haben soll». So weit so gut. Die Polizei tut ihren Job. Doch das aufgebrachte Volk hatte kein Vertrauen in die Polizei und wollte die Familie lieber selber strafen. Ein paar Tage später griff ein Mob aus hunderten Dorfbewohnern die Verwandten jenes Onkels an, «schloss die Familie in ihrem Haus ein und steckte es in Brand. Drei der Eingeschlossenen verbrannten bei lebendigem Leib, fünf wurden gerettet…»
Es gibt tatsächlich Menschen, die an Dämonen glauben und ihnen Menschenopfer darbringen - meist insgeheim gezeugte und geborene Babies oder entführte Kinder. Die Angst vor ihnen kann sich leicht zum Volkszorn steigern und an Verdächtigen entladen. Ohne saubere Aufklärung trifft es dann oft die Falschen.
Dabei muss man wissen, dass Europa am Ende des Mittelalters von ungeheuren Katastrophen heimgesucht wurde. An einer einzigen Pestwelle starb ein Drittel der Gesamtbevölkerung, dazu Missernten, Kriege und andere Desaster. Es war, als ob der Kontinent verflucht wäre. Mit der Zeit glaubten die germanischen Völker der Kirche nicht mehr, welche behauptete, dass es Hexen nicht gebe. Sie erinnerten sich, dass ihre Urahnen zum Selbstschutz einst Hexen hingerichtet hatten. So begannen jene 2-300 Jahre der Hexenverfolgung in Nordeuropa (1450-1750), die in einigen Gegenden völlig überbordete. Jeder fürchtete sich vor jedem. Es wird sogar von Richtern erzählt, welche Angeklagte freisprachen, und deswegen selber von der Volksmenge als Hexerfreunde gehenkt wurden. Auch ein Teil der Kirche wurde mitgerissen, wie etwa die Hetzschrift des Dominikanermönchs Heinrich Kramer zeigt. Diese Volksbewegung war so stark, dass sogar Aufklärer wie Thomas Hobbes und Jean Bodin sowie einige der Reformatoren Verständnis dafür zeigten.
Der Historiker Peter Stegt erklärt allerdings in www.bild.de vom 19.1.2019: «Die Kirche war nie direkt an den Hexenprozessen beteiligt». Der Eindruck, als ob die Kirche Hexenprozesse organisiert hätte, entstand wohl dadurch, dass auf den Bildern oft Priester zu sehen sind, welche die Verurteilten zur Hinrichtung begleiten. Es ist bezeichnend, dass manche Priester und Edelmänner, welche dem Treiben ein Ende setzen wollten, sogar selber auf dem Scheiterhaufen landeten. (planet-wissen.de/Geschichte/Neuzeit/ Hexenverfolgung).
Auch Arnold Angenendt erklärt in katholisch.de (2.8.2020), dass die Inquisition kaum Hexenprozesse geführt habe und wenn, dann mit praktisch sicherem Freispruch. WRD 2 (7.9.2018) bestätigt: «Es war vor allem die moderne weltliche Justiz, die die Hexenprozesse durchführte». Dass die Verfolgungen schliesslich in Europa zu einem gründlichen Ende kamen, ist nicht nur der Aufklärung, sondern auch christlichen Autoren wie Friedrich Spree zu verdanken («Cautio Criminalis»).

Quelle: unsplash / Julia Koblitz
Zum Ersten war schon lange vor Galilei entdeckt worden, dass die Erde sich um die Sonne drehe und nicht umgekehrt. «Galilei war noch gar nicht geboren, da verbreitete sich die neue Lehre des Kopernikus schon durch alle Universitäten der katholischen Welt. An der spanischen Universität Salamanca wurde Astronomie seit 1561 parallel nach Ptolemäus und nach Kopernikus gelehrt. Damit die Studenten vergleichen konnten.» ( https://www. welt.de/kultur/history/article1564612/Warum-die-Inquisition-im-Fall-Galilei-Recht-hatte.html ) History changer
Unser drittes Thema führt uns zu Galileo Galilei. Dieser muss leider vielfach zu Unrecht als Kronzeuge dafür herhalten, dass die Bibel das Werkzeug gewesen sei, um die moderne Wissenschaft zu blockieren. Es stimmt natürlich, dass es einen Konflikt zwischen ihm und der katholischen Kirche gab. Doch dieser war ganz anders als die meisten Leute es sich vorstellen. «Als Märtyrer im Dienste des wissenschaftlichen Fortschritts ist Galileo Galilei in die Geschichte eingegangen. Eine schöne Vorstellung. Sie hat nur ein Problem: Sie stimmt nicht.» ( https://www.welt.de/kultur/history/article12829542/Derberuehmte-Satz-den-Galilei-nie-sagte.html )
Zum Zweiten waren die Probleme Galileis weniger wissenschaftlicher als persönlicher Art. In einer Schrift hatte er z. Bsp. den Papst beleidigt, indem er ihm die Argumente eines «Einfaltspinsels» in den Mund legte. Ganz Rom spottete über Galilei wegen seiner exzentrischen Persönlichkeit. So behauptete er etwa, das Fernrohr erfunden zu haben, das es doch schon vor ihm gab. Tatsächlich hat Galilei es nur weiter entwickelt. Beachte, dass er gar nicht zu einer richtigen Strafe, sondern zu Hausarrest verurteilt wurde. Er war keineswegs ein Märtyrer und schon gar nicht ein atheistischer. Der im Wesentlichen zwischenmenschliche Konflikt zwischen Galilei und seinen römischen Freunden soll nun also das Kronbeispiel dafür sein, dass das Christentum versuchte, die moderne Wissenschaft zu boykottieren! Nicht im Ernst? Wenn diese Behauptung wirklich wahr wäre, hätte man dann nicht mit Leichtigkeit bessere Beispiele für eine derart wichtige, geschichtsträchtige Folgerung finden können?
Übrigens ging es bei dem Prozess gar nicht eigentlich um die Bibel, die kaum etwas zum Thema enthält. In Wirklichkeit ging es um Aristoteles. Dieser - nicht die Bibel - hatte nämlich klar behauptet, dass die Sonne sich um die Erde drehe. Tatsächlich war es ausgerechnet die Verehrung der griechischen Philosophen, welches das mittelalterliche Europa lähmte. Erst die Befreiung vom sklavischen Respekt gegenüber unbewiesenen Behauptungen der alten Griechen führte zu wissenschaftlicher Weiterentwicklung. Und diese begann ziemlich genau mit der «Royal Society of London for Improving Natural Knowledge», ab 1662, deren Mitglieder sich erstmals wagten, Aristoteles öffentlich Irrtümer nachzuweisen.
Robert Boyle, Isaac Newton und die anderen frühen Mitglieder dieser Society waren gläubige Christen. Praktisch alle Wissenschaftler der ersten Generationen waren ausdrücklich christlich oder doch wenigstens im gleichen Weltbild verwurzelt. Sie erkannten, weshalb die Wissenschaft seit Jahrtausenden keine Fortschritte gemacht hatte. Weil sie nämlich hauptsächlich auf philosophischen Gedankengebäuden und Respekt, anstatt auf empirische Erfahrung gegründet war.
Vor den Europäern hätten theoretisch bereits die Araber die Chance gehabt, das griechische Wissen weiter zu entwickeln. In der extremen Ehrenkultur des Islam hatten aber wissenschaftliche Neuerungen in der Praxis wenig Chancen, allgemein umgesetzt zu werden, da sie als Bedrohung für
das Vorbild des arabischen Propheten gesehen wurden. Solange Europa nur oberflächlich christianisiert war, herrschte auch hier eine sumpfige Ehrenkultur, die jeden wissenschaftlichen Fortschritt verschluckte. Doch die Evangelien zeigen einen revolutionären Jesus, der gegen blinde Gebote antritt und ein völlig Neues Denken in die Welt pflanzt. Als kompromissloser Kämpfer gegen die Ehrenkultur bis zum bitteren Tod hat Jesus letztlich die Türen für den Fortschritt geöffnet.
Für wissenschaftlichen Fortschritt braucht es mehr als nur einen Forscher. Es benötigt auch die Möglichkeit, neue Entdeckungen aufzuschreiben, zu kopieren, über lange Zeit zu bewahren, zu lehren und anzuwenden. All das war nicht zuletzt in Klöstern ideal machbar. Dort konnte über Jahrhunderte an ungelösten Fragen weiter gearbeitet werden. Tatsächlich waren die ersten europäischen Universitäten alle aus Klöstern entstanden.
Natürlich gab es auch in der Kirche wie überall konservative Kreise, welche den Fortschritt zu hindern versuchen. Aber wer aus Einzelbeispielen das Bild kreiert, als ob die europäische Wissenschaft gegen den Willen der Kirche entstanden sei, stellt die Wahrheit auf den Kopf. Ohne die Bibel hätte es diese unglaublichen wissenschaftlichen Entwicklungen nie gegeben. Wir würden wohl bis heute noch nicht viel anders leben als die alten Germanen. Es gäbe weder Auto noch Druckmaschinen oder Flugzeuge.
Zudem müssen wir uns bewusst sein, dass die Kirche absolut die Möglichkeit gehabt hätte, den wissenschaftlichen Fortschritt zu verbieten und die Forscher flächendeckend zu verfolgen, wenn sie es denn wirklich gewollt hätte. Doch das Einzigartige an der Geschichte Europas ist, dass sich hier im Gegensatz zu anderen Kontinenten die Religion aufs Ganze gesehen nicht als Hinderer, sondern als Wiege des wissenschaftlichen Fortschritts entpuppte.
Zwar war es den alten Chinesen, Ägyptern, Griechen, Römern und Arabern schon lange zuvor gelungen, mitunter erstaunliche Entdeckungen zu machen, bzw. zeitweise Hochkulturen zu errichten. Trotzdem gelang keinem dieser Völker ein bleibender Durchbruch. Im Gegenteil: Das meiste Wissen ging im Laufe der Zeit wieder verloren. In Europa geschah dagegen eine phänomenale wissenschaftliche Revolution, und die Grundlage dazu wurde ausgerechnet im vermeintlich finsteren und vielfach verachteten Mittelalter gelegt.
In der Tat hätte es sehr wohl sein können, dass der Durchbruch nie geschehen wäre, denn dafür müssen mindestens neun Bedingungen erfüllt sein. Es genügt ja nicht, wissenschaftliche Erkenntnisse zu machen (1). Das Wissen muss irgendwo gesammelt (2), über lange Zeit geschützt und bewahrt (3) werden. Auch das ist noch zu wenig. Es müssen laufend neue Erkenntnisse (4) erarbeitet werden. Dies allerdings ist nur möglich, wenn die vorherrschende Kultur es erlaubt (5). Doch die Zivilisationen des Altertums waren grösstenteils Ehrenkulturen, die allem Neuartigen prinzipiell ablehnend gegenüber stehen.
In Europa dagegen begannen manche Klöster schon früh, Bibliotheken und Schulen anzulegen. Sie wurden Zentren der Gelehrsamkeit und alle frühen Universitäten entwickelten sich daraus. Es gibt nichts prinzipiell Wissenschaftsfeindliches am biblischen Glauben (6). Die meisten Völker entwickelten allerdings schon alleine deswegen keine Wissenschaft, weil sie die Aktivitäten der Natur Geistern zuschrieben. Das, was sie unter Wissenschaft verstanden, waren also grossenteils Regeln und Tipps für den Umgang mit Dämonen bzw. Aberglaube. Der Glaube an den Sieg des Messias über die Dämonen befreite aber die Europäer vom grössten Hindernis, welches andere Völker daran hinderte, die Natur zu erforschen: Die Angst vor der Rache der Geister (7)!
Griechen, Chinesen und Ägypter verloren schliesslich ihr Interesse an der Naturwissenschaft. Der Grund, weshalb es dort nie zu einer vollen Entwicklung der Wissenschaften kam, war nicht zuletzt die fehlende Erwartungshaltung. Sie erwarteten gar nicht, dass es allgemein gültige Naturgesetze und einen Code zu deren Entschlüsselung geben könnte. Woher sollten sie auch diese Idee nehmen? Sie glaubten ja, dass es viele Götter gebe, die im Widerstreit miteinander standen. Die Bibel dagegen lehrte einen einzigen Gott, der explizit als Schöpfergott dargestellt wird, und die Natur durch seine Worte erschaffen habe. Worte aber unterstehen Gesetzmässigkeiten und sind letztlich ein Code. Hier war die Einladung zur Erforschung der Natur (8).
In den Evangelien tritt Jesus auf jeder Seite als radikaler Gegner der Ehrenkultur auf. Weil er die Ehre der Hochgeachteten verletzt hat, beschliessen diese, ihn am Kreuz den Ehrentod sterben zu lassen. Diese Feindschaft gegen das Ehrendenken benötigt es, um das Nachplappern der vermeint-
lichen Weisheiten früherer Generationen zu hinterfragen und echtes Forschen zu ermöglichen. Im Laufe der Jahrhunderte wirkte sich die Haltung des Messias auf die Europäer aus (9).
Jede dieser neun Bedingungen, die es zum wissenschaftlichen Durchbruch unbedingt benötigte, waren also in Europa - und die Meisten nur hier - vorhanden, weil sie direkt oder indirekt durch die Bibel geschaffen wurden.
1) Zu Ehrenkultur siehe Kapitel 2.2a
2) Über das Thema «Ehrenkultur und Wissenschaft» werden wir in Kapitel 2.2. noch detaillierter sprechen.
3) Larry Siedentop, «Inventing the Individual» S. 51ff, Harvard University Press
4) ebenda S. 165ff
5) https://www.grin.com/document/281013: «Die Abschaffung der Sklaverei erfolgte in europäischen Ländern, wie Frankreich, aufgrund des christlichen Gebots, dass alle Menschen gleich sind. Gleichzeitig betrieben jedoch genau diese Länder den Sklavenhandel außerhalb Europas.»
6) ebenda: «Tatsächlich war Montesquieu der einzige unter den französischen Aufklärern, der bei der Bezeichnung der Schwarzen nicht von einer anderen `Rasse` von Menschen sprach, sondern einfach nur von Menschen»
7) https://www.mtsu.edu/first-amendment/article/1231/roger-williams
8) The Society for Effecting the Abolition of Slavery
9) Eine zentrale Rolle spielte die biblische Lehre, der Mensch sei im Bilde Gottes geschaffen und könne daher kein Sklave sein.

Aus dem Geschichtsunterricht erhielt ich den Eindruck, dass das Thema Sklaverei untrennbar mit der Geschichte Europas und der USA verknüpft sei. Doch später entdeckte ich, dass dies nur ein kleiner Teil dessen ist, was wirklich geschah. Tatsächlich gab es Sklaverei seit Urzeiten und zwar auf jedem Kontinent. «Sämtliche antiken Hochkulturen kannten die Sklaverei» (planet-wissen.de). Versklavt wurden Kriegsgefangene, Verbrecher und Verschuldete. Das erschien besser, als sie umzubringen.
Nirgends wurde die Sklaverei als Institution hinterfragt. Im Altertum verstanden sich die Menschen als klar definierten Teil eines Volkes sowie einer Familie, und hielten den vorgegebenen Platz im Grossen und Ganzen für unabänderlich. Erst das Christentum hinterfragte z.Z. der Urkirche diese Struktur erstmalig. In der Kirche sass plötzlich der Herr neben seinen Dienern auf derselben Bank und ass vom gleichen Abendmahl. Das war einer der Gründe, weshalb der christliche Glaube für viele Menschen so anziehend war im Römerreich. Genau dafür wurde das Christentum schon damals von seinen Gegnern verspottet, denn es liegt auf der Hand, dass es am Anfang vor allem Menschen niedrigen Standes anzog.
Dieser soziale Aspekt des christlichen Glaubens ging aber leider später bei der Christianisierung Europas grossteils verloren. Der Hauptgrund dafür ist, dass dort die Verbreitung des Christentums gerade umgekehrt geschah:
von oben herab. D.h. die meisten Europäer traten nicht aus persönlicher Überzeugung der Kirche bei, sondern weil es ihnen von ihren Königen bzw. vom Kaiser befohlen wurde. Deshalb wurde nicht nur die Sklaverei, sondern die ganze soziale Struktur der europäischen Völker so übernommen, wie sie schon zuvor im europäischen Heidentum existiert hatte.
Wir empfinden das Mittelalter als dunkel, weil damals ungerechte Strukturen vorherrschten. Diese hat aber nicht das Christentum eingeführt, sondern sie wurden von der heidnischen Kultur übernommen. Die Kirche hat es bei der oberflächlichen Christianisierung Europas verpasst, diese zu korrigieren. Das Mittelalter ist jedoch nicht nur dunkel, sondern im Gegenteil genau die Zeit, in der die Bibel langsam an Einfluss gewann und Einiges an Wertvollem nachgeholt wurde. Ausgerechnet im vermeintlich dunkeln Mittelalter wurde entdeckt, dass der Mensch nicht nur als Teil einer Gesellschaft, sondern auch als Individuum einen Wert hat. Wie wir bereits erwähnt haben, versuchte die kath. Kirche zeitweise die Feudalherren zu zwingen, all ihren Untertanen Mindestrechte zu gewähren. Schon hier wurde lange vor der Aufklärung die Grundlage für den modernen Individualismus gelegt. Fortan gab es in Europa keine rechtlosen Sklaven mehr. Die Kirche bemühte sich, sogar der untersten Schicht, den Leibeigenen, Grundrechte zu geben und dies war ein weltweites Novum. Die Begründung war absolut religiös: Dass man nämlich die Seele eines Menschen nicht kaufen könne, da diese Gott gehöre.
Doch leider wurde diese Erkenntnis nur innerhalb Europas angewandt. Als sich dem Westen Jahrhunderte später die Gelegenheit bot, schreckte er deshalb nicht zurück, in die weltweite Sklaverei einzusteigen. Nicht einmal die Aufklärer erkannten diesen Widerspruch.
Reine Profitgier war es, welche die europäischen Länder dazu führte, die Gesetze für die Grundrechte aller Menschen, welche sie zuhause anwendeten, auf anderen Kontinenten zu vergessen. Allerdings gab es immer wieder warnende Stimmen. Am einflussreichsten war der schon erwähnte englische Arzt John Locke, der bereits im 17. Jhd. drei grundlegende Menschenrechte aus der Bibel ableitete. Wenn jeder Mensch ein Recht auf Leben, auf Besitz und auf Meinungsfreiheit hat, dann kann es keine Sklaven mehr geben. Der von Locke beeinflusste Baptist Roger Williams gründete denn folgerichtig in Rhode Island den ersten Staat der Weltgeschichte, der das Verbot der Sklaverei gesetzlich verankerte, und zwar bereits 1652, mit ausdrücklich bibli-
scher Begründung. Es dauerte danach noch 150 Jahre bis der Sklavenhandel 1807 im gesamten britischen Kolonialreich verboten wurde.
Dieser Schritt war hauptsächlich der «Gesellschaft zur Abschaffung der Sklaverei» zu verdanken, welche 1787 von zwölf christlich motivierten Männern in London gegründet worden war. Die Engländer setzten sich in der Folge für ein weltweites Verbot der Sklaverei ein. Sie fingen sogar Sklavenschiffe anderer Länder ab und brachten sie zurück nach Afrika.
Nicht Christen haben also die Sklaverei erfunden, wohl aber abgeschafft, und das hat mit der Bibel zu tun, welche immer wieder betont, dass Gott das Schreien der Sklaven höre, wenn sie ungerecht behandelt werden, so wie es einst in Ägypten geschehen war. Zwar verbietet die Bibel Sklaverei nicht ausdrücklich, gab aber bereits zur Zeit Mose ungewöhnliche Rechte. So waren Menschenraub und Verkauf eines Menschen bei Todesstrafe untersagt (2.Mose 16:21). Sabbatruhe musste ihnen gegönnt werden, sowie ein Platz in der Synagoge. Wer einen Sklaven misshandelte, musste ihn dafür frei lassen (2.Mose 21:26). Ein davongelaufener Sklave durfte nicht zurückgeschickt, sondern musste geschützt werden. Gehörte er zum eigenen Volk, so musste er nach sechs Jahren mit Startgeld in ein neues Leben frei gelassen werden. Das Wort «Ebed» in der hebräischen Sprache bedeutet übrigens sowohl «Diener» als auch «Sklave».
Aber mehr als das. Die Bibel ehrt niemand so sehr wie Sklaven. Ausgerechnet der Sklave Josef wird schon im Ersten Teil der Thora als Retter der ganzen damaligen Welt und damit grössten Helden gefeiert. Ausgerechnet das Sklavenvolk Israel wird von Gott vor allen anderen Nationen erwählt, mehrmals befreit und sein Name quer über die ganze Menschheitsgeschichte geschrieben. Der Messias selber macht sich zum Sklaven seiner Jünger, indem er ihnen die Füsse wäscht und sich für sie opfert. Und seine Sympathien liegen eindeutig bei den Benachteiligten, Armen und Versklavten. Auch die Apostel nannten sich mit Begeisterung «Sklaven Jesu Christi».
Heute ist die Sklaverei dank der Bibel weltweit verboten. Es gibt sie aber doch in vielerlei Form (10). Denn das wirkliche Problem liegt nicht in der Religion, sondern im egoistischen, profitgierigen Herzen des Menschen.
10) https://www.humanrights.ch/de/ipf/archiv/international/nachrichten/moderne-formen-sklaverei

Quelle: pexels / Alejandro Quintanar
«Selbstverständlich glaubt jeder aufgeklärte Mensch an die Evolution.» Diesem Satz würden sehr viele Europäer zustimmen, ohne lange zu überlegen. Doch wer die Sache durchdenkt, muss stutzig werden. Tatsächlich lehrt die Aufklärung doch eigentlich das genaue Gegenteil der Evolution. Die Aufklärung ging davon aus, dass alle Menschen gleichwertig seien; die Evolution dagegen lehrt, dass die meisten Lebewesen Ausschussmaterial seien und nur die Stärksten überleben. Woher kriegen wir dann gleiche Rechte, wenn die Schwächeren nur wertloser Abfall sind?
Auch wenn die meisten Menschen nie darüber nachgedacht haben, muss ein ehrlicher Mensch den Tatsachen ins Auge blicken. Die moralischen Folgen der Evolutionslehre sind total anders als alles, wofür die Aufklärer kämpften. Denn sie lehrt, dass es nicht nur minderwertige Menschen, sondern auch Völker gebe. Dank der Evolutionslehre fiel es den Nationalsozialisten leicht, die Vernichtung gewisser Ethnien zu begründen. Diese seien ja im Vergleich zu den sog. Ariern weniger hoch entwickelt. Deshalb sei es ein Gewinn für die Welt, wenn sie möglichst schnell ausgerottet würden.
Auf die Evolutionstheorie stützt auch der per Definition atheistische Kommunismus seinen Klassenkampf. Die Kapitalisten und religiösen «Elemente» gelten als unterentwickelt und müssten daher ausgelöscht werden. Da atheistisch argumentiert wird, gibt es keine Gewissensbisse, diese «Zufallsprodukte der Natur» zu Millionen auszurotten. Keine andere politische Lehre, keine Philosophie oder Religion hat es je fertig gebracht, in so kurzer Zeit so viele Menschen zu töten, wie der Kommunismus im letzten Jahrhundert.
Mit der Evolution wird auch die moderne Abtreibung von Millionen von Babies im Mutterleib begründet und versucht, das Gewissen der Mütter und Väter zu beruhigen. Es seien ja nur Zellklumpen, keine Lebewesen. Doch womit will man dann nach Darwin die Menschenwürde überhaupt noch begründen? Sind wir gemäss seiner Lehre nicht alle letztlich nur Zellklumpen? Warum sollten wir mehr Rechte haben als Tiere, wenn wir denn wirklich aus ihnen stammen? Warum sollten wir Behinderte nicht wieder umbringen, wie es im Altertum geschah? Warum sollten die Intelligenten und Arbeitsamen nicht mehr Rechte kriegen als die Faulen und Dummen? Warum soll der Mann nicht über die Frau herrschen, wenn er doch körperlich stärker ist und sie leicht besiegen kann?
Ja, wenn wir denn wirklich nur Tiere sind, dann ändert das sehr viel an unserem Denken! Und das wird langfristig auch in die Tat umgesetzt werden, denn die Aufklärung hat sich zwar für die Gleichberechtigung des Menschen stark gemacht. Doch ehrlich gesagt, hatte sie gar keine plausible Begründung dafür. Das war ihre Schwäche, denn objektiv gesehen sind die Menschen tatsächlich keineswegs gleich. Es ist zu befürchten, dass die vom Evolutionsdenken geprägte Menschheit irgendeinmal nicht mehr bereit sein wird, altersschwache, Behinderte und kranke Menschen durchzutragen. Dann werden wir alles Gute, welches das Christentum und die Aufklärung gebracht haben, wieder verlieren.
Okay, Sie und ich, wir sind keine Naturwissenschaftler. Wir können der Wissenschaft nicht vorschreiben, was sie zu entdecken hat. Aber wir wissen auch, dass damals, als die Evolution geschehen sein soll, keine Menschen gelebt haben, die das wirkliche Geschehen dokumentiert hätten, und es sich bei all diesen Theorien immer um Vermutungen handelt. Vor allem müssen wir endlich auch Rechenschaft darüber ablegen, was die Folgen
einer derartigen Lehre sind, denn wir und unsere Kinder müssen ja früher oder später den Preis dafür bezahlen, dass wir uns jeglicher Argumente gegen grenzenlosen Egoismus berauben. Wenn die Menschen Tiere sind, dann gibt es keinen Grund, weshalb sie sich nicht wie solche verhalten sollten. Wir haben dann keine Berechtigung zu sagen, dass Kriege und Morde falsch sind, denn im Tierreich frisst nun mal der Stärkere den Schwächeren. Da kann man nicht sagen, dass dies böse sei. Moral gibt es dann nicht mehr. Weder allgemeine Menschenrechte, noch Demokratie und Gewaltentrennung, noch Sozialstaat, noch Ehrlichkeit und Fairness machen dann überhaupt noch Sinn.
Doch wieso gelang es dann den Aufklärern vor 300 Jahren, die Europäer davon zu überzeugen, dass die Menschen alle gleichberechtigt seien, obwohl sie doch selber eigentlich gar keine wirkliche Begründung hatten? Weil damals Europa ziemlich einheitlich von gewissen christlichen Ideen geprägt war, insbesondere, dass die meisten Menschen glaubten, wir seien im Bilde Gottes geschaffen. Aus genau diesem Grunde wurde ja später auch die Sklaverei bekämpft und verboten, wie wir schon gesehen haben. Keinem Volk, keiner Kultur und keiner Religion ausser der biblischen ist es je in den Sinn gekommen, die Menschen müssten gleichwertig behandelt werden, denn wir sind ja offensichtlich in vieler Hinsicht ungleich. Dass Gott uns in seinem Bilde erschaffen habe, Jesus sich um die Schwachen und Ausgestossenen gekümmert habe und für alle Menschen gestorben sei, das sind bis heute die einzigen Lehren, die wirklich die Gleichberechtigung des Menschen nicht nur behaupten, sondern auch die Motivation dazu geben, die Opfer zu bringen, welche es benötigt, um diese zu verwirklichen und dem angeborenen Egoismus des Menschen wirksam entgegen zu treten. Und wenn diese grossartigen Lehren durch evolutionäres Denken ersetzt werden, dann brechen die ganzen Errungenschaften der Aufklärer eines Tages wie ein Kartenhaus zusammen, und nichts wird uns davor retten, wieder zu leben wie unsere Vorfahren vor Tausenden von Jahren. Oder noch schlimmer, denn inzwischen gibt es ja Waffen, um die Erde vielfach zu vernichten.

In den Werken der Aufklärer geht es um Gerechtigkeit. Früheren Generationen erschien es als vernünftig, dass beispielsweise der Sohn eines Bauern nicht die Tochter eines Königs heiraten darf. Gerade derartige Tabus wurden durch die Aufklärer in Frage gestellt. Warum sollte es privilegierte und benachteiligte Schichten geben? Weshalb sollte der Erstgeborene alles erben und seine Brüder ihr Leben lang von ihm abhängig sein? Warum sollte die Tochter fast nichts erben, während der Sohn viel zu viel erhielt?
Alle diese Änderungen versuchten die sogenannten Aufklärer nicht mit der Religion, sondern mit der Vernunft zu begründen. Dabei kamen sie allerdings zu ziemlich unterschiedlichen Schlussfolgerungen. Klar, was wir als vernünftig empfinden, ist von vielem abhängig. Was dem Einen als folgerichtig erscheint, tönt in den Ohren eines Anderen wie Unsinn. Der Mensch sieht die Welt aus seiner Perspektive, und das ist notgedrungen viel relativer, als die Meisten sich bewusst sind. Dieses Problem fasste der letzte Aufklärer Emmanuel Kant in seinem spektakulären Werk «Kritik der reinen Vernunft». zusammen. Darin zeigte er, dass der Versuch, mit menschlicher Vernunft absolute Standards zu finden, fehlgeschlagen war.
Tatsächlich muss man objektiv gesehen sogar zugeben, dass die Forderung nach Gleichheit für alle Menschen nicht unbedingt logisch ist, denn eigentlich sind die Unterschiede zwischen uns doch frappierend gross. Auch wenn alle Menschen gleiche Rechte erhalten, ist das letztlich z.B. aus der Sicht eines Behinderten wiederum nicht unbedingt gerecht. Er benötigt mehr Rechte, um gleich leben zu können wie seine Nachbarn. In der gesamten Menschheitsgeschichte hatte es eine derartige Forderung nach konsequenter Gleichberechtigung nie zuvor gegeben. Woher hatten denn die Aufklärer ihr Anliegen, das bis heute in den meisten aussereuropäischen Kulturen nach wie vor wenig Akzeptanz findet?
Tatsächlich entstand die Aufklärung nicht zufällig. Sie war die Fortsetzung einer europäischen Entwicklung, die schon lange zuvor begonnen hatte. Wie wir schon beobachtet haben, wurde der fruchtbare Same schon im Mittelalter gesät, u.a. dadurch, dass die katholische Kirche in langer Arbeit das ererbte römische Gesetz überarbeitete, und sich dafür einsetzte, dass gewisse Grundrechte für alle Europäer gelten sollen, auch für die untersten Schichten. Das war ein Schritt. Doch eigentlich spricht die Bibel von mehr als nur «einigen Grundrechten». Wer A sagt, muss auch B sagen. Wenn es denn wirklich so ist, dass Gott ALLE Menschen in Seinem Bilde erschuf, und Jesus am Kreuz nicht nur die oberen Zehntausend, sondern sogar den Mörder erlöste, der am anderen Kreuz hing, dann ist damit gesagt, dass aus Gottes Sicht alle Menschen als gleich wertvoll gelten. Jahrhundertelang hing dieser Gedanke in der Luft. Die möglichen Konsequenzen dieser phänomenalen Idee wurden zuerst zaghaft, dann mutiger, immer vielfältiger und schliesslich völlig übertrieben und chaotisch nach Europa hinein kommuniziert.
Doch aufgepasst. Lassen wir uns kein A für ein B vormachen. Dieser Gerechtigkeitsstandard kam historisch nachweisbar aus der Bibel. Der Grund, weshalb die Aufklärer dies als vernünftig empfanden, war nicht, dass es nicht auch anders denkbar wäre, sondern dass sie Kinder ihrer Zeit waren. Keiner von ihnen hat die Idee der Gleichheit selber erfunden. Die Aufklärung (A) ist also in Wirklichkeit eine Umsetzung von Ideen, welche durch die Bibel (B) nach Europa kamen. Einige von ihnen sagten das offen, andere indirekt, aber den Meisten war es offenbar selbst nicht bewusst. Im Gegenteil, sie sahen sich der Bibel hoch überlegen. Doch die Loslösung dieser Standards von der Bibel war folgenreicher und gefährlicher als sie sich je geträumt hätten. Damit verloren sie sich nicht nur im Relativismus, sondern öffneten auch der Gewalt Tür und Tor. Tatsächlich riefen viele Aufklärer im Gegensatz
zu Jesus zur Gewalt auf, um die geforderte Gerechtigkeit herzustellen. Dieser Aufruf entlud sich schliesslich in der französischen Revolution. Bis heute wird jenes problematische Ereignis leider oft glorifiziert. In Wirklichkeit führte diese Revolution keineswegs zu «Freiheit, Gleichheit und Brüderlichkeit», sondern zu einer furchtbaren Schlächterei von Tausenden und Abertausenden. Auch die völlig sinnlosen napoleonischen Kriege, welche 5,5 Millionen Menschenleben kosteten, sind letztlich eine Folge dieses Wahnes, mit Gewalt Gerechtigkeit schaffen zu müssen und zu dürfen. Eine Spätfolge der Aufklärung ist unzweifelhaft auch der Kommunismus mit seinem hemmungslosen Atheismus, der bis zu einhundert Millionen Tote forderte. Nun zeigte sich, wie recht Kant mit seiner Warnung hatte, dass es nämlich keine allgemein einleuchtende Vernunft gebe. «Die Revolution frisst ihre eigenen Kinder». Die Idee, dass Gerechtigkeit durch Gewalt hergestellt werden könne, brachte Europa seither immer wieder zum Brodeln. Die «Aufklärung» hatte also keineswegs nur schöne Auswirkungen. Einerseits muss man den «Aufklärern» zugute halten, dass sie sicher viel dazu beitrugen, die biblischen Standards von Gerechtigkeit in Europa doch noch umzusetzen, nachdem dies bei der oberflächlichen Christianisierung mehr als eintausend Jahre zuvor verpasst worden war. Andererseits hat die «Aufklärung» aber auch viel Negatives gebracht. So etwa auch sehr viel an Stolz und Einbildung. Während die grundlegende Idee jener Philosophen eigentlich von den biblischen Gerechtigkeitsstandards lebte, begann man ausgerechnet in jener Zeit, die Bibel zu verachten. Der Wahn, dass die menschliche Vernunft besser sei als die göttliche, begann damals. Wir leiden bis heute an diesem Wahn, obwohl er zu den grössten Katastrophen der Menschheit geführt hat.
Die sogenannte Aufklärung war im Grund der Dinge eine Befreiungsbewegung der Benachteiligten gegen die herrschenden Systeme und deren pseudochristlichen Argumente. Diese Kritik war aus biblischer Sicht nicht nur berechtigt, sondern sogar notwendig. denn man findet in ihr weder die Idee der «Staatskirche» noch eine Legitimation von «christlichen Königen», noch dass Priester eine höhere Klasse wären als die Durchschnittsmenschen. Ganz im Gegenteil: Jesus sandte seine Jünger zum Dienen, nicht zum Herrschen. So ist denn auch die einzige Regierungsform, bei welcher die Politiker dem Volk dienen, anstatt zu herrschen, die Demokratie, vom Aufklärer John Locke gemäss seinen eigenen Worten direkt aus der Bibel hergeleitet worden.
Aus dem Kampf der Aufklärung gegen Missstände hätte also keineswegs eine prinzipiell antichristliche Bewegung werden müssen. Dennoch wurde schliesslich das Kind mit dem Badewasser ausgeschüttet. Anstatt die grundlegende Rolle der Bibel bei der erstaunlichen Entwicklung Europas anzuerkennen, warf man alles Christliche mit dem Pseudochristlichen in den gleichen Topf. Die Forderung nach Gleichberechtigung führte nicht nur zur Verleugnung der einzigartigen Rolle der Bibel, sondern sogar dazu, dass man gewaltsam alle Religionen für gleichwertig erklärte, denn - so die Logik, die dahinter steht - wenn schon alle Menschen gleichwertig sind, so müssen auch alle Religionen gleich sein. Doch das ist natürlich Unsinn. Das führt nur dazu, dass man keine dieser Religionen ernst nimmt, sondern ihnen eine vorgefasste Meinung überstülpt.
Diese verdrehte Sicht zeigt sich etwa in der Ringparabel G. E. Lessings, die Gott mit einem König vergleicht, welcher am Ende seines Lebens einem seiner drei Söhne seinen vererbbaren Ring mit geheimen Kräften geben soll. Da er sie alle liebt, kann er sich nicht entscheiden. So lässt er schliesslich zwei Ringe nachmachen, damit der echte Ring gar nicht mehr erkennbar sei. Durch dieses Gleichnis sollte die Gleichheit aller Religionen gelehrt werden. Die drei Ringe symbolisieren bei Lessing nämlich das Judentum, den Islam und das Christentum.
Doch die Ringparabel widerlegt sich selber. Sie lehrt eigentlich einen grossen Betrug. Davon ausgehend, dass es einen echten Ring gibt, der Wohlstand, Frieden und Glück bringt, zeigt sie einen Vater, der zwei seiner Söhne aus falsch verstandener Liebe betrügt. Mit der Zeit wird sich zeigen, wer den wahren Ring hat und wer nicht. Wenn wir aber nicht nur Gott als Betrüger darstellen, sondern Betrug sogar propagieren müssen, um die Forderung nach Gleichwertigkeit umzusetzen, dann verlieren wir erst recht jede Chance, allgemeine Moral zu begründen.
Entgegen dem heutigen allgemeinen Verständnis erkennt der sorgfältige Historiker, dass in Wirklichkeit gerade die Aufklärung den einzigartigen Wert der Bibel zeigt, welche die Idee der Gleichberechtigung ursprünglich erfunden hatte. Wenn der Islam Europa erobert hätte, so wäre die Gleichheit aller Menschen unmöglich zum Thema geworden. Die Aufklärung und alles, was ihr folgte, wäre dann nie geschehen, denn im islamischen
Schariagesetz wird in aller Deutlichkeit die Ungleichheit der Menschen für alle Ewigkeit zementiert. Der Ehrbare steht dort eindeutig über dem Schandbeladenen, der Mann über der Frau, der Muslim über dem Juden und Christen, diese wiederum über den Heiden. Es gäbe heute in Europa weder allgemeine Menschenrechte noch Demokratie, noch Gewaltentrennung, noch allgemeinen Wohlstand.
Hätten sich unsere christlichen Vorfahren wirklich an die Lehren von Jesus gehalten, so würde die Geschichte Europas viel schöner aussehen. Trotzdem hat der Einfluss der Bibel auf unserem Kontinent einzigartige Entwicklungen wie die sogenannte Aufklärung hervorgerufen. Leider haben die meisten «Aufklärer» den Fehler der Namenschristen wiederholt, welche sie bekämpften: Auch sie weigerten sich, die Evangelien zu ehren, von denen ihre Bewegung ursprünglich in Gang gebracht worden waren. Sie krönten ihre eigene begrenzte Vernunft zum Gott und begründeten eine Feindschaft gegen die Bibel, die leider bis heute allzu viele gedankenlose Nachfolger findet.

Individualismus ist das Kennzeichen der modernen Welt. Heutige Kinder werden auf das Ziel hin erzogen, möglichst frei, selbständig und unabhängig zu werden. Ursprünglich war das nicht so. Da war das Ziel der Erziehung, die neue Generation auf ihren Platz in der Familie vorzubereiten. Es wäre gar niemandem in den Sinn gekommen, aus der Gesellschaft auszubrechen. Und falls es jemand trotzdem bewusst oder unbewusst versuchte, wurde er zur Rückkehr gezwungen oder sogar vernichtet. Damals war der Einzelne nicht frei. Er musste seine vorgeschriebene Rolle in Gesellschaft und Familie einnehmen, ob es ihm gefiel oder nicht. Diese war nicht nur dadurch definiert, dass er ein Junge oder ein Mädchen, son-
dern auch, dass er unter seinen Geschwistern der Erst- oder Letztgeborene war, ob er aus einer hochstehenden Sippe stammte oder nicht, ob seine Familie Land besitzt, oder ob sie einen gewissen Beruf ausüben. Ja sogar, ob sein Vater und Opa Erstgeborene waren oder nicht, konnte oder kann eine grosse Rolle spielen.
«Kann» sage ich bewusst, denn bis heute gibt es derartige Kulturen. Als ich einige Jahre im Nahen Osten verbrachte, staunte ich, dass zur Geburt eines Jungen gratuliert, zu derjenigen eines Mädchens dagegen getröstet wurde, weil man nicht das Individuum sah, sondern die Familie als Ganzes bzw. den Einzelnen nur als Teil der Gesellschaft wahrnahm. Viele Eltern behandelten ihren Erstgeborenen wie einen Fürsten, anders als die anderen Söhne. Nicht nur der Unterschied zwischen Mann und Frau, sondern überhaupt zwischen den Menschen wurde betont. Rassistische Aussagen erschreckten niemanden, sondern galten als selbstverständlich. Dies alles sind typische Merkmale von sogenannten Ehrenkulturen. Der Respekt für gewisse Personen und die Verachtung für andere durchdringen dabei das Denken der betreffenden Völker in jeder Hinsicht. So findet man häufig in Stammesreligionen die Überzeugung, dass es die Pflicht und das Recht des Ältesten sei, den Kontakt mit den Verstorbenen bzw. den Göttern aufrecht zu erhalten. Würde es dagegen jemand anderes tun, würde dies als ein schlimmes Vergehen betrachtet werden, das schlimme Strafe nach sich ziehen muss.
Die alten Griechen brachten behinderte und schwächliche Babies oft schon bei der Geburt um. Das machte in ihrer Logik Sinn, weil es für sie nicht um den Einzelnen und seine Rechte ging, sondern nur die Gemeinschaft als Ganzes. Sie wollten vermeiden, dass das Volk geschwächt werde. In so einer Gesellschaft steht der Mann natürlicherweise über der Frau und der Krieger über dem Bauern. Die Völker des Altertums waren so sehr von diesem materialistischen Denken beherrscht, dass sie ihm sogar die Religion unterordneten. Die Götter waren da, um das Volk zum Erfolg zu bringen. Der Glaube ist in so einer Gesellschaft nicht Privatsache, sondern Pflicht. Wenn nämlich die Götter vernachlässigt oder zum Zorn gereizt werden, kann dies den Untergang der Sippe oder gar der Stadt bedeuten. Im brutalen Überlebenskampf der Grossfamilien gehen die Rechte des Einzelnen völlig unter. Das Individuum war eben noch nicht erfunden.
Auch in der Bibel finden wir anfangs die Kultur, welche den Einzelnen und seine Bedürfnisse gar nicht sieht. Da gibt es Situationen, die uns nur
Kopfschütteln abverlangen. So etwa, wenn Abraham seine Frau Sarah dem Pharao hingibt (und er und sogar sein Sohn Ähnliches später sogar noch wiederholen), um sein eigenes Leben zu retten, oder wenn Lot seine zwei Töchter den Männern von Sodom zur sexuellen Ausbeutung zur Verfügung stellen will, um seine Gäste zu schützen. Alle akzeptieren dies scheinbar ohne Wimpernzucken. Es wird offenbar als selbstverständlich angenommen, dass der für weniger ehrbar Geachtete sich in der Gemeinschaftskultur für den Ehrbaren opfern muss. Doch genau das wird in der Bibel dann immer mehr hinterfragt und schliesslich sogar total auf den Kopf gestellt. Den Höhepunkt finden wir dann am Kreuz, wenn Gott selber für seine Geschöpfe leidet. Alles, was das Altertum kennt, ist, dass Kreaturen für Götter geopfert werden. Doch in den Evangelien wird etwas ganz Neues, Gegenteiliges eingeführt. Und bleibt. In der christlichen Gemeinde wird regelmässig die Hingabe des Grösseren für den scheinbar Wertlosen gefeiert. Darüber staunt man, denn das hat es zuvor noch nie gegeben. Oberflächlich gesehen könnte man Jesus mit Sokrates vergleichen, der ja auch den Giftbecher trank und starb, obwohl er hätte fliehen können. Doch dessen Motiv war Stolz und nicht Selbstaufopferung für die unteren Schichten. Aus Athen geflohen, wäre er ein rechtloser Fremdling geworden, auf die Stufe eines Sklaven abgesunken. Er würde in diesem Rang auch den Respekt eines Philosophen verlieren. Ein Leben ohne Philosophie wäre für ihn aber sinnlos. Deshalb wählt er den Tod.
Ein anderes Phänomen der Ehrenkultur ist die Blutrache. Uns erscheint die Blutrache als völlig ungerecht. Denn dabei wird ja nicht der Mörder, sondern irgendjemand aus seiner Sippe getötet, der unschuldig ist. Wenn man aber als Grossfamilie denkt, hat das durchaus seine Logik. Denn das Ziel ist Abschreckung. Man tötet zwar nicht unbedingt den Mörder, sondern jemanden, der für die betroffene Sippe noch viel wertvoller ist. Damit hat man gezeigt, dass es sich nicht lohnt, gegen unsere Familie zu kämpfen.
Diese Art von Denken funktioniert aber eben nur, solange man das Individuum ausser Acht lässt. Zwang zur Ehe oder zur Religion, Ehrenmord, Blutrache, jede Art von Rassismus und vieles mehr wird innerhalb dieser Kultur als völlig normal bzw. sogar als ein Muss empfunden. Tatsächlich sind verschiedene Arten von Ehrenmord bis heute weltweit verbreitet.
Auch bei uns gab es früher Duelle und Familienfehden. Doch all dies wurde ausgerechnet in Europa hinterfragt.
Ein Beispiel: Im Islam gibt es ein Sprichwort: «Wer heiratet, hat die Hälfte seiner Religion erfüllt». Das bedeutet, es ist eine Pflicht, zu heiraten, Kinder zu zeugen, und damit die Grossfamilie zu stärken. Dass es vielleicht für mich besser oder sogar Gottes Plan sein könnte, ledig zu bleiben, ist undenkbar. Es geht ja gar nicht um mich. Ich bin da, um meine Pflicht zu erfüllen. Falls ich das nicht tue, werde ich als ein schlechter Mensch gesehen. Wer heiratet, und dann keine Kinder zeugen kann, gilt als Versager und muss sich sein Leben lang schämen. Doch was in diesem System zu kurz kommt, ist die Liebe.
Wenn wir nun diese Kultur mit dem Leben des Messias vergleichen, dann fällt der frappante Unterschied auf. Er selber heiratete nicht, denn er hatte Wichtigeres zu tun. Als er seine Jünger berief, mahnte er sie nicht zur Pflicht gegenüber ihrem Volk, sondern baute eine persönliche Beziehung mit ihnen auf. Die Einzelnen waren ihm wichtig, nicht nur um vorgeschriebene Erwartungen zu erfüllen, sondern als unterschiedliche Persönlichkeiten. Er kümmerte sich ganz besonders um Schwache, Ausgestossene und Verachtete. Keiner war für ihn wertlos. Auch nicht die Ehebrecherin, noch die Prostituierte, welche seine Füsse salbte, und erst recht nicht der Verbrecher, der neben ihm gekreuzigt wurde.
Während vielen Jahrhunderten war die Bibel das meistgelesene Buch in Europa. Zwar stimmt es, dass der Kontinent anfangs ziemlich oberflächlich christianisiert wurde, schon alleine nur deswegen, weil die meisten Menschen Analphabeten waren. Doch mit der Zeit wurde das nachgeholt. Nach der Reformation wurde Europa der Kontinent, der Volksschulen erfand. Jeder konnte lesen, und man las selbstverständlich die Bibel. Die Diktatur der patriarchalischen Gesellschaft wurde nicht zufällig zuerst in Europa gebrochen. Es ist der Bibel zu verdanken, in der regelmässig Schwache zu Helden gemacht werden.
Das Individuum wurde erfunden. Und das war der erste Schritt auf dem Weg zum Sozialstaat. Ohne diesen Schritt würden wir heute noch im Vormittelalter leben. Für eine fundiertere Beschreibung der Erfindung des Individuums und der gewaltigen Auswirkungen dieser Entdeckung siehe das Buch von Larry Siedentop «Inventing the Individual - The Origins of Western Liberalism», Penguin books, ISBN: 978-0-141-00954-4. (Link zum deutschen Buch hier anklicken)

Quelle: unsplash / seyed-amir-mohammad-tabatabaee
Heutzutage erscheint uns die Gleichberechtigung der Frau wie das Selbstverständlichste der Welt. Doch das ist längst nicht überall auf der Welt so, und dass es im Westen überhaupt so weit kommen konnte, wie es ist, ist eigentlich ein Wunder.
Wussten Sie, dass einst Millionen von Chinesinnen von klein auf ihre Füsse einbinden mussten, so dass sie verkrüppelten? Damit sollte garantiert werden, dass sie ihren Ehemännern nicht davon laufen und ihnen treu dienen. Wussten Sie, dass in Indien diejenigen Frauen der Kriegerkaste als Vorbilder galten und sogar vergöttert wurden, die sich beim Tod ihres Ehemannes freiwillig ins Feuer warfen und mit ihm starben? Falls sie sich aber weigerten, wurden sie ausgestossen und verachtet. Wissen Sie, dass es für Frauen in islamischen Ländern bis heute risikohaft sein kann, alleine aus dem Haus zu gehen, und dass sie für Ehebruch gesteinigt werden können, History changer
während Männer legal mit vier Frauen «und was eure rechte Hand besitzt», also mit Sklavinnen, (Sure 4:3-4) Umgang pflegen dürfen? Wussten Sie, dass es im Europa des Altertums nicht besser war? Gemäss der griechischen Mythologie wurde die Frau nämlich vom Göttervater Zeus zur Strafe für die Männer erschaffen. Er gab ihr zudem auch noch eine Dose namens Pandora mit. Als sie diese aus Neugier öffnete, sollen alle Übel dieser Welt heraus gekommen sein, voran Krankheit, Tod und Arbeit.
Kein Wunder, dass die noblen Griechen, zu denen sich auch die alten Philosophen zählten, Frauen verachteten. Sie stellten sie auf die gleiche Stufe wie Sklaven. Diesen überliessen sie die mühsamen Arbeiten. Und kein Wunder auch, dass Xanthippe, die Frau des Philosophenvaters Sokrates als Inbegriff des zänkischen «Weibes» in die europäische Literatur einging. Sie musste sich ja alleine um die Kinder kümmern. Er gab sich lieber mit seinen Philosophenjüngern ab als mit dem eigenen Nachwuchs. Sogar seine sexuelle Befriedigung suchte er bei ihnen.
Gemäss der griechischen Mythologie soll der Göttervater Zeus seine Ehefrau bei jeder Gelegenheit betrogen haben, und als sie ihn zur Rede stellte, schämte er sich keineswegs. Im Gegenteil, er beging ein noch grösseres Unrecht, indem er mit der Nichtsahnenden ein böses Spiel trieb und sie zum Schweigen brachte, indem er sie bei erster Gelegenheit verschluckte. Um unbemerkt näher an Frauen heranzukommen, soll er sich häufig sogar als ein Tier verstellt haben. Hätten sie gewusst, dass dies ein männlicher Gott ist, wären sie geflohen. Erst zu spät bemerkten sie, dass sie belogen wurden.
Universell zeigt sich im Altertum das gleiche Bild: Frauen wurden diskriminiert. Weil sie ganz einfach die Schwächeren waren. Es mag zwar immer wieder Völker gegeben haben, bei welchen Frauen das Sagen hatten. Es gibt sie bis heute. Zu den bekanntesten zählen die Mosuo in China, die Khasi in Indien und die Juchitán in Mexiko. Auch wenn diese Kulturen von Ethnologen oft idealisiert dargestellt werden, besteht allerdings kein Zweifel daran, dass es sich um Ausnahmen handelt, welche es schwer haben zu überleben und deren Kulturen sich nie gross verbreiten konnten. Die Gleichberechtigung der Frau, oder gar ihre Herrschaft im Matriarchat, sind gegen die Natur. Denn von Natur aus ist der Mann ganz einfach stärker. Die Frau ist vielmehr auf ihn angewiesen als umgekehrt, und er nützt ihre Schwäche aus, um sie zu beherrschen.
In den meisten Kulturen gibt es noch nicht einmal die Idee, dass die Frau gleichberechtigt mit dem Mann sein könnte. Doch woher kam dann die moderne Überzeugung, dass dies selbstverständlich sein müsste? Tatsächlich wurde diese Idee im Westen geboren und zwar nicht etwa in der Renaissance, welche ja nichts anderes als die Wiederbelebung der altgriechischen von Sklaverei und Ungleichheit geprägten Kultur war.
Ich zitiere aus dem Bericht eines Historikers: «Die meisten Amerikaner und Europäer haben keine Vorstellung davon, wie niedrig die Stellung der Frau, vor allem der Ehefrau, im antiken Griechenland war. Neugeborene Mädchen wurden auch in Rom häufig getötet oder ausgesetzt. Der römische Ehemann war zudem Herr über das Leben seiner Ehefrau, hatte das Recht zu jeglicher Züchtigung, und sogar, sie in die Knechtschaft zu verkaufen. (11) Es ist überliefert, dass Römer sich scheiden liessen, weil ihre Ehefrauen ohne Schleier ausgegangen waren. (12) Es waren die römischen Christen, die die Kindstötung und Aussetzung strikt ablehnten, und dies auch bei Mädchen. (13) Sie glaubten nämlich, dass Christus Männer und Frauen erlöst hatte. Der Soziologe Rodney Stark schätzt, dass vielleicht 2/3 der christlichen Gemeinschaft im zweiten Jahrhundert aus Frauen bestand, und dies in einer Gesellschaft, in der die Frauen in der Minderzahl gewesen sein sollen, weil man eben manche schon kurz nach der Geburt sterben liess.
Dies bedeutet, dass sich insbesondere Frauen der Kirche anschlossen. Tatsächlich tauchen in den frühesten christlichen Quellen überall Frauen auf. Sie wurden von der römischen Regierung verfolgt, sie beherbergten Kirchen in ihren Häusern, sie kümmerten sich um die Armen und Gefangenen, sie waren reisende Missionare und wohlhabende Gönner, die die Kirche finanziell unterstützten und vieles mehr. Offensichtlich stellte das Christentum einen Kontrast zum römischen Männlichkeitsideal dar. Celsus spottet deshalb: «[Christen können] nur die Törichten, Unehrenhaften und Dummen, nur Sklaven, Frauen und kleine Kinder überzeugen» (Cels. 3,44).
Im Gegensatz zur griechischen Religion ist die Frau im biblischen Schöpfungsbericht nicht eine Strafe für Adam, sondern ein Geschenk an ihn. Sie wird aus ihm selber gemacht, von seiner Seite, d.h. die Gleichheit wird betont. Gott selber bringt sie zu ihm wie ein Vater die Braut zur Hochzeit. Sie gilt zwar als diejenige, welche die Gebote Gottes zuerst übertritt. Er aber tut es ihr nach und steht damit als genauso schuldig da. Und ihr Wert
wird bald danach wieder durch die Erklärung gehoben, dass der kommende Erretter erstaunlicherweise als ein Nachkomme der Frau und nicht etwa des Mannes bezeichnet wird. (14)
Zwar lehrt die Bibel, dass der Mann das Haupt der Frau sein soll, doch nicht als brutaler Herrscher, sondern indem er sich für sie aufopfert, so wie es Jesus für die Gemeinde getan hat (Epheserbrief 5:23-25). Das war ein völlig neuartiges, revolutionäres Konzept, wie es die Welt noch nie gesehen hatte. Auch wenn es selbstverständlich auch da noch manch eine konservative Strömung und manch einen Missbrauch gab, so begann die Befreiung der Frau, wie sie im modernen Westen als normal gilt, unübersehbar und nicht zufällig in Europa.
Wie gesagt, waren im Mittelalter die meisten Europäer Analphabeten. Ihr christlicher Glaube war daher weitgehend bibelfern und eher kulturell. Trotzdem hat der Prozess bereits damals begonnen, dem schwächeren Geschlecht zu einer Stellung zu verhelfen, von der Frauen anderswo nur träumen konnten. Die Entschleierung; die Einehe; das Recht auf Leben; das Recht, alleine aus dem Haus zu gehen; dass die Kinder im Scheidungsfall nicht einfach automatisch weggenommen werden; Frauenrechte vor Gericht und beim Erben wurden bereits teilweise verwirklicht. Es war diese Grundlage - und keineswegs das altgriechische Vorbild - welche später zum Wunsch der völligen Gleichberechtigung führte. Erst danach wurden diese Frauenrechte in anderen Kontinenten verbreitet, wo sie vielerorts auch bis heute noch weit hinter dem westlichen Standard zurückgeblieben sind.
Wer die Geschichte studiert, stellt fest, dass die Idee der Befreiung der Frau also schon lange vor der Aufklärung gesät worden war. Die sogenannte Aufklärung im 18. Jhd. hat zwar in dieser Richtung einiges praktisch umgesetzt, kam aber viel zu spät, um grundlegend sein zu können. Auch Humanismus kann keineswegs die Wurzel der Frauenrechte sein, denn wenn der Mensch im Zentrum steht, dann beginnt auch der Konkurrenzkampf. Es «menschelt», und gerade dies ist ja die Wurzel der Unterdrückung der Schwachen. Gottlose Humanisten haben überhaupt keine Grundlage, um die Gleichberechtigung der Frau langfristig durchzusetzen, denn um Gott auszuschalten, sind sie ja gezwungen, an die Evolution zu glauben. Und bei Darwins Mechanismen geht es nicht nach hohen Idealen, sondern ganz brutal darum, wer der Stärkere ist. Die Schwächeren werden mitleidlos unter die Füsse getreten oder sogar ausgerottet.
Ja, Humanismus und «Aufklärung» spielten auch eine Rolle in der Befreiung der Frau. Aber nur, insofern sie sich gegen alle Logik christliche Ideale aneigneten. Gegen alle Logik betonen wir, denn die Humanisten gründeten ja auf altgriechischem Denken und die meisten «Aufklärer» verwarfen die Bibel. Doch die Befreiung der Frau ist ein Wunder, und sie wird langfristig nur überleben, wenn wir sie logisch begründen können. Und es ist nur die Bibel, welche lehrt, dass beide, Mann und Frau, von Gott genauso geliebt seien, und dass Jesus sein Leben für beide gegeben habe. Weil Humanisten keine ideologische Grundlage haben, stehen sie in Gefahr, im Chaos zu landen. Manche schiessen sogar weit über das Ziel der Gleichberechtigung hinaus und wollen Mann und Frau gleichschalten. Damit werden alle Teile überfordert. Die Bibel dagegen bleibt dabei, dass Mann und Frau verschiedene Rollen erfüllen, dass sie unterschiedlich seien und sein dürfen, dass sie aber gleich geliebt und darum auch gleichwertig und gleichberechtigt sind.
11) Siehe dazu Rudolph Sohm, Institutionen. Geschichte und System des römischen Privatrechts, München und Leipzig, Verlag Duncker & Humblot, 1920, S. 625
12) So der Römer Sulpicius Gallus. Siehe James Donaldson, Woman: Her Position and Influence in Ancient Greece and Rome, New York, Longmans, Green, 1907, S. 88
13) Siehe Charles Albert Savage, The Athenian Family: A Sociological and Legal Study, (Baltimore: o. Verlage, 1907), S. 29 und C.M. Bowra, Classical Greece (Chicago: Ime.Inc., 1965), S. 85; sowie W.F. Wright Feminist in Greek Literature: From Homer to Aristotle (Port Washington, N.Y.: Kennikat Press, 1969, S. 1; John Boswell, The Kindes of Strangers: The Abandonment of Children in Western Europe (New York: Pantheon Books, 1988), S.4; zitiert von Alvin J. Schmidt, Wie das Christentum die Welt veränderte, Resch Verlag, S. 113-115
14) 1. Mose 3:15

Gewisse Menschenrechte gab es immer - aber nur für die Oberschicht. Was so speziell ist an den modernen westlichen Menschenrechten, ist, dass sie für alle gelten. Aber leider auch heute nur in wenigen Ländern. Das erlebte ich z.B. in Ägypten, als einer unserer Freunde eines Tages einfach spurlos verschwand. Als sein Bruder nach ihm suchte, drohten ihm Polizisten, dass er genauso verschwinden könnte. In manchen Ländern gibt es also auch bis heute nicht einmal das Recht auf Leben. Der Bürger ist auf Gedeih und Verderben ausgeliefert.
Tatsächlich ist es weltweit gesehen eine kleine Minderheit, welche in echten Demokratien lebt und garantierte Menschenrechte geniesst. Kein Wunder, dass Millionen von Menschen genau in diese Länder migrieren. Hier hat sogar ein Fremder, der nie einen Cent in die Staatskasse bezahlt hat, das Recht, einen Asylantrag zu stellen und Monate oder gar Jahre von garantierter staatlicher Unterstützung zu leben. Er hat obendrein
das Recht auf einen Anwalt, der von ebendem Staat bezahlt wird, gegen dessen Asylentscheid er z.B. Rekurs macht. In anderen Teilen der Welt sind Migranten höchstens geduldet. Von Unterstützung können sie nur träumen. Wir hören Geschichten über Familien, welche sogar ihre eigenen Töchter verkaufen mussten, damit der Rest der Familie nicht verhungerte. Die Unterschiede könnten nicht krasser sein.
Schmiergeldaffären, Vetternwirtschaft oder andere Vergehen gegen allgemeine Menschenrechte können bei uns auch den erfolgreichsten Politiker seinen Job kosten. Das Paradebeispiel dazu ist Richard Nixon, der einst der Präsident der USA war und wegen einer Betrügerei gestürzt wurde. Ursprünglich war es ganz anders: Tatsächlich bestanden früher auch in Europa die Regierungen aus absoluten Herrschern, welche niemandem zur Rechenschaft verpflichtet waren.
Inzwischen wissen wir bereits, dass die Veränderung jedenfalls nicht aus dem alten Griechenland gekommen sein kann. Denn «Die Antike kannte keine Menschenrechte.» (https://www.netzwerk-menschenrechte.de/antike-und-die-idee-des-menschen-1148/). Tatsächlich wurde damals über allgemeine Menschenrechte höchstens philosophiert. Die Macht lag in den Händen der Erstgeborenen gewisser Familien, welche nicht nur Zweitgeborene, Bauern und Handwerker, sondern auch Frauen und Sklaven verachteten. Daran war nicht zu rütteln.
Die Renaissance erweckte das Erbe der römischen und griechischen Vorväter nach über tausend Jahren wieder zum Leben. Malerei, Bildhauerei, Literatur, Musik, Theater, Architektur, …. Viele Bereiche machten Fortschritte. Man überholte die Künste der alten Griechen sogar bei Weitem. Aber ausgerechnet im Bereich der Menschenrechte stellen wir keinen Fortschritt fest. Da diese im alten Griechenland kaum existent waren, spielten sie auch in der Renaissance keine Rolle.
Ganz im Gegenteil. Da die Renaissance den Menschen mit seinen Stärken ins Rampenlicht stellte, litt sie konsequenterweise aber auch an dessen Schwächen. Künste sind teuer und die Künstler hingen von den Finanzen der Auftraggeber ab. Jeder Fürst wollte den Anderen übertrumpfen. Politische Intrigen, Verrat und menschlicher Grössenwahn beherrschten die Szene. Der zunehmende Luxus der Fürsten und Bischöfe, ihre Parties, ihr Wettrennen und ihre Kriege gegeneinander wurden auf dem Rücken der
Bauern und unteren Schichten finanziert. Dies führte keineswegs zu einer Verbesserung der allgemeinen Menschenrechte, sondern zu noch grösserer Unterdrückung und Ausbeutung der einfachen Menschen.
Es stimmt, dass allgemeine Menschenrechte zuerst in Europa umgesetzt wurden. Aber weder die alten Griechen noch die Renaissance haben wesentlich dazu beigetragen. Wie erwähnt war Grundlegendes ab dem 11. Jahrhundert geleistet worden, als ausgerechnet im vermeintlich finsteren Mittelalter, lange vor der Renaissance, das römische Recht wieder ausgegraben, überarbeitet und der Versuch unternommen wurde, es auf die gesamte Bevölkerung anzuwenden. Damit war fast unbemerkt die Grundlage für die spätere einzigartige Entwicklung des Westens in Sachen Menschenrechte gelegt worden. Und dies ausdrücklich mit der christlichen Begründung, dass der Mensch eine Seele habe, welche Gott gehöre und deshalb nicht käuflich sei.
Als John Locke im 17. Jahrhundert für die drei ersten allgemeinen Menschenrechte (Recht auf Leben, Besitz und Meinungsfreiheit) warb, und diese sogar für alle Menschen proklamierte, befand er sich also nicht auf völligem Neuland. Allerdings zog er viel radikalere Konsequenzen als seine katholischen Vorgänger.
Er war keineswegs der Erste, der Menschenrechte proklamierte. Doch während Jahrhunderten blieben diese Ideen praktisch wirkungslos. Das Spezielle an John Locke war seine geniale Idee, wie allgemeine Menschenrechte auch in der Praxis umgesetzt werden können. Dazu kommen wir jetzt.

Quelle: pixabay
Es gab in alttestamentlichen Zeiten gewaltige Könige wie David und Salomo. Dadurch haben sich viele zur Vorstellung verführen lassen, dass es biblisch sei, Könige einzusetzen. Leider war es lange Zeit üblich, dass selbstsüchtige europäische Könige sich «christlich» nannten, und dem Volk vorlogen, sie seien «von Gottes Gnaden» eingesetzt. Doch wer die Bibel genau studiert, erlebt eine grosse Überraschung. Schon bevor der erste König eingesetzt wurde, steht klar geschrieben, dass Gott sein Volk vor irdischen Königen warnte. Denn diese würden sie bedrücken und ausnutzen. Gott wollte selber König über sein Volk sein. (15) Deshalb liess er das jüdische Königtum nach vierhundert Jahren auch wieder zu einem Ende kommen.
Was er dagegen einsetzte bzw. berief, waren Priester, Leviten, Propheten und Richter. Diese führten den jüdischen Königen auf unterschiedliche Arten immer wieder vor Augen, dass sie nicht absolute Herrscher, sondern nur Stellvertreter Gottes seien. Es gab Gesetze, an die sie sich halten sollten, und Grenzen, die sie nicht ungestraft überschreiten durften. Wenn sie ungerecht regierten, verloren sie die Unterstützung des Allmächtigen. History changer
Trotzdem führte die Königszeit nach vierhundert Jahren zur Katastrophe. Gerade wegen der Sünden der Könige verlor das jüdische Volk schliesslich sein Land und seinen Tempel. Immerhin kehrten einige von ihnen siebzig Jahre später hoffnungsvoll wieder zurück. Doch noch bis zur Zeit der Römer versuchten die Juden vergeblich, das Königtum wieder herzustellen. Ihr Aufstand kostete sie schliesslich über eine Million Menschenleben. Die Überlebenden wurden in alle Welt zerstreut mit der klaren Absicht, dass sie sich dort mit den anderen Völkern vermischen und ihre Identität verlieren sollten. Doch es kam bekanntlich anders. Sie überlebten 2000 Jahre ohne Land, ohne Armee und Regierung. So ein Phänomen ist einzigartig in der Weltgeschichte. Wer hat sie beschützt? Ihr himmlischer König.
Gott selber hatte also dem jüdischen Königtum ein Ende gesetzt. Jesus war sich dessen voll bewusst und weigerte sich, als irdischer König eingesetzt zu werden. Er erklärte klar, dass sein Königreich nicht von dieser Welt sei. Trotzdem missbrauchten die Europäer das Christentum später aus Selbstsucht und verwandelten es in eine Religion, welche scheinbar Diktaturen legitimiert. Der uns bekannte englische Philosoph John Locke nannte sie alle «sesshafte Räuber». Er erklärte alle Regierungen für illegal, welche die allgemeinen Menschenrechte Recht auf Leben, Besitz und Meinungs- bzw. Religionsfreiheit nicht durchsetzten. Ja, er ging noch weiter: Die Regierungen aller Länder hätten keine andere Aufgabe, als dafür zu sorgen, dass alle Bürger zu ihrem Recht kämen. Ansonsten sei es Pflicht der Bürger, diese Regierungen zu stürzen und durch andere zu ersetzen.
Da keinem Menschen zu trauen sei (in Übereinstimmung mit der biblischen Lehre von der allgemeine Sündhaftigkeit der Menschen) müsse die Macht jedes Politikers beschränkt und seine Machtstellung auch zeitlich begrenzt werden, erklärten John Locke und seine Jünger. So wurden die Demokratie und die Gewaltentrennung zum Schutz der Menschenrechte erfunden. Dazu ist es nützlich, zu wissen, dass Locke als puritanischer Freikirchler zu einer verfolgten Minderheit gehörte. Beachte also, dass die entscheidenden Impulse zu Menschenrechten und Demokratie weder von den alten Griechen noch von der Renaissance, auch nicht von Atheisten, sondern von freikirchlich-aufklärerischer Seite her kam.
In Europa hatte eine derart radikale Lehre der Menschenrechte damals null Chancen. Die Anhänger des Aufklärers Locke mussten vor den vermeintlich «christlichen Königen» fliehen. Unter den frühen Einwanderern
Amerikas bildeten sie allerdings in einigen Staaten eine Mehrheit (Baptisten in Rhode Island und Quäker in Pennsylvania). Tatsächlich wurden dort von jenen Freikirchenleuten die weltweit ersten wirklichen Demokratien gegründet. Natürlich hatte es auch auf anderen Kontinenten früher schon immer wieder mal gütige Herrscher gegeben, welche gewisse Menschenrechte gewähren mochten, doch meistens wurden sie innerhalb kurzer Zeit wieder rückgängig gemacht. Nun aber wurden die Rechte für immer in der Verfassung festgeschrieben. Erst von dort schwappten die Lockeschen Ideen später wieder auf Europa zurück.
Doch leider sind allgemeine Menschenrechte bis heute in den meisten Ländern immer noch eine Farce. Nur wer allen Menschen inkl. sich selbst misstraut, und andererseits doch jede einzelne Person als gleichwertig anerkennt, wird sich für das komplizierte System der Demokratie einsetzen, das die Macht jedes Politikers inkl. die eigene begrenzt. Die Demokratie hat sich vor allem dort etabliert, wo ein von der Bibel direkt oder indirekt beeinflusstes Menschenbild herrscht bzw. die Bereitschaft bestand, dieses anzunehmen.
Beachte also, dass die Demokratie noch vor wenigen hundert Jahren auch in Europa keine Chance hatte. Sie benötigt nicht nur die richtigen Strukturen, sondern auch ein Volk, das die Reife dazu hat. Die Voraussetzungen, die ich meine, haben wir schon in Kapitel 1A beschrieben. Wenn die Einwohner sich nicht um jeden Preis und entgegen dem egoistischen menschlichen Verlangen an die Regeln halten, funktioniert es nicht. Wir haben ja heute mehr als genug Scheindemokratien, die das zur Genüge illustrieren.
Die freikirchlichen Asylanten, welche damals in Rhode Island und Pennsylvania die Mehrheit der Bevölkerung ausmachten, hätten sehr wohl die europäischen Staatskirchen verbieten können, die ihnen so viel Leid zugefügt hatten. Es wäre durchaus verständlich, wenn sie Gegendiktaturen errichtet hätten, wie es tatsächlich in einigen von Europa abgefallenen Kolonien auch geschah. Doch jene Anhänger von staatlich unabhängigen Kirchen waren durch ihre guten Bibelkenntnisse und ihre Lebenserfahrungen als Verfolgte zur Genüge auf die Forderungen der Demokratie vorbereitet. Sie stimmten nicht nur zu, sondern hielten sich auch daran. Ihnen ist es zu verdanken, dass es heute überhaupt echte Demokratien gibt. Keineswegs den altgriechischen Stadtstaaten und auch nicht der französischen
Revolution, welche ja misslang. Denn sie führte gar keine Demokratie ein, sondern eine neue Diktatur. Weil die Franzosen die Idee der Demokratie noch gar nicht verstanden hatten, begannen sich verschiedene Interessengruppen gegenseitig zu bekämpfen und es entstanden nacheinander mehrere Diktaturen. Damals wurde der Spruch geprägt: «Die Revolution frisst ihre eigenen Kinder».
Leider hatten sich die europäischen Staatskirchen mit ungerechten Königtümern verbündet und beide sind schuldig geworden, Christus für Profit und Macht verraten zu haben. Die bibeltreuen Christen, welche Menschenrechte und Demokratie in Amerika erfanden, konnten sie aber in Europa nicht einführen. Sie wurden im Gegenteil verfolgt, vernichtet oder verjagt. Und zwar ausgerechnet von pseudo-christlichen Regierungen, unterstützt von der Bevölkerungsmehrheit. So kam es zu einer erstaunlichen Entwicklung: Es waren schlussendlich hauptsächlich antichristlich eingestellte Philosophen, welche die biblischen Forderungen nach Gerechtigkeit in Europa verbreiteten. Weil sie damit gegen die grossen Kirchen und pseudo-christliche Könige antreten mussten, verachteten die meisten von ihnen das Christentum und die Bibel. Das war allerdings ein Missverständnis. Sie hätten eigentlich genug Belege gehabt, um zu wissen, dass die Forderung nach gerechten gesellschaftlichen Strukturen ursprünglich aus dem Neuen Testament abgeleitet worden waren. (16) Und leider sind die meisten Europäer bis heute in genau diesem Missverständnis stecken geblieben.
Natürlich war es mehr als nur ein Missverständnis. Die Bezeichnung «Aufklärung» ist vielsagend. Es handelte sich grossenteils um einen Haufen dichterisch begabter Rebellen, welche nicht selten auch miteinander im Streit lagen. Stolz sahen sie sich selber als Schlüsselpersonen der Geschichte und verachteten die früheren Generationen. «Aufklären» muss man normalerweise Kinder, die von Tuten und Blasen keine Ahnung haben. Mit dieser Bezeichnung wird also suggeriert, dass alle bisherigen Philosophen und Religionen nur wie unwissende Kinder waren und sie nun diejenigen seien, welche die Welt «aufklären».
Insofern als sich diese Philosophen des 18. Jahrhunderts gegen ungerechte Strukturen in der Kultur einsetzten, waren ihre Schriften tatsächlich sehr wertvoll. Sie klagten Missstände an, allerdings ohne aber klare Lösungen anzubieten. Und die Meisten von ihnen meinten, der biblische Gott sei schuld
an diesen Missständen. Sie verwarfen deswegen die Bibel und bastelten sich einen Gott nach Lust und Laune, so wie es in Europa bis heute üblich ist.
15) In 1. Samuel 8 wird erklärt, dass Gott ihnen gegen seinen Willen erlaubte, einen König einzusetzen. Man kann es so verstehen, dass er mit ihnen ein Exempel startet, damit spätere Generationen verstehen können, welche Gefahren ein Absolutherrscher mit sich bringt.
16) Siehe dazu z.B. die Schriften von John Locke und Christian Fürchtegott, oder auch «Stürmischer als das Meer - Briefe aus England», von Voltaire.

Quelle: pexels / RDNE Stock project
Philipp Melanchthon ist als «der Lehrer Deutschlands» in die Geschichte eingegangen. Tatsächlich war die Idee der Volksschule eine Erfindung der Reformatoren. Zwar gab es schon im Altertum einzelne Schulen, die aber nur kurzfristig überlebten. Praktisch alle europäischen Universitäten waren dagegen ursprünglich aus Klöstern entstanden, wo Mönche über Jahrhunderte für stabile Umstände sorgten. History changer
Landeskirchen wie Freikirchen haben seither unzählige Schulen, Universitäten und Lehrerseminare auf der ganzen Welt gegründet. Im Allgemeinen waren sie aber damit überfordert, diese Schulen langfristig zu finanzieren, so dass die Tendenz festzustellen ist, dass derartige Institutionen über kurz oder lang verstaatlicht werden.
Ähnlich ging es mit Waisenhäusern, Spitälern, und unzähligen sozialen Projekten, die von Pfarrern, Priestern und Missionaren aller Art gegründet, dann aber immer mehr verweltlicht und aus verschiedenen Gründen von staatlicher Seite übernommen wurden. Viele soziale Anstalten, die heute von Staaten geführt werden, sind ursprünglich auf den Pietismus zurückzuführen. Und das keineswegs nur in Deutschland, denn es gehört zum Wesen einer christlichen Gemeinde, missionarisch und weltweit zu denken und zu handeln.
Vielerorts ist nur noch der Name der Institution christlich geblieben. Und irgendeinmal wird auch dieser verweltlicht. Das ändert aber nichts daran, dass diese Institutionen ihre Existenz eigentlich der Bibel zu verdanken haben.
Es liegt auf der Hand, dass der Staat besser für Witwen, Waisen und Betagte sorgen kann als einzelne Kirchen. Wie im Fall der Volksschule waren die Christen oft mit ihren sozialen Vorstellungen überfordert und drückten den Staat, diese zu verwirklichen. Christliche politische Parteien entstanden hauptsächlich aus dem Wunsch, soziale Projekte, welche grösser sind als die Möglichkeiten der Kirchen, auf staatlicher Ebene umzusetzen. Und das gelang auch in einem verblüffenden Ausmass. Was wir heute im Westen an Sozialstaat haben, ist für die meisten Menschen anderswo gar nicht vorstellbar. Mit dem Begriff «Christlicher Sozialismus» werden die Bewegungen zusammengefasst, die sich bemüht haben, sowohl mit kirchlichen wie auch politischen Mitteln dauerhafte Institutionen zur Hilfe von Bedürftigen zu schaffen.
Dass die Asylsuchenden, die zu Millionen aus dem Nahen Osten nach Europa kamen, hier wirklich glücklich werden, ist keineswegs garantiert. Manchmal erzählen sie aus ihrer alten Heimat, wo es viel mehr Sonne gab und das Leben so viel einfacher war. Doch wieso kamen sie überhaupt? Es sind nicht nur der Reichtum und die Menschenrechte Europas, die sie zogen, sondern auch die Sicherheit des Sozialstaates. Es ist die Erwartung, hier auf-
genommen zu werden und vom ersten Moment an menschenwürdig leben zu können. Es gibt genug Orte auf der Welt, wo Asylsuchende einfach sich selber überlassen, und nicht einmal vor Ausbeutung geschützt werden.
Welche weltweiten Auswirkungen das soziale Denken der Bibel erreichte und wie es sogar Regierungen in Staaten beeinflusst, die mit dem Christentum eigentlich nichts am Hut haben, lässt sich an einem Beispiel zeigen. Nehmen wir mal die Lebensgeschichte von Toyohiko Kagawa aus Japan. Dieser Mann, von dem gesagt wird, er habe Japan vor dem Kommunismus gerettet, gründete die «Vereinigung der Freunde Jesu». Er sah sich wie der Christus als ein Diener der Menschen, insbesondere der Armen.
Als unehelicher Waisenjunge war er bereits in jungen Jahren schwer erkrankt. Durch seine eigenen Leiden wurde er innerlich mit allen Bedürftigen tief verbunden. Er fühlte sich zu den Armen hingezogen und lebte freiwillig jahrelang in einem kleinen Raum in den Slums von Kobe. Etwa 150 Bücher schrieb er, in welchen er die Öffentlichkeit auf die Not von Arbeitern und Bauern aufmerksam machte. Er prangerte Hungerlöhne und Ausbeutung an. Nachdem Gewerkschaften bis anhin verboten gewesen waren, gelang es ihm, die erste selbstständige Arbeitervereinigung ins Leben zu rufen. Er verschrieb sich der Gewaltlosigkeit. Als einst eine Menge zehntausender Verbitterter die Maschinen der Industriellen kaputtschlagen wollten, konnte er sie auf einer Brücke aufhalten. Als die Regierung 1924 daran ging, die Elendsviertel der sechs grössten Städte Japans zu beseitigen, schrieben viele Medien diesen Schritt seinem Einfluss zu. Er startete die Zeitschrift «Boden und Freiheit» und rief die «Japanische Bauernvereinigung» ins Leben. 1928 gründete er unerschrocken die «Nationale Antikriegs-Liga von Japan» und bat die Chinesen unter Tränen um Vergebung für das Unrecht, welches seine Landsleute ihnen zugefügt hatten. Auch reiste er nach den USA, in der verzweifelten Hoffnung, durch Vermittlung den drohenden Krieg verhindern zu können. Wegen all dieser Aktivitäten war er auch oft im Gefängnis. Doch als der Krieg zu Ende war, liess ihn Kaiser Hirohito rufen, um seine Vorschläge für die Zukunft zu hören.

Rückblickend sieht alles so einfach aus: Nicht nur allgemeine Menschenrechte, Demokratie und Sozialstaat sind in Europa erfunden worden, sondern auch die moderne Wissenschaft und Medizin. An jeder Uni wird weiter geforscht. Jeden Tag vermehrt sich unser Wissen. Und das inzwischen nicht nur in Europa, sondern weltweit. Das ist in der Tat verblüffend, denn wenn wir die Geschichte studieren, fällt auf, dass von all den Völkern, welche über diese Erde gingen, nur ganz wenige jemals wissenschaftliche Fortschritte überhaupt zustande brachten. Und dass sogar diejenigen, denen es gelang, sogenannte Hochkulturen aufzubauen, wie etwa im alten China, Ägypten und Griechenland, schlussendlich erneut im Morast der Zeit versanken, ohne grosse Spuren zu hinterlassen. Ihr Wissen ging fast vollständig wieder verloren. So können wir heute nur noch mutmas-
sen, wie z.B. die ägyptischen Pyramiden erbaut wurden. Sogar die Araber, welche längere Zeit die Chance hatten, die moderne Wissenschaft zu entwickeln, packten sie nicht. Nur in Westeuropa gelang es.
Wie wir bereits schon in Kapitel 2.1.C. besprochen haben, wurden auch allgemeine Menschenrechte in der gesamten Menschheitsgeschichte auf keinem anderen Kontinent entwickelt. Es mag hier und dort gutmütige Könige gegeben haben, die gnädig mit ihren Untertanen umgingen. Aber garantierte Rechte für alle, das gab es nirgends. Bei uns scheint das so selbstverständlich, dass immer noch mehr Rechte für alle möglichen Minderheiten gefordert werden. Doch das ist nur möglich, weil hier ein allgemeines Bewusstsein vorausgesetzt werden kann, dass man keine Menschen benachteiligen dürfe. Das gab es nie zuvor auf dieser Welt. Ganz im Gegenteil: Minderheiten wurden normalerweise zermalmt. Was ist das Geheimnis des kleinen Europa? Inzwischen wissen wir, dass die meisten Kulturen dieser Welt ein gemeinsames Merkmal aufweisen: Am meisten sind auf dieser Welt Kollektivkulturen, d.h. sogenannte Ehrenkulturen verbreitet. D.h. von Generation zu Generation wird eine derart starke Verehrung des Althergebrachten vererbt, dass eine Neuerung praktisch unmöglich ist. Jeder Ausbruch aus dem Gewohnten erscheint als Unehre und als derart grosse Schande, dass sie sofort vernichtet wird, egal was die Kosten sind. Und tatsächlich können die Kosten gross sein. Um den Schandfleck auszumerzen, ist Mord und Totschlag keine Seltenheit. Dies erscheint in dieser Art von Denken dann nicht als eine böse Tat, sondern als eine Selbstverständlichkeit und sogar als Pflicht.
Können wir uns vorstellen, dass ein Vater seine eigene Tochter umbringt, und dabei überzeugt ist, etwas Gutes zu tun? Wir vermuten, dass es sich um einen Wahnsinnigen handeln muss. Doch weit gefehlt. Er hat die Tat weder im Affekt begangen, noch unter Drogeneinfluss und auch nicht unüberlegt. Die ganze Familie hat ihm geholfen bzw. ihn dazu gedrängt, diesen Mord sorgfältig zu planen, und zu guter Letzt haben ihm die Nachbarn sogar noch dazu gratuliert.
So geschieht es bis heute. Und dabei ist das nicht etwa ein Einzelfall. 5000 Ehrenmorde an Frauen registriert die UNO weltweit jedes Jahr. Und das ist nur ein Teil dessen, was wirklich geschieht, denn viele dieser Bluttaten werden als Selbstmorde oder als Unfälle getarnt.
Kommt dazu, dass dies keineswegs die einzige Art von Ehrenmord ist. Mindestens zehn Arten von Ehrenmord gibt es. Und das auf allen Kontinenten. Dazu gehören Blutrache und Familienfehden, Beleidigungsmorde, aber auch Selbstmordattentate und Mord an Ex-Muslimen.
Nun können wir uns vorstellen, dass es bei einem derartigen alles beherrschenden Konservatismus auch wissenschaftliche Neuerungen schwierig haben. Und kommt noch dazu, dass die Menschen in Ehrenkulturen gar nicht in der Lage sind, objektiv zu sehen, wie die Dinge wirklich sind. Und sogar, wenn, so hätten sie sich nicht getraut, diese beim Namen zu nennen, denn sie wurden von klein an auf eine bestimmte Sicht der Dinge und die Angst vor allen Abweichungen programmiert. Und das ist bis heute vielerorts so.
Was meine ich damit? Ich meine, dass sie ihr Leben lang darauf ausgerichtet sind, alles was geschieht, in Kategorien von «schändlich» und «ehrbar» einzustufen. Wie die Dinge objektiv gesehen aussehen, interessiert selten. So werden schon Kinder ganz anders erzogen als bei uns. Wenn westliche Eltern ihre Kinder ermahnen, sagen sie: Das ist falsch! Das ist nicht wahr! Aber in Ehrenkulturen sagt man: Das ist eine Schande!
Der Unterschied mag am Anfang nicht so gross erscheinen. Doch es ist ein völlig anderes Denken und hat unglaubliche Auswirkungen, denn die Wahrheit darf nur gesagt werden, wenn sie nicht Schande auf Respektspersonen wirft. Es wäre eine Schande, etwas Negatives über die Geschichte unseres Landes oder die Religion unseres Volkes zu sagen. So darf man auch den Eltern, oder überhaupt einer älteren Person, insbesondere wenn er ein Mann ist, nicht widersprechen. Er hat recht, weil er älter ist, und man kann etwa Lebensweisheiten wie diese hören: «Wer einen Tag älter ist, hat ein Jahr mehr Lebenserfahrung».
Auch aus der eigenen Lebensgeschichte wird alles rausgestrichen, was schändlich erscheint. Wird man danach gefragt, so ist es Pflicht, Schändliches zu verleugnen. Das ist kein persönlicher Entscheid, denn ein Schandfleck in meinem Leben kann negative Konsequenzen für die ganze Grossfamilie haben. Es würde sogar als eine Sünde gesehen, die schändliche Wahrheit zu sagen. Ein ganz einfaches Beispiel ist die Spinnenbeinegeschichte: Da der ehrwürdige Aristoteles gesagt hat, Spinnen hätten sechs
Beine, wäre es eine Sünde, zu behaupten, sie hätten acht. Denn damit würde man 1. Aristoteles sozusagen der Lüge bezichtigen, 2. Sich selber über ihn stellen, und 3. alle Vorfahren beleidigen, welche glaubten, was Aristoteles über die Spinne sagte.
Klar dass dabei echte Wissenschaft völlig auf der Strecke bleibt. Doch wie wir schon festgestellt haben, verhindert das Ehrendenken nicht nur Wissenschaft, sondern auch Menschenrechte. Weshalb das so ist, können wir verstehen, wenn wir nochmals zu dem Vater zurückkehren, der seine Tochter umbringt. Wie kommt er dazu? Wie jeder Vater liebt er seine Tochter, ist stolz auf sie und möchte ihr natürlich nichts antun. Aber eines Tages muss er der Tatsache ins Auge sehen, dass seine Tochter ihren guten Ruf verloren hat. Das ganze Dorf ist gegen sie aufgebracht. Und auch gegen ihn, denn es ist klar: Er ist verantwortlich für sie. Offensichtlich hat er sie falsch erzogen. Die ganze Familie gilt nun als nicht mehr vertrauenswürdig. Sie sind schwach und können offensichtlich nicht auf ihre Frauen aufpassen. Wenn nun ein junger Mann aus seiner Sippe um die Hand einer Frau anhält, so gibt man sie ihm nicht, denn niemand will sich mit der Schande dieser Familie beladen. Auch die Cousins finden weder Wohnung, noch Arbeit. Überhaupt wird der ganze Clan immer mehr isoliert, denn niemand möchte sich seinen eigenen Ruf verderben, indem er mit dieser Sippe in Verbindung gebracht wird. Am Ende wird das eine Frage des Überlebens: Wenn wir nicht etwas unternehmen, so wird unsere Familie aussterben. Aber was können wir tun? Es gibt nur eine Möglichkeit: den Schandfleck aus unserer Mitte wegräumen. So kommt es zum Ehrenmord.
Wir merken also: Das Ehrendenken beherrscht alles. Es befiehlt, wie man sich benimmt, was man sagt, wie man sich kleidet, ob und zu wem und wie man sich hinsetzen darf, zu wem man gastfreundlich sein und wen man verachten muss. Die Angst, in Unehre zu fallen, dominiert das Denken von morgens bis abends. Es führt die Menschen dazu, einmal liebevoll und ein andermal total herzlos zu handeln, ohne es überhaupt nur zu merken.
Die Auswirkungen kann man täglich erfahren, wenn man sich mit Menschen aus Ehrenkulturen anfreundet. Man kann davon auch jeden Tag in der Zeitung lesen, wenn man sich für Politik interessiert. Hier ist ein Beispiel: Während die katholische Kirche sich von höchster Stelle für Kreuzzüge und allerlei Ungerechtigkeiten der Vergangenheit entschuldigt hat, leugnet nicht nur der türkische Staat, sondern auch fast das ganze
Volk den Völkermord an wehrlosen Millionen von christlichen Armeniern, Assyrern und Griechen, welche ein Mehrfaches an unschuldigen Menschenleben gekostet haben als alle Kreuzzüge zusammengenommen. Ihre Loyalität zu ihrem Volk verunmöglicht ihnen, die Realität überhaupt zu sehen. Das Problem ist nicht etwa, dass sie aus Stolz eine Entschuldigung verweigern, sondern, dass sie tatsächlich überzeugt sind, diese wiederholten Völkermorde hätten gar nicht stattgefunden. Ein übereifriger englischer Journalist habe die Mär vom Völkermord in die Welt gesetzt, weil er das Volk der Türken hasste. Und da die Welt sowieso immer gegen die Türken sei, hätten sie diese Geschichte aufgegriffen und immer noch weiter aufgebauscht. Solche und ähnliche Erklärungen kann man nicht nur in der Türkei, sondern auch von europäischen Türken noch heute in aller Ernsthaftigkeit hören. Wer etwas anderes behauptet, entehre das türkische Volk, und dafür muss er sogar bestraft werden. So werden Historiker und Politiker, welche offen über den Völkermord sprachen, bis zum heutigen Tag, angeklagt, gebüsst und zu Gefängnisstrafen verurteilt.
Seit Jahrzehnten arbeiten wir als Familie mit Asylsuchenden. Wir mussten erfahren, dass sich die Geschichten, die sie über sich selbst erzählen, häufig mit der Zeit wieder ändern. Erst wenn Menschen aus Ehrenkulturen Vertrauen gewinnen, erzählen sie die wahre Story. Doch es kann auch geschehen, dass sie sich selber nicht mehr sicher sind, wie es denn wirklich war. Denn es ist Ehrensache, nichts Negatives über die eigenen Eltern, Verwandten, das eigene Volk, die eigene Religion oder gar sich selber zu denken, geschweige denn gar zu erzählen. Schon nur aus Angst. Wie wir schon erklärt haben, muss man ja befürchten, nicht nur selber ein Leben lang den Preis für den Verlust seines guten Rufes bezahlen zu müssen, sondern auch noch die ganze Verwandtschaft in Mitleidenschaft zu ziehen.
Um das verstehen zu können, müssen wir uns selber einmal hinterfragen. Es gibt vielleicht im Leben eines jeden Menschen irgendwo ein kleines Stück, für das er sich schämt und das er nicht ganz ehrlich erzählt. Oder das er sogar sich selber gegenüber abgeändert hat, bis er selber kaum mehr sicher ist, was denn damals wirklich geschah.
So ist es auch für Muslime meist ganz schwierig, die Welt so zu sehen wie Europäer, weil der Islam eine überaus starke Ehrenkultur begründet. Nehmen wir ein Beispiel, das mit dem Glauben zusammenhängt. Muslimi-
sche Freunde erklären uns, dass Lot ein Prophet sei und wie alle anderen Propheten hoch geehrt werden müsse. Christen und Juden würden sich gegen Gott versündigen, weil sie Negatives über Lot erzählen. Tatsächlich wird aber Lot in den ältesten Berichten über sein Leben weder als Prophet noch als fehlerlos beschrieben.
Seine Geschichte, die ja ursprünglich aus der Bibel stammt, ist effektiv eine traurige und zeigt unverhüllt seine Schwächen auf. Wir versuchen, zu erklären, dass wir die Geschichte von Lot nicht selber erfunden hätten, sondern dass sie seit tausenden von Jahren in der Thora so aufgeschrieben sei. Doch das beeindruckt den Muslim nicht. Er ist derart überzeugt, man dürfe nichts Negatives über den vermeintlichen Propheten Lot erzählen, dass er ohne jegliche Beweise schlussfolgert, unsere Thora sei verfälscht und nicht die Ursprüngliche.
Beachte, dass in solchen Fällen keine Lösung zu finden ist. Die Ehrenkultur ist derart vorherrschend, dass man um der Ehre willen alles, was schändlich erscheint, mit Füssen tritt. Dagegen kommen sogar historische Beweise und Fakten nicht an. Die werden wie Tennisbälle einfach weggewischt. Wie wir gesehen haben, wird vielerorts sogar vor Mord an seinen Liebsten nicht zurückgeschreckt, wenn es um Ehrenfragen geht, weil man meint, nur auf diese Weise den eigenen guten Ruf wieder herstellen zu können und müssen. In meinem Buch «Ehrenmorde vor der eigenen Haustüre»(17) habe ich dieses ganze Phänomen im Detail untersucht.
Wer die Brille des Ehrendenkens trägt, sieht die Welt anders. Das Ehrendenken hat zwar jedenfalls auch positive Aspekte wie etwa Gastfreundschaft und Familienbeziehungen. Aber meiner langjährigen Beobachtung nach ist es letztlich ein Tyrann, ein Diktator, und macht ehrliche Beziehungen zwischen Menschen sehr schwierig. Schon alleine deshalb, weil das Ziel letztlich gar nicht Liebe, sondern Pflichterfüllung ist.
Wenn wir nun all dies wissen, muss uns der Kontrast dazu, den wir in der Bibel finden, umso mehr verblüffen. Wir müssen uns vor Augen führen, wie sensationell es ist, dass dort von Anfang an total ehrliche, insbesondere auch negative Geschichten über jüdische Helden erzählt werden. Noch verblüffender wird das, wenn man bedenkt, dass sie im Nahen Osten mit ihrer bis heute überaus starken Ehrenkultur entstanden ist. Der Grund, weshalb einige Länder Europas eine ganz einzigartige Entwicklung raus
aus dem Ehrendenken machen konnten, ist der Einfluss dieses Buches. Wie genau die Bibel das Ehrendenken hinterfragt, werden wir später noch detaillierter erforschen.
Individualismus und Ehrlichkeit sind eng miteinander verbunden. Wer sich nicht als Individuum sieht, sondern in erster Linie als Teil einer Gruppe, wird auch so reden, wie diese Gruppe es verlangt, oder wie er denkt, dass sie es verlangt. Alles andere erscheint ihm nicht nur als Verrat, sondern kann für ihn unter Umständen sogar gefährlich werden. Er ist sich nicht bewusst, dass er dabei Tatsachen verdreht, sondern meint, etwas Gutes zu tun, indem er Ehre und Respekt verbreitet, auch wenn es, objektiv gesehen, Heuchelei und gelogen ist.
Normalerweise sind Kinder ehrlicher als Erwachsene. Doch auch schon kleine Kinder sind zur Lüge geneigt, wenn sie sich in einer peinlichen Situation befinden. Erwachsene lügen dagegen noch viel cleverer. Die Welt ist voll von Lüge. Ganze Völker leben in Armut, weil ihre Politiker korrupt sind. Missbrauch und Schmiergeld ist überall verbreitet. Mitten in diesem Chaos gibt es ein altes Buch, das brutal ehrlich ist. Es gibt kein Verbrechen, das verschwiegen würde, und die Schlimmsten davon werden ausgerechnet gerade den Heldenfiguren dieses Buches zugeschrieben. Das ist keineswegs selbstverständlich. Dies wird besonders deutlich, wenn wir mit anderen alten Texten aus dem Nahen Osten vergleichen, in denen prinzipiell nur einseitige Siege und übertriebene Heldengeschichten erzählt werden.
Es gibt zwar Sagen gewisser Völker, wie etwa der Griechen, die keine Hemmungen haben, durchaus auch Fragwürdiges über ihre Helden und Götter zu erzählen, und zwar aus dem Grund, weil sie deren Schwächen nicht als schlimm ansehen. Wie wir bereits wissen, soll etwa Zeus seine Frau unzählige Male betrogen haben. Überall hat er uneheliche Kinder. Als seine rechtmässige Ehefrau reklamiert, soll er sie überredet haben, sich in eine Fliege zu verwandeln, damit er sie verschlucken konnte. Das ist nicht zu vergleichen mit der Bibel, die eine hohe Moral lehrt, aber überraschenderweise gleichzeitig ehrlich darüber redet, dass die Gesetze dieser Moral gerade von denen gebrochen wurden, welche eigentlich Vorbilder sein sollten.
Im modernen Europa gibt es viele Bücher und Filme, in denen die Schwächen von Helden selbstverständlich eingebaut werden. Wir sehen das nicht mehr als aussergewöhnlich. Ein Star, der nicht irgendwie ein Han-
dicap hat, erscheint uns vielleicht sogar als unrealistisch und unsympathisch. All diese Literatur, die unser Denken seit Generationen prägt, hat aber irgendwo mal einen Anfang, ein Vorbild gehabt. Es ist alles andere als selbstverständlich, wenn wir bedenken, dass auch Europa früher von einer starken Ehrenkultur beherrscht wurde, in der Schwäche als Sünde galt. Wie sehr sich unsere Väter für nichts Anderes interessierten als für ihre Ehre, zeigt sich etwa in alten überlieferten Geschichten wie den Nibelungensagen. Das wird dann das Thema des nächsten Kapitels sein.
Dass eines Tages die Ehrlichkeit über den Respekt gestellt wurde, war grundlegend für die Entwicklung der europäischen Kultur. Dies ist bis dahin wohl nirgends sonst auf der Welt geschehen. Es geht dabei eben gerade um viel mehr, als nur darum, mehr oder weniger egoistisch zu denken und zu leben. Es geht darum, dass dabei die Fähigkeit gewonnen wurde, die Dinge zu sehen, wie sie wirklich sind. Ohne diese Fähigkeit ist jeder Versuch, Gerechtigkeit oder Fortschritt zu schaffen, zum Scheitern verurteilt. Auch die Wissenschaft hätte nicht entstehen können.
Eines der grossartigen Geschenke der Bibel an die Menschheit war also die Ehrlichkeit und die Fähigkeit, die Welt objektiv wahrzunehmen. Ohne diese Entwicklung wäre Europa bis heute auf dem Niveau der alten Germanen stehen geblieben.
17) 2016, Brunnen Verlag, ISBN 9783765520617

Wenn Sie daran zweifeln, dass die früheren Europäer von starkem Ehrendenken geprägt waren, genauso wie auf jedem anderen Kontinent dieser Erde, dann lesen Sie mal die ältesten Bücher, die Sie finden können und prüfen Sie die Kultur, welche sich da vorfindet. Sie können sich z.B. mal auf Youtube den Film «Die drei Musketiere» anschauen, oder wenigstens einen Teil davon. Alexandre Dumas hat diese Geschichte 1844 veröffentlicht. Es handelt sich zwar nicht unbedingt um eine besonders geistreiche Erzählung. Aber sie können darin gut beobachten, mit welcher Intensität die Ehrenkultur in Westeuropa teilweise noch im 19 Jhd. gelebt wurde. Schon am Anfang des Filmes verwickelt sich der Held in ein völlig unnötiges Duell, bei dem er beinahe ums Leben kommt. Und dies nur, weil jemand History changer
sein Pferd beleidigt hatte. Aber er bezog die Worte persönlich gegen sich selber, so dass er sein Schwert zog, um seine Ehre zu verteidigen. Tatsächlich hatte der französische König zu der Zeit Duelle bereits verboten. Aber man kann spüren, wie die Realität des Ehrendenkens dieses Verbot ziemlich wirkungslos macht. Der Film ist nicht nur mit Duellen angefüllt, sondern zeigt Menschen, deren Denken völlig von Eitelkeit und Ruhmstreben geprägt ist, und die darauf auch noch extrem stolz sind.
Noch eindrücklicher finde ich die Geschichte, welche im bereits erwähnten sogenannten Nibelungenlied erzählt wird. Da ist es ausgerechnet ein Liebesdienst, welcher zur Katastrophe führt. Der König Günther der mit seinen sportlichen Leistungen seine Braut beeindrucken und gewinnen möchte ist aber eigentlich ein Schwächling. Darum hilft ihm ein Schwager Siegfried insgeheim, welcher anstelle von König Günther den entscheidenden Pfeil abschiesst. Als aber die Braut später erkennt, dass sie getrickst wurde, und ihr Mann in Wirklichkeit gar nicht die Kräfte hat, die sie an ihm bewunderte, beginnt sie ihn zu verachten. Sie verlangt den Tod Siegfrieds, der sie überlistet hat. Um ihr seine Männlichkeit und seine Liebe zu beweisen, lässt König Günther tatsächlich seinen besten Freund Siegfried hinterrücks ermorden. Doch damit ist die Geschichte längst nicht zu Ende. Sie beginnt erst, denn Siegfrieds Witwe Kriemhild, welche die Schwester von König Günther ist, weiss sehr wohl, dass es kein Unfall war, der ihren Mann ins Grab brachte, und sinnt auf Blutrache gegen ihre eigenen Brüder. Sie muss allerdings viele Jahre warten, bis sich die Gelegenheit dazu bietet, denn Blutrache ist für sie als Frau besonders schwierig. Doch das Feuer brennt in ihr. Erst als der Hunnenkönig um ihre Hand anhält, steigt sie wieder zu einer Machtposition auf. Nun gelingt es ihr, bei den Hunnen insgeheim Feindschaft gegen ihre eigenen Brüder zu pflanzen, während sie vordergründig ein gemeinsames Fest plant. Durch ihre Intrigen und dank der Mechanismen der Ehrenkultur artet dieses in eine mörderische gegenseitige Schlächterei aus, wobei praktisch die ganze Familie ums Leben kommt.
Beachte, dass nicht nur die Ehrenmorde, sondern auch viele andere Details der Geschichte auf Ehrenkultur hinweisen. So gilt der Vater als Vormund seiner Tochter, und bei der Hochzeit geht die Vormundschaft auf ihren Mann über. Als Kriemhild ihren eigenen Bruder erschlägt, wird nicht etwa der Schmerz über seinen Tod als das Schlimmste an der Situation beschrieben, sondern die Schande, als Edelmann durch die Hand einer Frau zu sterben.
Derartiges Denken und die kulturellen Elemente, die in der Geschichte enthalten sind, schockieren den modernen Europäer. Das Verhalten der Menschen kommt uns grossenteils primitiv und völlig überreagiert vor. Wir können uns vorstellen, dass vielleicht ein Extremist so handelt, aber ganze Völker und Kulturen? Vor allem kommen uns Ehrenkulturen auch als total ungerecht vor. Stelle man sich nur vor, dass es sehr verbreitet ist, bei einer Vergewaltigung die Schuld prinzipiell auf die Frau zu legen, und sie dafür bestialisch zu bestrafen, obwohl sie doch der schwache und überfallene Teil ist, und sogar wenn sie sich wehrt und schreit, ihr guter Ruf als für immer verloren gilt, während der beteiligte Mann häufig weiterleben kann, als wäre nichts geschehen.
In den Ehrenkulturen wird meistens ein Fehler nicht objektiv bewertet. Es kommt immer darauf an, wer ihn begangen hat. Der Wert eines Menschen wird unterschiedlich eingeschätzt, etwa nach dessen Geschlecht, Alter, Herkunft und Beruf, obwohl die meisten Menschen sich nichts davon selber ausgewählt haben. Unzählige leiden ihr Leben lang, meistens ohne auch nur zu wissen, dass es auch anders sein könnte. Weil sie nun mal zu einem verachteten Stamm gehören, gibt es für sie z.B. keine Möglichkeit zum sozialen Aufstieg. Es ist vielfach auch nicht möglich, den Menschen zu heiraten, den man eigentlich lieben würde. Nicht selten werden junge Frauen aus armen Kreisen gezwungen, einen Behinderten oder älteren Mann zu ehelichen, weil dieser reich ist oder zu einer angeseheneren Familie gehört. Und damit meint man, diesem Mädchen einen guten Dienst erwiesen zu haben. Der Einzelne hat selten die Möglichkeit, sich zu wehren. Aber nicht nur die unteren Klassen leiden. Es trifft alle. So erzählt Carmen bin Laden in ihrem Buch «Der zerrissene Schleier» unter anderem die Geschichte einer saudischen Prinzessin, die auf Befehl ihres Opas, des Königs, ermordet wurde, weil sie sich weigerte, den Mann zu heiraten, den er für sie ausgewählt hatte.
Die grosse Angst der Ehrenkulturen sind Schandflecken. Nicht nur der Mensch, auf dessen Leben ein schwarzer Fleck fällt, sondern auch seine Familie wird für immer gekennzeichnet sein. Die Schande kann derart stark empfunden werden, dass die Betroffenen in tiefen Depressionen versinken.
Ein schwarzer Fleck kann auch völlig Unschuldige treffen. Es genügt, dass ein Ehepaar keine Kinder zeugen kann. Zum eigenen Schmerz kommt
hinzu, dass dieses Paar nun als das schwache Glied in der Kette ihrer Grossfamilie gesehen wird. Nicht nur der Mann, sondern auch seine Verwandten werden den Hohn und die Enttäuschung zu spüren bekommen, auch wenn er nur hinter ihrem Rücken ausgesprochen wird.
Manche unserer Asylsuchenden sind nicht vor dem Krieg geflohen, sondern vor der Blutrache. Wenn jemand aus einer Familie eine Person aus einer anderen Sippe ermordet hat, werden jene zur Rache verpflichtet. Und das kann für alle Verwandten lebensgefährlich werden, weil es irgendeinen von ihnen treffen kann. Sie müssen sich über Jahre und Jahrzehnte verstecken, können nicht zur Schule bzw. nicht zur Arbeit gehen. Aber wovon sollen sie leben?
Stellen Sie sich vor, Ihr Bruder sei ermordet worden. Nun sind Sie die Person, welche die Blutrache ausführen muss. Falls Sie sich weigern, werden Sie und Ihre Sippe über Generationen als verächtliche Schwächlinge verlacht werden. Wenn Sie Arbeit oder eine Wohnung suchen, wird man andere vorziehen. Wenn einer Ihrer Verwandten eine Braut heiraten will, wird man sie ihm nicht geben. Und Sie gelten dann jedesmal als der Schuldige.
Die Ehrenkultur setzt den Menschen also unter unheimlichen Druck. Können wir uns vorstellen, was es braucht, einen Vater zu überzeugen, seine eigene Tochter umzubringen? So ein Fall ist einmal in Afrin, Syrien, geschehen, wie mir von mehreren Personen direkt erzählt wurde. Diese Tochter war einige Tage nicht nach Hause gekommen. Das ganze Dorf hat schon darüber gemunkelt. Der Vater kam unter unerträglichen Druck. Als die Tochter gefunden wurde, hat er sie erstochen. Doch der Arzt, der sie danach untersuchte, sagte zwei Dinge zu ihm, mit denen er nicht gerechnet hatte. Erstens: Sie sei immer noch eine Jungfrau. Zweitens: sie sei nicht an seinem Messerstich gestorben, sondern an Herzstillstand. Der Schreck, als ihr Vater auf sie zukam, habe sie umgebracht. Danach konnte dieser Vater nicht mit der Tatsache leben, dass er seine unschuldige Tochter auf dem Gewissen hatte, und er verlor seinen Verstand!
Diejenigen, welche vor ungeschmälertem Ehrendenken in den Westen fliehen, haben also allen Grund dazu. Man kann ja nur den Kopf schütteln über derart zerstörerischen Kulturen, und vor allem darüber, dass praktisch alle mitmachen. Es gibt tatsächlich Ausnahmen. Ich kenne einen Vater, der sich weigerte, seinen Sohn zu töten, obwohl dieser in Schande
gefallen war. Nun hätten sich die Nachbarn ja eigentlich freuen dürfen, dass ein Mord verhindert worden war. Weit gefehlt! Dieser Mann verlor alle seine Freunde. Mehr als dies: Er verlor auch alle seine Kunden und musste sein Geschäft schliessen. Dadurch fiel er in Schulden und landete schlussendlich im Gefängnis. Niemand half ihm.
Das ist die Realität der Ehrenkultur: Es ist keineswegs Extremismus! Es ist offensichtlich vielmehr das, was den meisten Menschen als normal und vernünftig erscheint, denn mindestens 99% der Einwohner machen mit. Und keineswegs nur in einem Land. Es ist ein weltweites Phänomen. In Indien werden sie es genauso finden wie bei Muslimen und unzähligen Naturvölkern. Und ja: bei unseren eigenen Vorfahren, welche sich in Duellen, Familienfehden und unzähligen sinnlosen Kriegen, bei denen es letztlich nur um die Ehre ging, gegenseitig vernichteten.
Doch wieso sind die Menschen denn so blind? Wieso merken die nicht selber, dass da etwas schief läuft? Warum ist es so einfach, Väter zu manipulieren, bis sie sogar ihre eigenen Kinder umbringen, für die sie sich ein Leben lang aufgeopfert haben? Warum verlieren diese Kulturen nicht automatisch von Jahr zu Jahr an Intensität?
Nun, es gibt nur eine Erklärung. Offensichtlich ist das die Kultur, die genau dem entspricht, was wir zutiefst sind. Es ist für uns natürlich, nach Ehre zu streben. Es fällt uns leicht, andere zu überholen und zu verachten. Vorurteile, Neid und Rassismus benötigen keine Anstrengung, sondern begleiten uns durch das Leben. Das, was wir im Westen zu leben versuchen, nämlich gleiche Rechte für alle, Demokratie und Meinungsfreiheit, ist dagegen etwas sehr Unnatürliches. Deshalb hat der grösste Teil der Welt die Demokratie nur zum Schein aufgenommen, während in Wirklichkeit nach wie vor alle möglichen Elemente der Ehrenkultur darüber wuchern und sie unwirksam machen. Zwar übernehmen alle Völker im Allgemeinen gerne die westlichen technischen Erfindungen, nicht aber deren Menschenrechte. Anstatt uns zu kopieren, suchen sie bei uns nach Fehlern und verachten uns. Sogar viele der Asylanten, welche nach Europa kommen, um endlich auch einmal Rechte zu haben, schauen wegen der Freiheit, die sie hier tagtäglich beobachten können, innerlich auf uns herab. Und genau das ist ja der Beweis, dass das Ehrendenken lebendiger ist denn je.
Haben Sie auch schon peinliche Situationen erlebt? Ich meine den Moment, an dem sie eine Million bezahlen möchten, nur um - wie das Sprichwort sagt - gerade jetzt «im Erdboden versinken» zu können, so dass niemand mehr wüsste, was Sie getan haben? Genau hier sind einige Wurzeln der Ehrenkulturen. Die weltweite Verbreitung des Ehrendenkens, nicht nur mit seinen Positiven, sondern auch mit den katastrophalen Konsequenzen, sagt vor allem sehr viel über den Menschen aus. In vielen Situationen fällt es uns viel schwerer, zur Wahrheit zu stehen als zu lügen. Nicht einmal in erster Linie wegen den materiellen Verlusten, sondern ganz einfach weil wir uns schämen. Die seelischen Instinkte, die uns zutiefst bewegen (abgesehen von körperlichen Instinkten wie Essen, Trinken und Sexualität), sind Scham und Ehre. Es ist uns nicht egal, was «die Leute» von uns denken.
Wir sind zutiefst ehrsüchtige Wesen. Und das trägt sogar auch im heutigen Westen seine Früchte. Denken Sie nur einmal an den Spitzensport. Wenn Sie meinen, dabei gehe es in erster Linie ums Geld, haben Sie nur an der Oberfläche gekratzt. Die Chance, dabei reich zu werden, ist klein. Viel realistischer ist die Gefahr, dabei noch seine letzten Ersparnisse zu verlieren. Und die Gefahr, seine Gesundheit für immer zu ruinieren. Trotzdem machen Unzählige mit, in der Hoffnung, irgendeinmal irgendwo auf einem Siegerpodest zu stehen und beklatscht zu werden.
Was motiviert uns zutiefst? Wenn wir es nicht bewusst zurückweisen, sei es auf Grund von Erziehung oder eigenem Entscheid, wird es viel zu oft eben die untergründige Ehrsucht sein, die unser Fühlen und Handeln bestimmt. Die weltweite Realität der Ehrenkultur sagt sehr viel über das Wesen des Menschen aus. Doch dazu kommen wir später nochmals zurück.

History changer
Auf den ersten Blick erscheinen Ehrenkulturen viel wärmer und herzlicher im Vergleich zur Lebensart des Westens. Es ist viel interessanter und mitunter auch fröhlicher, wenn viele Aspekte eine Situation beeinflussen können und es nicht immer nur pingelig darum geht, was wahr und gerecht sei. Das Ehrendenken trägt zudem viel dazu bei, stabilere Familien zu bauen. Doch die warmen Beziehungen, die darin gelebt werden, können den kritischen Beobachter nicht darüber hinwegtäuschen, dass die Liebe dort an Bedingungen geknüpft ist. Ehrenkultur ist immer auch Verachtenskultur. Während die Einen immer noch mehr geehrt werden, leiden diejenigen am anderen Ende der Skala. Urplötzlich kann jemand in Ungnade fallen und alles verlieren. Dann wird er ausgestossen und niemand hilft ihm. Davor hat man Angst. Deshalb ist die Ehrenkultur auch mit enormen Ängsten verbunden.
Wie wir bereits festgestellt haben, ist Europa die grosse Ausnahme. Hier hat sich Widerstand gegen das Ehrendiktat geregt, und zwar keineswegs erst zur Zeit der Aufklärer, sondern schon lange zuvor. Eine derartige Kultur zu überwinden, benötigte natürlich Veränderung in vieler Hinsicht. Wir haben bereits über einige gesprochen. Da ist die Abschaffung der Menschenopfer; die schrittweise Einführung der Rechte für die Frau und Menschenrechte, die für alle gelten. Hier ist die Demokratie erfunden worden, als ein Staatswesen, in dem alle weitgehend gleichberechtigt sind. Wie wir schon erwähnt haben, hat die Kirche bereits im Mittelalter grosse Anstrengungen unternommen, um die Sklaverei innerhalb Europas zu überwinden. Über die Jahrhunderte sind auch unzählige Dramen und Romane geschrieben worden, in denen vielleicht nicht die Ehrenkultur als Ganzes, aber immerhin einzelne Aspekte davon angeklagt werden. So etwa das erwähnte Nibelungenlied, das schon im Mittelalter aufzeigt, zu welchen Katastrophen das Ehrendenken führen kann. Gerade dieses Drama mag durch seine ehrliche Berichterstattung zur Veränderung beigetragen haben. Doch die Elemente, die zum Umschwung führten, sind noch viel älter.
Das beginnt tatsächlich schon im Alten Testament mit ein paar Überraschungen. Mitten zwischen den grössten Heldengeschichten von Gottesmännern wie Abraham, Jakob, David und Salomo wird uns deren Versagen erzählt. Weshalb wurde z.B. Davids Ehebruch mit Bathseba und sein Mord an Uria nicht aus der Bibel gestrichen? Das sind jedesmal Tabubrüche gegen die Ehrenkultur. Doch noch viel deutlicher wird es in den Evangelien. Haben Sie sich jemals darüber gewundert, dass Jesus gehasst und gekreuzigt wurde? Er lehrte und tat ja eigentlich nur schöne Dinge. Jeder kann doch damit einverstanden sein, dass wir einander lieben und Gutes tun sollten; er gab grossen Menschenmengen zu essen und heilte die Kranken. Da gibt es nichts, was jemand dazu bringen könnte, ihn zu verfluchen. Oh doch! In Wirklichkeit lehrte er eben brisante Dinge, die der oberflächliche Leser leicht übersehen könnte. Nehmen wir sein Gleichnis über den barmherzigen Samariter. Wir haben uns so sehr daran gewöhnt, dass uns vielleicht gar nicht mehr auffällt, wie heikel es ist, wenn er in dieser Geschichte Priester und Leviten, die absoluten Ehrenpersonen seines Volkes, auf die Schippe nimmt. Oder bei der Erzählung vom verlorenen Sohn: Da wird der schändliche Taugenichts, der dem ganzen Dorf nur Schmach
gebracht hatte, über den ehrlichen, treuen und älteren Bruder gestellt. In Matthäus 6 werden die frommen Juden, die Almosen geben, fasten und beten, als Heuchler dargestellt. Gemäss dem Bericht des Lukasevangeliums treibt er schon in Kapitel vier in Nazareth seine eigenen Nachbarn zur Weissglut, weil er ihnen die verachtete heidnische Witwe von Zarepta und den syrischen General Naaman als Vorbilder vor die Nase malt. Im fünften Abschnitt des Evangeliums stellt er sich über die Hohepriester, wenn er behauptet, Sünden vergeben zu können. Zudem setzt er sich mit den verhassten Zöllnern zum Essen und Trinken, obwohl sich diese doch mit römischem Geld und Betrügereien verunreinigt hatten. Schon im nächsten Kapitel tut er alles am Sabbat, was verboten war. Und in Kapitel 7 schlägt er dem Fass den Boden aus, indem er sich von einer stadtbekannten Prostituierten berühren lässt, und sie sogar über den respektablen Pharisäer Simon stellt, der notabene sein Gastgeber ist. Diesen kritisiert Jesus, weil er ihm kein Wasser zum Füssewaschen bringen liess, noch ihn küsste, noch sein Gesicht mit Öl salbte. Selbstverständlich wird in Ehrenkulturen nicht nur die Gastfreundschaft, sondern so ziemlich alles kritisiert, aber doch nicht öffentlich! In Kapitel 8 schlägt er seine eigene Familie vor den Kopf, indem er erklärt, seine Jünger seien nun seine Mutter und seine Brüder. In Kapitel 9 beschimpft er das ganze Volk der Juden, indem er sie ein «verkehrtes und ungläubiges Geschlecht» nennt.
Soll ich weiterfahren? Kapitel für Kapitel beleidigt er die Leute auf Arten und Weisen, welche gerade in empfindlichen Ehrenkulturen extrem stark empfunden werden. Man kann nicht anders als feststellen, dass er es offenbar für seine Aufgabe hielt, einen Frontalangriff auf vieles, was als ehrbar galt, zu starten. Und nachdem wir ja die Mechanismen der Ehrenmorde studiert haben, verstehen wir nun, weshalb die Juden ihn gemäss den Berichten des Neuen Testamentes vielfach töten wollten. Jeder, der sich nicht an die Regeln hält, wird ausgestossen und vernichtet.
Die Jünger Jesu verstanden, dass ihr Meister sie nicht dazu berufen hatte, ein wenig frömmer und ein wenig netter als andere Menschen zu sein, sondern dass sie ein prinzipiell ganz anderes Leben führen sollten als ihre Mitmenschen. Sie gründeten regelrecht eine Gegenkultur zu den gegebenen Lebensweisen ihrer Zeit. Einige der Gegensätze werden in den ersten Kapiteln der Apostelgeschichte sehr betont. So waren die Gläubigen ein Herz und eine Seele, sie hatten alles gemeinsam und assen zusammen, obwohl sie aus allen möglichen Völkern stammten. Die Juden dagegen
waren dauernd am Streiten über ihre komplizierten Gesetze, sie konnten auch nicht mit den Angehörigen anderer Völker essen, sondern sonderten sich die ganze Zeit ab, um sich nicht zu verunreinigen. Im Vergleich mit dem Judentum war also eine unbekümmerte Offenheit über der ersten Gemeinde, weil die Zwänge und Ängste der Ehrenkultur abgeworfen waren. Dies ärgerte zwar die beleidigten Juden, es zog aber viele Griechen und Römer an. Auch ihre Kultur enthielt viele Ehrenelemente, aber auf andere Art und Weise. Wie wir schon in Kapitel 2.1.b) erwähnt haben, wurden in den ersten Jahrhunderten vor allem Frauen, Kinder und untere Schichten in die Kirche gezogen, wohl nicht zuletzt deswegen, weil sie hier als Menschen bedingungslos akzeptiert wurden, ungeachtet ihrer niedrigen sozialen Stellung. Die erste Kirche muss grossartig gewesen sein. Man stelle sich vor, dass sie über 300 Jahre die schlimmsten Verfolgungen überleben konnte, ohne Kompromisse mit dem Heidentum zu machen. Und sie gewann immer noch mehr Mitglieder. Zur Zeit des Kaisers Konstantin sollen es etwa zehn Prozent der ganzen römischen Bevölkerung gewesen sein.
Doch dann geschah das Missgeschick. Kaiser Konstantin war es, der Jesus mit einem Kriegsgott verwechselte. Er soll am Abend vor einer Schlacht ein Kreuz am Himmel gesehen und dann mit diesem Zeichen den Sieg über seine Gegner errungen haben. Natürlich war es toll, dass die Christenverfolgungen aufhörten, aber die Kirche hätte nicht zur Staatsreligion erhoben werden sollen. Denn der Staat benutzt das Schwert, das Jesus ablehnte. Die Folge war, dass die Römer zwar Christen wurden, aber nicht Jünger von Jesus. Die europäischen Völker wandten sich nach und nach dem Christentum zu, ohne aber ihre Ehrenkulturen zu hinterfragen. Im Gegenteil, sie übersahen die Teile der Bibel, welche mit ihrem Ehrendenken nicht kompatibel waren, und blieben grossteils bei ihrem vorgefertigten System. Die Geschichte von Jesus wurde zwar gelesen, aber nur ein Teil davon ernst genommen.
So kommen wir zum Mittelalter, das nicht deswegen finster war, weil es christlich war, sondern weil man das Christentum mit heidnischen Ehrenkulturen verheiratet hatte. Die Strukturen der heidnischen Gesellschaften wurden beibehalten, so dass es Könige, Adlige, Ritter, und Unfreie gab. Auch die drei Stände der Lehensherren, des Klerus und der Sklaven waren keineswegs eine biblische Erfindung, sondern vom alten Germanentum übernommen. Obwohl Kindermord, Menschenopfer, Hexenverfolgung
und Ähnliches überwunden wurde, hat man doch viele Übel der Ehrenkulturen ins Mittelalter reingeschmuggelt. So finden wir dort unter vermeintlich christlichen Vorzeichen Machtstrukturen, Glaubenszwang, Schmiergeld, übertriebenen Respekt bzw. Verachtung, Lüge, Betrug, Gewalt und Anfangs sogar Sklaverei. Von da an muss man unterscheiden zwischen Christen und Jüngern Jesu. Diese zwei Begriffe gleichzusetzen wird nun fatal.
Wie war das möglich, wenn doch die Bibel das meist verbreitete Buch war? Teilweise kann man es damit erklären, dass damals nur wenige Europäer überhaupt lesen konnten. Nur die Reichen konnten sich Hauslehrer für ihre Kinder leisten. Doch auch wenn die Mächtigen und die offizielle Kirche grosse Teile der Botschaft Jesu nicht verstanden bzw. nicht ernst nahmen, so gab es doch immer Ausnahmen. Und zwar innerhalb und ausserhalb der offiziellen Kirche. Es ist faszinierend, zu sehen, welch unterschiedliche Blüten die Botschaft Jesu im Laufe der Jahrhunderte hervorbrachte. Wir werden jetzt ein paar Beispiele anschauen, die zeigen, wie der Einfluss der Bibel allmählich an der mittelalterlichen Ehrenkultur zu rütteln begann:
a) Verschiedene mönchische Reform- bzw. Bettelorden: Franz von Assisi, der um 1200 lebte, ist eine der bekanntesten Persönlichkeiten der Weltgeschichte. Ihm wird zugeschrieben, dass er den Tieren gepredigt habe und den arabischen Khalifen beinahe bekehrt hätte. Ursprünglich stammte er aus reichem Haus. Weil er aber die Güter seines Vaters an die Obdachlosen verschenkte, verklagte ihn dieser vor Gericht. Da zog Franz seine Kleider aus, gab sie dem Vater zurück und verzichtete sogar auf jegliches Erbe. Stattdessen bettelte er. Kein Wunder also, dass viele über ihn spotteten. Mönche gab es schon seit Jahrhunderten. Weshalb also schlossen sich die Franziskaner nicht einfach den bestehenden Klöstern an? Tatsächlich wollte Franz ursprünglich eigentlich gar keinen Orden gründen, sondern einfach leben wie Christus. Aber innerhalb der bestehenden Kultur war es nicht möglich, einfach irgendwie zu leben. Seine revolutionären Ideen mussten in einer bekannte Form ausgedrückt werden, um überhaupt überleben zu können. Die Bettelmönche waren sozusagen die ersten Sozialarbeiter Europas. Sie erbettelten sich ihren Lebensunterhalt von den Reichen, um die Kranken und Armen pflegen zu können, welche nichts bezahlen konnten.
Die «Fioretti» und andere Schriften über sein Leben fanden über Jahrhunderte weite Verbreitung und Unzählige liessen sich vom Vorbild des Franziskus inspirieren, und zwar sowohl Katholiken wie auch Protestanten. Dabei ist das herausragende Merkmal seine Ablehnung des Lebensstils seines Vaters, der ihn zu einem «Ehrenmann» machen wollte. Er scheute keine Schande und ertrug Spott, um so wie Christus den Armen zu dienen. Sein Leben setzte ein klares Fragezeichen hinter das vorherrschende Ehrendenken, das sich für alle Zeiten tief in das Bewusstsein Europas eingrub. Und er war keineswegs der Einzige. Ähnlich motiviert waren auch verschiedene andere Bettelorden, die in jener Zeit gegründet wurden. Anstatt die Schwachen zu verachten, wie es zur klassischen Ehrenkultur gehört, sahen sie in ihnen Christus, und gaben ihnen damit den grössten Wert. Sie lebten das genaue Gegenteil der Ehrenkultur.
b) Teile der gregorianischen Reform: Diese Reformbewegung innerhalb der katholischen Kirche hat ihren Namen von Papst Gregor VII. Das ist allerdings etwas irreführend, denn ursprünglich ging die Erneuerung von einem Kloster aus. Es war die Abtei von Cluny im Burgund, die sich zeitweise zum wohl einflussreichsten Kloster von ganz Europa entwickelte und die Reform vorantrieb. Nicht alles, was in jener Bewegung gefordert wurde, war gut. So wurde damals das Verbot zu heiraten von Mönchen auf Priester ausgeweitet. Ein grosser Fehler, wie leider erst in unserer Zeit bemerkt wurde.
Man meinte damals auch, die Kirche müsse Europa politisch beherrschen. Dies ganz im Gegensatz zum Vorbild von Jesus. Gut war dagegen, dass Korruption bekämpft wurde und insbesondere, dass das römische Recht hervorgeholt und auf alle Europäer ausgeweitet wurde. Die Römer hatten ja im Laufe der Zeit ein ganz ordentliches Rechtssystem ausgearbeitet, obwohl es leider nur auf freie Bürger angewendet wurde. Und das war sogar unter den Männern nur eine Minderheit. Dieser Fehler sollte nun aus christlicher Motivation ausgebügelt werden. Tatsächlich machte es die Kirche ums Jahr 1100 zu ihrem Ziel, die europäischen Adeligen zu zwingen, ihren Untertanen grundlegende Rechte zu gewähren und zwar - wie erwähnt - mit der ausdrücklichen Begründung, dass die Seele Gott gehöre und kein Mensch die Seele eines anderen besitzen könne. Auch wenn das natürlich politisch nicht überall durchsetzbar war, wurde doch damit inneneuropäisch nachhaltig die Idee gepflanzt, dass es auf diesem Kontinent keine Sklaven mehr geben dürfe. Auch wenn diese Entwicklung langsam war und noch viele
Schritte benötigte, haben wir allen Grund, darüber zu staunen, dass sie überhaupt geschah, denn es war ein Novum in der Menschheitsgeschichte. Zur gregorianischen Reform ist noch zu sagen: Der Kampf zwischen der katholischen Kirche und dem deutschen Kaiser, der durch sie schlussendlich ausgelöst wurde, mag ein dunkles Kapitel in der Geschichte Europas gewesen sein, aber sie führte zu einem guten Resultat: Die Kirche musste nämlich die politische Oberherrschaft abgeben. Minimale, aber nicht unwichtige Schritte in Richtung Trennung von Kirche und Staat. Das ist eine einzigartige Entwicklung, welche die Entstehung des modernen Westens erst ermöglicht hat. Einzigartig sage ich deswegen, weil die Vermischung von Religion und Politik bei praktisch allen Völkern als völlig selbstverständlich erscheint. Diese Trennung stimmt allerdings mit der Lehre des Messias überein, welche seine Jünger anwies, «dem Kaiser zu geben, was des Kaisers ist und Gott, was Gottes ist.» Eine derartige Entwicklung gibt es im Islam bis heute nicht, wo es noch besonders schwierig ist, Politik und Religion zu trennen, weil Mohammed selber ein Politiker war.
c) Devotio moderna (14. bis 16. Jhd.): Eigenartigerweise ist diese innerkatholische Bewegung ziemlich unbekannt, obwohl sie sehr einflussreich gewesen sein muss. Sie startete in den Niederlanden, schwappte aber auf andere Länder über, insbesondere auf Deutschland. Gemäss einigen Historikern soll sie den Boden nicht nur für die deutsche Renaissance, sondern auch für die Reformation vorbereitet haben. Sogar der vielleicht berühmteste aller Humanisten, Erasmus von Rotterdam, wurde in dieser Denkrichtung erzogen. Das wichtigste Buch der Devotio moderna wurde mit der Zeit zum meistverbreiteten christlichen Werk ausser der Bibel. Es hiess «Nachfolge Christi» und wurde von einem Mönch namens Thomas von Kempen geschrieben. In sehr einfacher Sprache wird darin das Vorbild Christi auf ganz banale Lebenssituationen angewendet, wobei die Betonung darauf liegt, so wie Christus von Herzen demütig Gott und den anderen Menschen zu dienen, indem man mit Freude die geringsten Arbeiten wie Reinigung oder Krankenpflege übernimmt. Eigentlich wurde das Buch für den Unterricht der Novizen im Kloster geschrieben, aber es verbreitete sich in verblüffendem Ausmass unter der Bevölkerung. Darin ist die Bergpredigt das grosse Vorbild, aber auch deren Anwendung im Leben des Christus, als er willig Ungerechtigkeit, Schande und Leid ertrug. Damit sind wir natürlich wiederum ganz auf biblischem Boden und beim Gegenteil des Ehrendenkens angekommen. Diese Bewegung hat also das Ehrendenken über Generationen ganz gewaltig hinterfragt.
d) Vorreformatoren: Eigentlich war die Reformation keine Überraschung, denn es hatte schon lange gebrodelt in Europa. Eine ganze Reihe von Reformbewegungen entstanden in England, Frankreich, Italien und Deutschland. Nehmen wir ein Beispiel: Petrus Waldes von Lyon in Südfrankreich. Er wurde der Gründer der Waldenserkirche, die es bis heute gibt. Zurecht hat man ihn oft mit Franz von Assisi verglichen, denn auch er war ursprünglich ein reicher Kaufmann und wählte das Betteln, Predigen und die Fürsorge der Armen und Kranken aufgrund der Bibel zu seinem Lebensstil. Seine Anhänger gelten als «die Armen von Lyon», in Norditalien dann als «Lombardische Arme».
Schon 300 Jahre vor Luther liess er die Bibel in die Lokalsprache übersetzen, lehrte die Laien-, ja sogar die Frauenpredigt, lehnte Fegefeuer, Heiligenverehrung und Kirchensatzung ab. Er nahm also praktisch die Reformation voraus. Anfangs versuchte er zwar, den Konflikt mit der Kirche zu vermeiden, ging nach Rom, soll dort aber als Laienprediger von den Bischöfen ausgelacht worden sein. Immerhin gelang es ihm, von Papst Alexander III. eine Bewilligung zur Laienpredigt zu erhalten. Trotzdem kam es später zu einem Verbot und zu tödlicher Verfolgung der Waldenser. Viele flohen in unzugängliche Alpentäler, um überleben zu können.
Wenn man bedenkt, dass muslimische Armeen 2/3 der christlichen Welt besetzten und zudem die christlichen Pilger auf ihrer Reise nach Jerusalem hinmetzelten, kann man durchaus Verständnis für die Kreuzzüge im Nahen Osten aufbringen. Nur den Kopf schütteln muss man allerdings über andere Kreuzzüge, welche innerhalb von Europa mit unglaublicher Brutalität gegen grossenteils friedliche Waldenser, Katharer, Hussiten u.ä. geführt wurden. Tatsächlich gelang es der katholischen Kirche dadurch, manche konkurrierende Lehren völlig auszurotten. Doch die Waldenser überlebten bis heute und ihre Lehre hat sich in der Reformation sogar über ganz Europa verbreitet, weil sie nichts anderes als das ist, was die Bibel, an welche die katholische Kirche zu glauben behauptet, selber lehrt.
Sowohl die mönchischen Reformorden als auch die Devotio moderna blieben offiziell innerhalb der katholischen Kirche. Wie war das möglich, wenn sie doch ein der kirchlichen Ehren-Hierarchie völlig entgegengesetztes Denken und Handeln entwickelten? Tatsächlich lebten sie ihren Glauben in eigenen Gemeinschaften, gingen um des Friedens willen auch gewisse Kompromisse ein und entschlossen sich, die Kirche nicht zu kritisieren. Die
Vorreformatoren dagegen agierten viel unabhängiger. Und darum kam es, wie es kommen musste, denn keine Ehrenkultur erträgt Unabhängige. Sie werden als Schandfleck wahrgenommen und ausgemerzt.
Als Reaktion auf die vor-reformatorischen Bewegungen wurde es zeitweise sogar verboten, die Bibel in europäische Sprachen zu übersetzen. Ja, ob Sie es glauben oder nicht: Nur Priester und Mönche durften die Bibel überhaupt lesen und zwar nur auf lateinisch, denn sie hatten ja der Kirche die Treue geschworen, und unter Gelübde versprochen, nichts darin zu beachten, was der katholischen Ehrenhierarchie entgegenläuft. Gibt es einen deutlicheren Beweis dafür, dass dieses Buch der entscheidende Faktor zur Veränderung Europas war, als dass es von den Würdenträgern selber als gefährlich empfunden wurde?
e) Reformatoren: Genau wie Waldes wollte Luther die Kirche zu ihren Wurzeln zurückführen und ursprünglich gar nicht eine neue Kirche gründen. Doch Papst Leo X., mit dem er es zu tun hatte, war ein sogenannter Renaissancepapst. Anfangs meinte Luther, dass er dem Papst nur die Missstände in der Kirche erklären müsste, und der würde sie dann schon flicken. Er setzte voraus, dass der Papst sich selbstverständlich von biblischen Argumenten überzeugen liesse. Doch was den Papst interessierte, waren Parties und Künste. Er hatte nicht wie Luther ein weltliches Studium aufgegeben, um für Gott zu leben, sondern war von seiner Familie von Geburt an zum Kirchenmann bestimmt worden. Mit 13 war er schon Kardinal. Er war Reichtum und Luxus gewöhnt. Da fand er seine Vorbilder nicht bei Jesus, der nicht wusste, wo er sein Haupt hinlegen sollte, sondern bei den wohlhabenden alten römischen und griechischen Edelmännern.
Haben Sie jemals versucht, mit einem Menschen, der im Ehrendenken verwickelt ist, zu diskutieren? Das funktioniert nicht. Der hört gar nicht, was man sagt. So war auch die Antwort von Papst Leo an Luther. Man kann sie so zusammenfassen: Was fällt Dir kleinem Priesterlein eigentlich ein, die Kirche zu kritisieren? Bist eigentlich du der Chef, oder bin ich der Chef? Und er stiess ihn aus der Kirche raus. Damit beraubte er ihn jeglicher Rechte und gab ihn effektiv zum Abschuss frei. Ehrenkulturen können sehr warm, aber auch urplötzlich völlig irrational und herzlos sein.
Vielleicht deutlicher als anderswo kann man bei der Reformation das Aufeinanderprallen der zwei Kulturen beobachten: Das Bestreben Luthers, die
Wahrheit zu finden und diese knallhart mitzuteilen, egal was es ihn oder andere kostet. Dagegen die katholische Reaktion, welche eine derartige Schande eines simplen Mönchs mit jedem Mittel aus der Welt schaffen will. Dabei konnte der Papst die eigentliche Schande gar nicht erkennen: nämlich mit Fegefeuerlehren im Namen Christi den einfachen Menschen auf ihr Gewissen zu drücken, um ihnen ihr letztes Geld abzunehmen, während er selber ganz unchristlich in gewissenlosem Luxus schwelgte.
f) Wiedertäufer und ihr Ruf nach Freiheit: Ich werde jenen Tag nie vergessen. Am meisten fasziniert waren meine amerikanischen Gäste nicht etwa von den Berner Alpen, dem Bundeshaus oder dem Rheinfall, sondern von einem schlichten alten Haus an der Neustadtstrasse 6 hinter dem Grossmünster in Zürich, zu dem nicht ich sie, sondern sie mich führten. Mit wässrigen Augen erklärten sie mir, in diesem Haus seien Welt verändernde Dinge geschehen. Vor 500 Jahren habe dieses Haus einer Frau gehört, welche ihre Söhne dazu erzogen habe, lieber zu sterben, als sich zu unbiblischen religiösen Ritualen zwingen zu lassen. Damit habe das Zeitalter der modernen Religionsfreiheit begonnen.
Die Gruppe, welche sich damals im Haus von Mama Manz an der Neustadtstrasse 6 bildete, ähnelte in ihren Überzeugungen den Waldensern, Hussiten und anderen Vorreformatoren vor ihnen. Sie wagten es, einander gegenseitig zu taufen. Wie der Chronist berichtet, wurden sie dabei von grosser Angst erfüllt. Tatsächlich hatten sie Grund dazu. Denn die Erwachsenentaufe galt damals in Europa als eine grosse Sünde. Wie eine Tafel erzählt, die noch heute an der Limmat zu finden ist, wurde in der Folge dort Felix Manz tatsächlich am 5. Januar 1527 öffentlich ertränkt, während seine Mutter und sein Bruder ihm zuriefen, standhaft zu bleiben. Die meisten seiner Freunde endeten ähnlich. Aber erst nachdem sie schon Zehntausende getauft und eine Bewegung gestartet hatten, welche nicht mehr zu bremsen war. Zwar stahl man vielen von ihnen Hab und Gut, nahm ihnen die Kinder weg und sperrte sie in Gefängnisse. Doch sie flohen von einem Ort zum anderen. Viele schafften es bis nach Amerika, wo sie eine Freiheit verwirklichten, welche nicht mehr zerstört werden konnte, weil sie gesetzlich verankert wurde.
Das waren die Leute, welche in der Folge an der Ostküste die ersten Staaten der heutigen USA gründeten. Weil die meisten Einwanderer aus verfolgten Freikirchen stammten, fanden sich diese in den neuen Staaten am
Anfang in der Überzahl. Pennsylvania wurde von einem gewissen William Penn gegründet. Er gehörte zur Kirche der Quäker, und diese sammelten sich genauso um ihn, wie die Baptisten in Rhode Island um Roger Williams. Diese Menschen waren es, welche die Reife hatten, die ersten wirklichen Demokratien in der Weltgeschichte zu gründen. In mehreren dieser Staaten herrschte von Anfang an Religionsfreiheit.
Nun erinnern wir uns, dass die Leute, welche die Demokratie erfanden, sie biblisch begründeten. Und wir wiederholen auch, was leider bei Vielen vergessen ging, dass diejenigen, welchen es zum ersten Mal in der Weltgeschichte gelang, echte und dauerhafte Demokratien zu errichten, ebenfalls tiefgläubige Christen waren. Beachte, dass die bedingungslose Religionsfreiheit, welche sie errichteten und die später von da in die amerikanische Verfassung überschwappte, nur möglich war, weil sie sich vom europäischen Ehrendenken distanzierten. Gemäss der Ehrenkultur müsste ja die Ehre eigentlich durch Blutrache wieder hergestellt werden. Gemäss der vorherrschenden Kultur müsste es niemand überraschen, wenn dort Katholiken, Lutheraner und Angehörige anderer Staatskirchen umgebracht oder diese Kirchen wenigstens verboten worden wären, welche doch so viel Elend über jene Anhänger unabhängiger Kirchen gebracht hatten. Doch diese dachten nicht an Rache, weil es ihnen nicht um ihre Ehre ging, sondern darum, das Vorbild Christi nachzuahmen.
Die Zürcher Täufer waren also nicht deswegen weltverändernd, weil sie die ersten gewesen wären, welche Religionsfreiheit beanspruchten. Speziell an ihnen ist aber, dass es ihnen gelang, eine Bewegung auszulösen, die bis heute weiterbesteht. Erst Jahrhunderte später schwappten die freiheitlichen Ideen, welche mittlerweile in Nordamerika längst selbstverständlich geworden waren, auf Europa zurück. Zwar meinen viele Europäer noch heute, dass ihre «Aufklärer» die Freiheit erfunden hätten, und sind deswegen stolz darauf, «aufgeklärt» zu sein. Doch das ist ein peinlicher Irrtum. Nicht die Täufer waren von der «Aufklärung» beeinflusst, sondern umgekehrt. Die Täufer waren schon lange vor der «Aufklärung» mehr als «aufgeklärt»!
Dies, wie wir inzwischen wissen, deswegen, weil die sogenannte Aufklärung nichts Anderes als die Verweltlichung ursprünglich aus der Bibel genommener Standards von Gerechtigkeit war. Auch wenn die Philosophen des 18. Jhd. sich grösstenteils in unvorstellbarem Stolz erhaben fühlten
über alle früheren Zeitalter, welche ihnen als «unaufgeklärt» vorkamen, so scheinen doch überall die christlichen Wurzeln der aufklärerischen Gedanken durch. Manche wie Christian Fürchtegott Gellert und John Locke begründeten ihre ganzen Gedankengebäude offen biblisch, und sogar Voltaire verleugnete nicht, dass er in England entscheidende Impulse erhielt, wo der amerikanische Einfluss bereits spürbar war (Siehe «Briefe aus England»). Und Kant wuchs in einem christlichen Elternhaus auf. Auch wenn er meinte, sich später in Stolz über das Christentum erheben zu müssen, ist nicht zu übersehen, dass sein gesamtes Denken von Voraussetzungen ausgeht, die nur im christlichen Rahmen gelten. Und das gilt für alle «Aufklärer». So ist denn auch nicht verwunderlich, dass die «Aufklärung» nur im christlich vorgeprägten Westen Erfolg hatte. Denn auch wenn die damaligen Landeskirchen wegen ihrer unseligen Verbindung mit den Königen Europas Religionsfreiheit verweigerten, so wurde diese doch implizit von der von ihnen propagierten Bibel gelehrt.
Die Aufklärung ist leider weit über das Ziel hinausgeschossen und hat eine gefährliche Voraussetzung für die nachfolgenden Jahrhunderte geschaffen. Immer unverhohlener ging es Richtung «totale Freiheit» und das führte das moderne Europa zur Schlussfolgerung, alles sei relativ. Mit der Annahme, dass seine Vernunft die einzig Richtige sei, kam ja jeder Philosoph zu anderen Schlüssen. Doch aufgepasst: Wenn alles relativ ist, dann ist nichts mehr garantiert, auch die Religionsfreiheit nicht. Und so kam es wiederum zu absoluten Diktaturen: Nicht die Bibel, sondern die Aufklärung trägt letztlich die Verantwortung für die napoleonischen Kriege, zwei Weltkriege und den grössten Völkermord aller Zeiten, der durch die Kommunisten ausgeführt wurde.
Auf die Dauer wird die Freiheit nur garantiert bleiben, wenn sie absolut begründet werden kann. Wenn sie nur für diejenigen gilt, welche politisch korrekt sind, werden wir sie verlieren. Wenn sie nur für Linke oder nur für Rechte, oder nur für die Mitte gilt, ist sie verloren. Doch wieso sollte Freiheit für diejenigen gelten, welche falsch liegen? Das scheint nicht logisch. Da machen viele Menschen nicht mehr mit. Eine solche Feindesliebe gibt es auf die Dauer nur bei Gott. Und wenn wir von Gott wegkommen, werden wir die Freiheit im Namen der Logik verlieren, denn man wird es sich früher oder später wiederum erlauben, Andersdenkende gewaltsam zum Schweigen zum bringen. So ist der Mensch, wenn man ihn sich selber überlässt.
Jede Religion, jede Philosophie und jeder Mensch tendiert dazu, sich selber absolut zu setzen. Darum fehlt es an Toleranz. Die Gegenreaktion, alles zu relativieren ist aber nur eine Scheinlösung, weil wir damit im Chaos versinken. Auch die Bibel lehrt eine absolute Wahrheit. Mit dem Vorbild von Jesus und den Aposteln lehrt sie aber zugleich die Freiheit, daran zu glauben oder nicht. Nur wer an einen allmächtigen Gott glaubt, der letztlich alles wieder in Ordnung bringen wird, kann es sich leisten, den Anderen die Freiheit zu lassen, ihre eigenen Ideen auszuprobieren. Nur wer sicher ist, dass alles andere schief gehen wird, kann warten, bis es von selber soweit kommt und sich die Wahrheit automatisch durchsetzt.
Bild: unsplash / Drew Hays
History changer
In Kapitel 1C) haben wir schon kurz besprochen, weshalb keiner anderen Kultur je ein bleibender wissenschaftlicher Durchbruch gelang. Neun Bedingungen haben wir dort notiert, welche in Europa alle durch den Einfluss der Bibel tatsächlich direkt oder indirekt geschaffen wurden. Inzwischen haben wir uns ausführlicher mit dem Problem der Ehren- und Respektkulturen beschäftigt. Nun wissen wir, dass Ehrenkultur und Wissenschaft unversöhnliche Feinde sind. Sobald Erkenntnisse früherer Generationen absolut gesetzt werden, sind wir in einer Sackgasse gelandet. Es ist dann nicht mehr möglich, etwas Neues zu sagen, zumal Ehrenkulturen dazu tendieren, sehr gewalttätig intolerant zu sein.
In 2.1.C) haben wir ein weiteres Problem der Ehrenkulturen besprochen. Einerseits scheint es schön zu sein, wie da Familie gelebt wird. Doch der Zusammenhalt basiert letztlich auf Zwang. Die Einzelnen werden sowohl mit Güte als auch Gewalt zur Erfüllung ihrer Pflicht gebracht. Falls jemand nicht pariert, wird ihm nicht nur die Liebe entzogen. Er wird sogar als Schandfleck gesehen und ist seines Lebens nicht mehr sicher. Um nicht in Unehre zu fallen, ist jedes Unrecht erlaubt, solange es hilft, die peinliche Wahrheit zu verstecken.
Auf so einer Grundlage sind weder Menschenrechte noch Wissenschaft möglich. Und hier kamen wir zur zehnten Bedingung dafür, dass Wissen-
schaft überhaupt möglich ist: Die Erfindung des Individuums, d.h. dass die Menschen nicht mehr gemäss ihrer Stellung unterschiedlich bewertet werden. Nur wenn die Menschen als gleichwertig gesehen werden, ist echte Wissenschaft möglich. Solange die Aussage des Einen mehr zählt als die des Anderen, sind wir blockiert. Wenn ich heute beobachte, dass die Spinne acht Beine hat, dann darf ich Aristoteles widersprechen, der behauptete, sie habe nur sechs, egal wer oder was ich bin, weil es weder um Aristoteles noch um mich geht, sondern um Fakten.
In Kapitel 2.2. haben wir gesehen, warum die Menschen sich weltweit von den Lügen der Ehrenkulturen blenden und verführen lassen: Weil zutiefst in uns das Verlangen steckt, geehrt und über Andere gestellt zu werden. Wir geniessen es, aufzusteigen und auf andere runterzuschauen. Weil wir es lieben, geehrt zu werden, entspricht die Ehrenkultur wie keine andere dem natürlichen Wesen des Menschen. Automatisch und gerne stellen wir uns und unsere Familie, bzw. unseren Stamm über alle anderen und erlauben uns zu tun, was wir jenen nie erlauben würden. Ein Leben lang gleichwertig zu bleiben, ist dagegen ziemlich unnatürlich. Um die gleichen Menschenrechte für alle, Demokratie und Sozialstaat zu gewähren, müssen wir uns überwinden. Das benötigt viel Aufwand.
Es benötigt viele Schritte. Und genau derartige Schritte haben wir dann in 2.2.C) beobachtet. In der Geschichte Europas finden sich viele Bewegungen hin zur Demut, zur Gleichwertigkeit, zur Hilfe für den Schwachen. Tatsächlich gäbe es noch viel mehr als wir aufgeschrieben haben. Auf den ersten Blick mag es so aussehen, als ob diese spontan entstanden seien. Doch wenn man genauer hinschaut, findet man eine gemeinsame Wurzel. Der Ursprung - direkt oder indirekt - lässt sich letztlich fast immer auf eine Inspiration durch das Leben Jesu zurückführen.
Die Entdeckung des Wertes des Einzelmenschen - unabhängig von Geschlecht und Stellung - und die Überwindung des blindes Respektes führen vor allem zu einem Resultat: Dass man die Dinge so sieht, wie sie wirklich sind. Ich kann z.B. nun meinen Nachbarn als das sehen, was er wirklich ist, während ich ihn zuvor nur als Angehörigen einer bestimmten Rasse sah. Die Natur, welche zuvor hauptsächlich als ein diffuser gefährlicher Wohnort rachsüchtiger Dämonen wahrgenommen wurde, wurde nun in ihren Einzelteilen beobacht- und zerteilbar. Nur so konnte die Entwicklung der modernen Wissenschaft in Europa überhaupt möglich werden.

Ehrlich gesagt, bin ich kein Fan von Medikamenten. Mein Leben lang habe ich mich fern davon gehalten. Als ich aber meine grosse Herzkrise erlitt und mein Leben an einem Faden hing, da war ich dann doch sehr dankbar für die Medikamente, welche mir im Spital gegeben wurden. Tatsächlich habe ich allen Grund, dankbar zu sein, denn es ist keineswegs selbstverständlich, dass es derartige Medikamente überhaupt gibt und dass sie bezahlbar sind. Vorher lebten die Menschen weniger lang. Zur Zeit der Römer sollen die Menschen durchschnittlich nur 25 Jahre alt geworden sein, im Mittelalter dann immerhin 35. Dafür gibt es auch andere Gründe. Aber die fehlende Medizin hat ebenfalls dazu beigetragen.
Natürlich sind auch unsere Medikamente eine Folge der wissenschaftlichen Revolution. Und ich danke Gott für meine tägliche Portion Medikamente, denn ich weiss, dass es diese ohne die Bibel nie gegeben hätte, auch wenn der Zusammenhang - wie wir bereits zur Genüge besprochen haben - indirekt ist, so ist er doch letztlich nicht abzustreiten.
Nicht selbstverständlich ist zudem, dass es überhaupt ein Spital gibt. Tatsächlich ist auch diese Institution noch nicht sehr alt. Früher musste man den Arzt zu sich nach Hause rufen zur Behandlung, wenn man nicht mehr in seine Praxis gehen konnte. Aber die Pflege der Kranken war natürlich der eigenen Familie überlassen. Niemand wäre auf die Idee gekommen, das auszulagern. Arme starben oft an einfachen Krankheiten, weil ganz einfach die Mittel fehlten. Durch Krankheit konnte man Haus und Hof verlieren und auf der Strasse landen.
Nicht nur Franz von Assisi, sondern auch Petrus Waldes kamen durch das Studium der Bibel auf die Idee, sich aus weltlichen Berufen zurückzuziehen und sich um die Kranken zu kümmern. Doch sie waren keineswegs die Ersten, die das taten. Eine der Haupttätigkeiten von christlichen Mönchen und Nonnen ist seit Urzeiten die Krankenpflege. Das ist keineswegs selbstverständlich. Bei Mönchen anderer Religionen - soweit es sie überhaupt gibt – ist das unüblich. Es ist eine direkte Folge dessen, dass Jesus selber sich zu allererst um die Kranken und Schwachen bemühte und dazu aufgerufen hat, seinem Beispiel zu folgen.
Die Klöster hatten nicht nur eine wichtige Aufgabe in der Übersetzung und Bewahrung medizinischen Wissens. Die von Benedikt von Nursia verfassten Regeln, die spätestens ab dem 8. Jahrhundert für alle westlichen Klöster galten, regeln an zentraler Stelle den Umgang mit Kranken. Ich zitiere aus Kapitel 36, ab Absatz 17 unter der Überschrift «Die Kranken Brüder» : «Die Sorge für die Kranken muss vor und über allem stehen: man soll ihnen so dienen, als wären sie wirklich Christus; hat er doch gesagt: ‚Ich war krank, und ihr habt mich besucht’, und: ‚Was ihr einem dieser Geringsten getan habt, das habt ihr mir getan’[18]. Diese Stelle geht auf das 25. Kapitel des Matthäusevangeliums zurück, wonach der Menschensohn als Richter die Gerechten in das Reich des Vaters aufnimmt: «Denn ich war hungrig und ihr habt mir zu essen gegeben; ich war durstig und ihr habt mir zu trinken gegeben […]; ich war krank, und ihr habt mich besucht […]. Was ihr einem meiner geringsten Brüder getan habt, das habt ihr mir getan»[19]. Damit ist klar, dass es nicht nur zu den Aufgaben eines Mönches, sondern zu denen eines jeden Christen gehört, einem Bedürftigen zu helfen, weil sich hinter jedem Armen und Kranken Christus selbst verbirgt
Unzählige christliche Nonnen und Mönche, Diakonissinnen und Diakone haben im Laufe der Jahrhunderte Gott gedient, indem sie sich ganz den Kranken widmeten. Da macht die Idee, ledig zu bleiben, auch Sinn, denn wer eine Familie hat, benötigt viel mehr zum Leben und kann nur sehr begrenzt anderen helfen. Darum nennt der Volksmund bis heute die Pflegerinnen «Krankenschwestern». Die ersten Spitäler sind aus Klöstern entstanden. Später wurden sie verweltlicht und man änderte die Namen. Doch das ändert nichts daran, dass es ohne die Bibel diese Spitäler gar nicht gäbe, schon alleine aus dem Grund, dass in keiner anderen Kultur etwas Derartiges je erfunden wurde.
Als wir im Libanon waren, wurde eines Tages direkt vor unserem Haus ein Schulkind von einem Auto überfahren. Sofort wurde der verletzte Junge ins Spital gebracht. Doch die Spitalverwaltung verlangte eine Vorauszahlung. Da die Eltern nicht da waren und auch sonst niemand Geld dabei hatte, wurde das Kind nicht aufgenommen. Man musste zu einem anderen Spital fahren. Als endlich eine Klinik gefunden wurde, die bereit war, den Verletzten zu behandeln, war es schon zu spät. Er war nicht mehr zu retten.
Auch heute noch können in armen Ländern viele Menschen nur dank der Aufopferung von Nonnen, Mönchen und Missionaren gepflegt werden. In und vor weltlichen Spitälern sterben dagegen Unzählige, weil sie nicht bezahlen können. Aus Klöstern entstanden nicht nur Schulen und Universitäten, sondern auch Spitäler. Da wurden die Menschen gepflegt, die es sich nicht leisten können.
In der modernen Welt hat der Staat die Aufgabe der Krankenpflege übernommen. Doch das funktioniert nur in wohlhabenden Ländern einigermassen. Andernorts ist das Elend immer noch unvorstellbar. Krankenpflege ist teuer. Auch in der modernen Welt. Die Krankenkasse, die wir bezahlen, kostet immer mehr. Das Mönchstum ist im Westen hauptsächlich aus dem Grund zurückgegangen, dass es nicht Sinn macht, sein Leben für einen Dienst zu geben, den der Staat bezahlen kann. Doch sollte der Westen seinen Wohlstand verlieren und die Krankenpflege unbezahlbar werden, würde die Sache plötzlich wieder ganz anders aussehen. Plötzlich würden wir wieder nach Nonnen und Mönchen rufen.
Während die Welt langsam den Wert der Bibel erkennt (weltweit nimmt die Zahl begeisterter Jesusjünger zu), verachtet Europa sie seit einiger Zeit, insbesondere weil der Eindruck entstanden ist, dass es eine blutige und gewalttätige Religion sei. Tatsächlich finden sich in der Geschichte unseres Kontinentes jede Menge Kriege und Gewalt, sogar auch im Namen des Christentums. Doch wer deswegen glaubt, dass diese Religion blutrünstig sei, sollte zuerst vier entscheidende Fakten beachten. Zum einen, dass es nichts, aber auch gar nichts im Leben von Jesus gibt, das zu Blutvergiessen ermutigt. Zweitens, dass Gewalt im Namen des Christus nicht der Fehler der Bibel, sondern derjenigen ist, welche sich zwar Christen nannten, aber unabhängig von Christus handelten, drittens, dass nicht nur die Geschichte Europas, sondern der ganzen Welt blutig ist, und viertens, dass es ohne die Bibel in Europa noch viel mehr Gewalt gegeben hätte. In Wirklichkeit haben wir modernen Europäer das riesige Vorrecht, in einer unglaublich befriedeten Kultur zu leben, wofür wir auch weltweit beneidet werden. Und dafür sollten wir nicht der «Aufklärung», sondern eigentlich der Bibel dankbar sein. Denn sie ist der Grund dafür. Bedenken Sie: In den meisten Kulturen gilt Blutvergiessen als völlig normal und so war es auch bei den Urvölkern unseres Kontinentes. Wenn wir heute meinen, das Christentum wegen seiner Blutspur verurteilen zu müssen, sollten wir bedenken, dass die Idee der Ablehnung von Gewalt überhaupt erst durch die Bibel nach Europa kam!

Die Kreuzigung ist von Ärzten als die grausamste aller Tötungsarten bezeichnet worden. Nicht die Römer haben sie erfunden. Es gab sie bereits lange zuvor. So liess auch Alexander der Grosse 332 v. Chr. nach der Eroberung von Tyrus (Libanon) 2000 Männer kreuzigen. Nach der endgültigen Niederlage des aufständischen Sklavenheerführers Spartacus 71 v. Chr. wurden um die 6000 seiner Anhänger entlang der Via Appia von Rom bis Capua gekreuzigt. Der römische Feldherr und spätere Kaiser Titus ließ 70 n. Chr. täglich 500 und mehr vor Hunger flüchtende Juden während des jüdischen Krieges vor der Stadtmauer Jerusalems geißeln, foltern und dann kreuzigen, um die Widerstandskraft der Belagerten zu schwächen. Bald wurde laut Josephus sogar Holz wegen der vielen aufgestellten Kreuze knapp. Das Ziel der Kreuzigung war, nicht nur die Leiden, sondern auch die Schande des zum Tode Verurteilten möglichst zu vergrössern.
Als der römische Kaiser Konstantin, den wir schon früher erwähnt haben, zum Christentum konvertierte und es zur bevorzugten Religion des Reiches erhob, erliess er im Jahr 337 n. Chr. eine Gesetzesreform, die die Kreuzigung als Form der Bestrafung abschaffte. Dies geschah vor dem Hintergrund, dass die Kreuzigung Jesu Christi für die Christen ein zentrales Ereignis ihrer Religion war und diese Hinrichtungsart in diesem Kontext als
unwürdig angesehen wurde. Die Abschaffung der Kreuzigung war somit ein Zeichen des Respekts und Anerkennung für das Christentum und ein Schritt zur Stärkung der Moral und Einheit im Römischen Reich.
Derselbe Kaiser erliess auch ein Edikt gegen die Gladiatorenkämpfe, die in den römischen Arenen viele Menschenleben gekostet hatten (325): «In Zeiten, in denen Frieden und innenpolitische Ruhe herrschen, missfallen uns blutige Vorführungen. Deshalb verfügen wir, dass es keine Gladiatoren mehr geben darf. Die, die ihrer Verbrechen wegen früher dazu verurteilt wurden, Gladiatoren zu werden, sollen ab jetzt in den Bergwerken arbeiten. So büßen sie die Strafe für ihre Verbrechen, ohne ihr Blut vergießen zu müssen.»
Kreuzigung und tödliche Gladiatorenkämpfe waren leider keineswegs die einzigen kulturell akzeptablen Mordarten in der alten Welt. Ein weiteres Übel war das Töten oder Aussetzen von Neugeborenen. Der Infantizid war in der antiken griechisch-römischen Gesellschaft «erschreckend normal». (20) Besonders gefährdet waren kranke, schwache, missgebildete oder auch uneheliche Säuglinge. Manchmal wurden sie auch Göttern dargebracht. Plutarch (46-120) beschreibt die Opferung von Neugeborenen bei den Karthagern. Dazu sollen reiche Leute Kinder von Armen gekauft und ihnen die Kehle aufgeschlitzt haben, als seien sie Lämmer oder Vögel. Im römischen sogenannten Zwölffingergesetz wurde sogar befohlen: «Missgebildete Säuglinge soll man töten». (21) In Griechenland war der Kindesmord zeitweise so verbreitet, dass der Geschichtsschreiber Polybius (um 200-118 v. Chr.) erklärte, die Gesamtbevölkerung sei deswegen geschrumpft. Viele Familien wollten z.B. nicht mehr als eine Tochter aufziehen, weil Mädchen als minderwertig galten.
Kindestötung war übrigens ein weltweites Phänomen. Man findet es in Indien, China, Japan, bei den Urvölkern des Amazonas und sogar bei den Eskimos. (22) Es war genauso üblich in grossen Teilen Afrikas wie auch bei den Indianern von Nord- und Südamerika. (23)
Wer es nicht übers Herz brachte, sein Baby direkt umzubringen, der setzte es aus, typischerweise vor Tempeln oder auf Marktplätzen. Da gab es eine gewisse Hoffnung, dass sie von Ammen gestillt und irgendwie am Leben erhalten wurden. Ein Historiker schreibt, dass «das Aussetzen von Kindern ein Teil des Standardrepertoires römischer Laster war.» (24)
In den griechischen Sagen spiegelt sich das Aussetzen und überraschendes Überleben mancher dieser Kinder. So sollen Ödipus, Ion (der Gründer von Ionien), Aeskulap, Hephaistos und sogar Paris, der den berühmten trojanischen Krieg auslöste, Findelkinder gewesen sein. Ein Autor des 5. Jhds. v. Chr. erzählt, dass Neugeborene in Flüsse und auf Misthaufen geworfen, oder an Strassenrändern den wilden Tieren zum Frass hingelegt wurden. In Sparta, so wird überliefert, mussten Neugeborene vor die Ältesten des Stammes gebracht werden, welche dann entschieden, ob die Eltern das Kind behalten dürfen oder es aussetzen müssen. (25)
Die alte Welt hatte kein Problem damit, Leben, das in ihren Augen minderwertig erschien, auszulöschen. Doch eines Tages wurde unter den Sklaven einer gekreuzigt, von dem zu spät erkannt wurde, dass er keineswegs minderwertig, sondern in Wirklichkeit der einzige Himmelssohn war, der jemals über diese Erde gegangen ist. Von da an respektierten seine Jünger jeden Verachteten, denn sie sahen ihren Herrn in ihm. Sie wurden immer zahlreicher, und als sie das römische Reich eroberten, wurden nicht nur die Kreuzigung, sondern auch die blutigen Gladiatorenkämpfe in den Arenen abgeschafft. Es wurde verpönt, Neugeborene zu verkaufen, zu opfern, umzubringen oder auszusetzen.
Stellen wir uns mal vor, das Christentum wäre nicht nach Europa gekommen. Dann würden wir uns immer noch damit vergnügen, dass andere sich gegenseitig abschlachten. Wir würden es normal finden, dass Verbrecher gekreuzigt werden, insofern sie Sklaven sind. Und wir würden einen Teil unserer Kinder umkommen lassen oder gar selber umbringen, weil es einfach das ist, was alle anderen auch tun.
20) Frederic Farrar, The Early Days of Christianity, New York, A.L.Burt Publishers, 1882, S.71
21) De Legibus 3,8
22) Susan C.M.Scrimshaw, Infanticide in Human Populations: Societal and Individual Concerns, in: Infanticide: Comparative and Evolutionary Perspectives, ed. Glenn Hausfater und Sarah Hrdy, New York, Aldine Publishing, 1984, S.439.
23) James S. Dennis, Social Evils of the Non-Christian World, New York, Fleming H. Revell, 1898, S. 69f.
24) John Boswell, The Kindness of Strangers: The Abandonment of Children in Western Europe from the Late Antiquity to the Renaissance, New York, Pantheon Books, 1988, S.4
25) Kenneth J. Freeman, Schools of Hellas, London, Macmillan, 1922, S.13

Daniel Crusoe erzählt in seinem Roman «Robinson», wie Eingeborene plötzlich auf seiner einsamen Insel auftauchen, um einen Gefangenen zu opfern und zu verspeisen. Das war nicht einfach nur eine phantastische Erfindung. Die Kopfjagd wurde tatsächlich bis ins 20. Jahrhundert noch bei einigen Völkern in Südostasien, Westafrika, Südamerika, Melanesien und Taiwan betrieben. (26) Ein Beispiel erzählt Don Richardson, der in West-Irian unter den Sawi lebte. Sie waren Kopfjäger und Kannibalen, die die Schädel ihrer Opfer als Kopfkissen benutzten. (27)
Dahinter steckten meist religiöse Motivationen. So erklärt beispielsweise «nationalgeographic.de»: (28) «Die präkolumbischen Hochkulturen sind für ihre rituellen Menschenopfer bekannt. Ob Inka, Maya oder Chimú-Kultur: Sie alle töteten Menschen, um die Götter zu beschwichtigen – oftmals Kinder, in teilweise blutigen Ritualen.» Oder: «Menschenopfer der Inka: Im Rahmen des Opferritus Capacocha, der im Inka-Reich eine bedeutende Rolle spielte, wurden hauptsächlich Kinder und Tiere geopfert». (29) Die History changer
Azteken glaubten, dass die Welt schon einige Male untergegangen sei, weil die Götter mit zu wenig Menschenblut unterstützt worden seien, und dass dies nun die letzte Chance sei. Sie versuchten also mit regelmässigen Menschenopfern, die sie auf ihren Pyramiden darbrachten, die Welt zu retten.
Tatsächlich gibt es viele Indizien, dass Vergleichbares einst auch in Europa geschah. Julius Cäsar schrieb über die Kelten, dass sie Menschenopfer darbrachten, wenn sie sich in Lebensgefahr befanden. Sie glaubten nämlich, «die unsterblichen Götter könnten nur besänftigt werden, wenn man für das Leben eines Menschen wiederum ein Menschenleben darbringe.» (30) Auch in anderen Berichten werden derartige Opfer erwähnt (Strabon, Lucanus, Berner Scholien, Grammaticus). (31) «Die Menschenopfer zogen sich bei den Germanen bis etwa 1100 n.Chr.» (32)
Wenn alle anderen Opfer nichts mehr nützen, dann greift man zum Menschenopfer, weil es stärker erscheint. Darin liegt eine gewisse Logik. Doch das Christentum lehrt, dass Jesus ein perfektes Opfer dargebracht habe, so dass das Opfer von anderen Menschen weder nötig noch sinnvoll erscheint. So hören denn die Menschenopfer auch überall, wo das Christentum hinkommt, automatisch auf. Anders gesagt: Wenn die Bibel nicht nach Europa gekommen wäre, so würden wir wohl heute noch Menschenopfer darbringen.
26) http://www.lard.net/headhunters.html
27) Don Richardson, Friedenskind, VLM, Bad Liebenzell, 1979, ISBN 3 88002 088 4
28) Artikel vom 14. Juni 2024 mit dem Titel: «Menschenopfer: Maya in Chichén Itzà töteten vor allem männliche Kinder.»
29) nationalgeographic.de vom 3. Nov. 2023
30) Caesar, Bellum Gallicum, VI,16
31) Für Details siehe: https://books.google.ch/books?id=PUjiDAAAQBAJ&printsec=frontcover&hl=de#v=onepage&q&f=false
Franz Wegener «Kelten, Hexen, Holocaust. Menschenopfer in Deutschland»
32) Ebenda S.16

Bild: pexels / cottonbro studio
History changer
Die UNO zählt jedes Jahr zirka 5000 Ehrenmorde. Das bedeutet, dass jeden Tag irgendwo auf der Welt durchschnittlich 14 Frauen von ihren eigenen Familien umgebracht werden. In Wirklichkeit sind es leider noch viel mehr, ja wohl ein Vielfaches davon, da viele Ehrenmorde als Unfälle oder Selbstmorde getarnt werden. Zudem ist weiter zu beachten, dass die Beseitigung von Frauen, die ihren guten Ruf verloren haben, nur eine von verschiedenen Arten von Ehrenmord sind. Zusätzlich gibt es auch die Blutrache, bei der dann meistens Männer getötet werden. Die Blutrache kann sich zudem auf Volksebene auswirken, so dass Kriege über viele Generationen immer wieder aufflammen oder aus Ehrengründen mittels Terroranschläge weiter gezogen werden.
Bei Ehrenselbstmord tötet die Person, die in Schande gefallen ist, sich selber. Dabei gibt es zwei Möglichkeiten: Es kann sein, dass er dies aus eigenem Antrieb tut, weil er denkt, mit diesem schwarzen Fleck könne er nicht mehr weiter leben. Andererseits ist es aber auch möglich, dass man ihn dazu gezwungen hat. Weiter sind auch die Selbstmordattentate zu zählen, welche dadurch motiviert werden, dass der Täter glaubt, sich
ewige Ehre zu verdienen. Dabei reisst er viele Unschuldige, nicht selten auch Frauen und Kinder, mit in den Tod. Beim Beleidigungsmord werden
Menschen getötet, weil ihre Aussagen einen Politiker oder eine Religion beleidigt haben sollen.
Verschiedene Ehrenkulturen entwickeln zudem ihre eigenen Ehrenmorde. So soll trotz staatlichem Verbot in der hinduistischen Kriegerkaste die sogenannte Sati vereinzelt bis zum heutigen Tag weiter praktiziert werden, wo von der Witwe eines Kriegers erwartet wird, sich bei der Verbrennung ihres Mannes selber in die Flammen zu stürzen. In Indien werden zudem auch Menschen umgebracht, weil sie über die Kastengrenzen hinaus geheiratet haben.
In den islamischen Hadithen werden nicht nur die Steinigung, sondern auch der Mord an Ex-Muslimen befürwortet. Im Koran selber gibt es den Befehl zur Blutrache: «Vorgeschrieben ist euch die Wiedervergeltung: Ein Freier für einen Freien, ein Sklave für einen Sklaven, eine Frau für eine Frau» (Sure 2:178). Zwar wird danach erwähnt, dass es auch möglich sei, die Sache mit Geld zu bereinigen. Doch vorgeschrieben wird nicht diese Lösung, sondern der Rachemord. Schon allein aus diesem Grund ist es nicht erstaunlich, dass Ehrenmorde im Islam besonders verbreitet sind. Dazu trägt noch bei, dass der Koran sowieso eine starke Ehrenkultur begründet. In der Praxis herrschen dann in der islamischen Welt vielfach die einflussreichen Clans über die Schwächeren. Gerechtigkeit gibt es auf diese Weise nicht.
Jesus hat Ehrenmorde direkt verhindert. Das können wir an einem Beispiel aus Johannes 8 sehen. Damals brachten die Juden eine Frau zu ihm, weil sie beim Ehebruch erwischt worden war. Und gemäss dem Gesetz des Moses gilt selbstverständlich, dass eine solche Frau gesteinigt werden muss. Das war natürlich eine sehr heikle Situation für Jesus, denn wenn er sich gegen das Gesetz des Moses stellte, hätte er sich unter den Juden zum Aussenseiter gemacht und seine ganze Glaubwürdigkeit verloren.
Andererseits: Konnte er einfach zuschauen, wie die Frau vor seinen Augen umgebracht wurde?
Seine Reaktion war genial. Sie kennen die Geschichte schon: Während er im Sand herum stocherte, erklärte er: «Wer ohne Sünde ist, werfe den ersten Stein». Er erhob sich also nicht über Moses, noch verteidigte er ihn.
Noch erhob er sich über die Ankläger. Er hielt den Leuten einfach einen Spiegel vor und liess sie selber entscheiden. Letztlich weiss jeder Mensch irgendwo im Hinterkopf, dass er genauso schuldig vor Gott ist wie die Anderen, und darum eigentlich keiner das Recht hätte, über jene zu richten. Doch eben, ehrlich gesagt, es fällt uns nichts so leicht wie das Verurteilen.
Und das drückt sich eben in Ehrenkulturen noch viel extremer aus, bis hin zur Vernichtung. Doch damit hat Jesus gründlich aufgeräumt. Ehrenmord hört dort auf, wo Christus einzieht.
Wenn die Botschaft von Jesus nie nach Europa gekommen wäre, so würden wir wohl heute noch in ständiger Angst vor Ehrenmord leben.

«Eigentlich weiss ja jedes Kind, dass man niemanden töten darf.» So hört man die Leute reden. Doch stimmt es auch? Ganz und gar nicht. Das habe ich sogar in meinem eigenen Leben gesehen. Als Kind hatte ich eine ganze Menge Plastikfiguren, mit denen ich Indianer und Cowboy spielte. Dabei liess ich regelmässig die Urweinwohner gewinnen und alle Weissen sterben. Das empfand ich damals gemäss meinen Geschichtskenntnissen als gut und gerecht. History changer
Kennen Sie das Märchen von Hänsel und Gretel? Wenn es Hänsel gelingt, die Gretel zu retten, indem er die böse Hexe in den Feuerofen stösst, so hat kein Kind Mühe damit, höchstens wir Erwachsenen.
Tatsächlich werden Kinder in den meisten Kulturen dazu erzogen, dass es Situationen gibt, in denen es sogar eine Pflicht ist, zu töten. Ein Soldat, der sein Leben einsetzt, um die Schwachen zu schützen, wird hoch geehrt. Als die grössten Helden der Geschichte gelten häufig diejenigen, die am meisten Kriege geführt und viele Länder erobert haben: Alexander der Grosse, Julius Cäsar, Napoleon, Hitler.
Die meisten Völker waren und sind stolz auf ihre Siege im Krieg. So werden auch in der vielleicht berühmtesten Erzählung der alten Griechen über den trojanischen Krieg vielfache Mörder als Helden dargestellt. Sogar die Götter lügen und betrügen, vergewaltigen und morden Unschuldige. Es lässt tief blicken, dass diese Geschichten zu den beliebtesten der Menschheit gehören!
Gemäss der Bibel ist Jesus Gottes Sohn. Er hätte sich also keineswegs kreuzigen lassen müssen. Es wäre ihm ein Leichtes gewesen, himmlische Mächte zu Hilfe zu rufen und alle seine Feinde in einem Augenblick umbringen zu lassen. Das war es, was das Volk von ihm erwartete. Und mehr noch: Sie wollten, dass er sie blutig von der römischen Bedrückung befreie. Gerade deswegen jubelten sie ihm bei seinem Einzug in Jerusalem am Palmsonntag begeistert zu. Als sie aber merkten, dass er keine politischen Absichten hatte, wurden sie innerhalb einer Woche derart zornig über ihn, dass sie seinen Tod forderten. Doch der grösste Held der Bibel kam nicht um zu töten, sondern «um sein Leben als Lösegeld für viele zu geben.»
Seither sind nicht mehr Mörder, sondern Märtyrer die Helden des Christentums. Seit dem ersten Blutzeugen Stephanus (siehe Apostelgeschichte Kapitel 7) kennt jede Kirche ihre Märtyrer. Während im Islam alle als Märtyrer bezeichnet werden, die im Krieg ums Leben kommen, wird das Wort von Christen viel sparsamer gebraucht. Ein Soldat, der für das Christentum kämpfend stirbt, gilt nicht als Märtyrer. Nur wer wie Jesus bis zum unschuldigen Tod seinem Glauben nicht abschwört, darf diesen Titel tragen.
Es ist ein grosser Unterschied, ob mein grosses Vorbild jemand ist, der mit Lug, Trug und Muskelkraft viele Feinde getötet hat, oder jemand, der durch sein Leiden Gutes bewirkte. Das biblische Motiv der Selbstaufopfe -
rung, allenfalls sogar Auferstehung nach dieser Opferung, hat sich in modernen Bestsellern wie den Narnia Geschichten, Herr der Ringe, König der Löwen, ET etc. verweltlicht und ist in unserer Kultur stark wirksam. Dieser Wechsel, nicht mehr den Beherrscher-Helden, sondern den physisch Unterlegenen, aber moralisch Überlegenen als den wahren Helden zu sehen, hat sehr zur Befriedung Europas beigetragen.
Anstatt das Christentum als unglaubwürdig zu erklären, weil Staatskirchen unter unbiblischem Einfluss zeitweise Andersdenkende verfolgten, sollten wir beachten, dass die Verfolgten meistens Bibelgläubige waren. Bis heute sterben Christen für ihren Glauben in kommunistischen, diktatorischen, islamischen und hinduistischen Verfolgungen. Im wahren Christentum wird also Schwachheit anstatt Gewaltherrschaft nicht nur ermöglicht, sondern gilt sogar als vorbildlich. Daher ist die positive Darstellung von Schwachheit sogar in der westlichen weltlichen Literatur selbstverständlich geworden. Das ist in vielen Kulturen bis heute praktisch undenkbar.
History changer

History changer
Am Anfang dieses Buches haben wir im Kapitel 1D) bereits schon beobachtet, dass die Sklaverei nicht von Christen erfunden, wohl aber zeitweise übernommen wurde. Was die meisten Menschen übersehen, ist, dass wir heute ein weltweites Verbot der Sklaverei haben, weil Christen dies, ausgehend von Rhode Island und England, schlussendlich mit biblischer Begründung durchgesetzt haben. Die zentrale Geschichte des AT ist ja, dass Gott ein dem Untergang geweihtes Volk von Sklaven zu seinem Eigentum erwählt und gegen alle Wahrscheinlichkeit rettet. Das NT dagegen schildert uns Jesus, durch den Gott sich so sehr mit den Armen, Ausgestossenen, Verachteten und scheinbar Wertlosen identifiziert, dass er selber einer von ihnen wird. Nur Sklaven konnten überhaupt gekreuzigt werden. Einen Gott, der sich derart mit Sklaven identifiziert, hat es nie zuvor gegeben in der Weltgeschichte. Es ist phänomenal. Auch wenn es nach wie vor Ausbeutung und versteckte Sklaverei gibt, ist das doch in keinem Vergleich zu dem, was früher normal war. Die Auswirkungen dieses Verbotes habe ich selber beobachtet, als ich fünf Jahre in Ägypten lebte. In alten ägyptischen Filmen kann man sehen, dass in jeder noblen muslimischen Familie mindestens ein afrikanischer Sklave dazugehörte. Ich wunderte mich immer, wie das möglich sei, dass diese in jenen streng konservativen
Familien ein und aus gingen, wo doch sonst ein Mann keinen Moment zugelassen wurde. Erst als ich hörte, dass die Sklaven zuerst kastriert wurden (wobei 2/3 daran starben), löste sich das Rätsel.
Heute gibt es derartige Sklaven in Ägypten nicht mehr (leider allerdings im Sudan und einigen anderen arabischen Ländern schon), obwohl es ja im Islam selber keinen Grund gäbe, sie abzuschaffen, da Mohammed selber Menschen versklavte und verkaufte, wie nicht nur seine Biographie, sondern auch das Schariagesetz lehren. Es waren die Engländer welche einst die arabische Welt zwangen, gegen die Sklaverei vorzugehen.

Jesus hat keine Menschen getötet, obwohl er durchaus Grund dazu gehabt hätte. Die Evangelien schildern die Bosheit seiner Mitmenschen. Stattdessen hat er Tote auferweckt. Er lehrte Vergebung, die Liebe zu Feinden sowie Verfluchungen mit Segnungen zu erwidern. Und er liess sich widerstandslos ans Kreuz nageln. Soweit sich das nachvollziehen lässt, sind auch elf von seinen zwölf Aposteln als Märtyrer gestorben. Sein Vorbild hat dazu geführt, dass die Christen während mehr als 300 Jahren pazifistisch lebten. Obwohl sie nicht nur von den Juden, sondern auch von den Römern teilweise aufs Brutalste verfolgt wurden, wehrten sie sich nicht. Es war diese Bewegung, welche schlussendlich das Römerreich
überwand und zum Christentum bekehrte. Auch wenn Kaiser Konstantin dann leider Jesus mit einem Kriegsgott verwechselte und das Christentum seine Unschuld verlor, ändert die spätere Entwicklung nichts am Vorbild Jesu. Zu allen Zeiten und bis zum heutigen Tag gibt es pazifistische Jünger Jesu in vielen Orten der Welt.
Ob Jesus wirklich bezweckte, dass man keinen Militärdienst machen soll, oder ob er nur lehrte, seinen Glauben nicht mit Gewalt zu verteidigen, kann man unterschiedlich interpretieren. Aber eines ist klar: Die Menschen, welche Jesus zum Vorbild nehmen, tragen viel zur Befriedung der Welt bei. Schon in der Apostelgeschichte wird uns erzählt, wie der Terrorist Saul bzw. Paulus, dessen Beruf es war, Menschen zu fangen, einzusperren oder umzubringen, zu einem derart friedfertigen Apostel wurde, dass er jede nur erdenkliche Art von Verfolgung auf sich nahm. Ähnliche Berichte gibt es heute von ehemaligen ISIS, Al-Schebab und Hisbollah-Kämpfern.
In Ehrenkulturen sind pazifistische Bewegungen undenkbar. In Europa dagegen gibt es sogar weltlichen Pazifismus. Auch wenn diese Menschen sich dessen nicht bewusst sind, so haben sie ihre Idee indirekt von Jesus übernommen.
Tatsächlich gibt es im AT nicht gerade wenig Blutvergiessen. Wie passt denn das mit dem Pazifismus von Jesus zusammen? Tatsächlich beginnt das AT mit dem Todesurteil über Adam und damit die ganze Menschheit: «Wenn ihr von diesem Baum esst, werdet ihr gewiss sterben.» Und sie assen. Die Sünde bringt das Todesurteil mit sich, denn sie trennt uns von Gott, der das Leben ist. Und das gilt für jeden Menschen. Doch Jesus, der Einzige, der nicht unter diesem Urteil stand, nahm unsere Sünde – und damit unser Todesurteil – weg. Er starb, damit wir leben.
Tatsächlich hätten die Christen noch viel mehr Blutvergiessen verhindern können, wenn sie dem Vorbild von Jesus treu geblieben wären. Das wird uns an einem Erlebnis aus dem Leben des berühmten Pfarrers Karl Barth deutlich. Als er noch jung war, studierte er an der Uni in Deutschland. Da lernte er die vorherrschende liberale Theologie kennen, welche bestrebt ist, das Vorbild von Jesus so weit es geht nicht wörtlich, sondern symbolisch auszulegen. Das gefiel ihm. Doch als der erste Weltkrieg begann, dem er als Schweizer kritisch gegenüber stand, war er völlig verblüfft, dass seine hochverehrten Professoren den Krieg bejahten und rechtfertigten. Nun
wurde ihm bewusst, dass etwas nicht stimmte. Er begann, die Bibel ganz neu zu lesen, indem er sich nicht fragte, wie wir sie umdeuten können, sondern um zu wissen, was sie wirklich sagen will.
Tatsächlich hätten weder der erste noch der zweite Weltkrieg stattfinden müssen, wenn die Kirche bibeltreu gewesen wäre und Widerstand geleistet hätte. Aber mit einer verwässerten Christenheit kann man machen, was man will.

Es benötigt nicht viel, damit die Menschen einander richten. Ein Mensch mag uns unsympathisch sein und schon erfinden wir in unseren Gedankenspielen oder auch mit unseren Zungen alle möglichen Gründe dafür. So entstehen Gerüchte. Jemand mag sich ungewöhnlich kleiden oder nur seine Haare anders färben. Er mag zu einem bestimmten Volk gehören –und schon richten wir ihn in unseren Herzen. Aus puren Vorurteilen sind schon unzählige Morde oder gar Kriege entflammt.
Eine der ersten Aussagen von Jesus war (Matthäus 7:1ff): «Richtet nicht, auf dass ihr nicht gerichtet werdet. Denn wie ihr richtet, werdet ihr gerich-
tet werden; und mit welchem Mass ihr messt, wird euch zugemessen werden. Was siehst du aber den Splitter in deines Bruders Auge und nimmst nicht wahr den Balken in deinem Auge? Oder wie kannst du sagen zu deinem Bruder: Halt, ich will dir den Splitter aus deinem Auge ziehen! –und siehe, ein Balken ist in deinem Auge? Du Heuchler, zieh zuerst den Balken aus deinem Auge; danach kannst du sehen und den Splitter aus deines Bruders Auge ziehen.»
Oder mit anderen Worten: Such den Fehler zuerst bei Dir und dann erst bei den Anderen. Ein Beispiel dazu haben wir bereits schon erwähnt: Der Papst hat sich längst entschuldigt für die Kreuzzüge, die vor tausend Jahren stattfanden, während der türkische Staat die millionenfachen Morde an Christen, die vor hundert Jahren geschahen, nach wie vor leugnet und die Welt beschuldigt, aus antitürkischen Motiven Lügen erfunden zu haben. Dabei waren gerade die Kreuzzüge aus der historischen Situation heraus durchaus verständlich, war doch damals ganz Europa seit Jahrhunderten regelmässig von islamischen Piraten und Sklavenhändlern terrorisiert worden. Was auch immer die Kreuzritter Böses taten, es war nur ein kleiner Teil dessen, was ihnen schon zuvor angetan worden war.
Doch das glaubt der moderne Europäer kaum, denn er ist gelehrt worden, den Fehler zuerst bei sich zu suchen. Wir verurteilen lieber das Christentum als andere Religionen, lieber unsere eigenen Väter als Fremde. Aber das geschieht nirgends sonst auf der Welt. Es ist völlig abnormal. Das Normale ist, die Väter zu ehren und alles Fremde runterzumachen. Letztlich ist diese erstaunliche Denkhaltung das Resultat der Worte von Jesus, die über viele Generationen tief in unser Bewusstsein und sogar unser Unterbewusstsein eingedrungen sind.
Asylsuchende werden in den meisten Ländern dieser Welt allerhöchstens geduldet. Nur in Europa tun manche Staaten ihr Möglichstes, um ihnen die reibungslose Integration zu ermöglichen. Auch wenn die Einwanderer sich anpassen müssen, wird niemandem erlaubt, sie zu verurteilen. Und das geht noch auf andere biblische Worte zurück, die schon lange vor Jesus gesagt wurden (3.Mose 19:33f): «Wenn ein Fremdling bei euch wohnt in eurem Lande, den sollt ihr nicht bedrücken. Er soll bei euch wohnen wie ein Einheimischer unter euch, und du sollst ihn lieben wie dich selbst; denn ihr seid auch Fremdlinge gewesen in Ägyptenland. Ich bin der HERR, euer Gott.»
«Du sollst den Fremden lieben wie dich selbst.» Eine verblüffende Aussage. Aufgeschrieben zu einer Zeit und in einer Kultur, die so fremdenfeindlich war, wie man es sich nur vorstellen kann. Ist das nicht ein gewaltiger Beitrag zur Befriedung dieser Welt?

Bild: pexels / PHILIPPE SERRAND
Die Römer kannten keine Trennung von Religion und Staat. Im Gegenteil, mit der Zeit wurden ihre Kaiser immer mehr zu Göttern. Und darum ging jeder Ansatz zu Demokratie, wie bescheiden auch immer, total wieder verloren. Die Kaiser waren derart beherrschend, dass sie ihren engsten Mitarbeitern mit oder ohne Grund den Selbstmord befehlen konnten und diese ihnen gehorchten. Denn es galt als ein Privileg, sich selber auf relativ schmerzlose Art umbringen zu dürfen, anstatt wie ein Sklave zu Tode gequält zu werden. History changer
Daher ist es auch nicht verwunderlich, dass Kaiser Konstantin und seine Nachfolger das Christentum zur Staatsreligion machten. Sie konnten sich etwas Anderes als Staatsreligion gar nicht vorstellen. Wie wir schon früher festgestellt haben, bedeutet die Geschichte vom Kreuz, das der Kaiser gemäss seinen eigenen Aussagen in den Wolken sah und in der Folge als siegreiches Schlachtzeichen einsetzte, keinen Sieg der Bibel. Einerseits war es auf jeden Fall zu begrüssen, dass Christen fortan nicht mehr verfolgt wurden. Es war angenehm, dass das Christentum staatlich gefördert wurde. Aber es wurde ihm nicht erlaubt, den römischen Staat zu hinterfragen. Jesus wurde mehr oder weniger anstelle des Sonnengottes einfach ins römische Denken eingebaut. Nirgends in der Bibel steht etwas vom Papst, der die Kirche von Rom aus regieren soll. Der Bischof von Rom wurde nicht aus religiösen, sondern aus politischen Gründen über alle anderen gestellt, und zwar immer mehr als absoluter Herrscher. Obwohl Jesus deutlich gelehrt und gezeigt hatte, dass sein Reich nicht von dieser Welt sei, wurde die römische Kirche nicht nur ein Teil dieser Welt, sondern wollte auch noch über alle weltlichen Könige herrschen. Zeitweise konnte sogar der deutsche Kaiser sich nur dadurch legitimieren, dass er seine Krone vom Papst aufgesetzt erhielt. Jesus hatte einst seine Jünger gewarnt, das Schwert zu ergreifen, denn: «Wer das Schwert nimmt, wird durch das Schwert umkommen.» Die Päpste dagegen ergriffen das Schwert nicht nur gegen Heiden und Muslime, sondern zuallererst gegen ihre christlichen Mitbrüder, um sich politische Vorteile zu erschaffen. Sie scheuten sich auch nicht, um der Macht willen die echten Jesusjünger zu verurteilen und zu ermorden.
Doch letztlich verlor das Papsttum diesen politischen Kampf. Gerade durch diese Auseinandersetzung wurde der Unterschied zementiert. Während im Islam der Kalif bzw. Sultan als absoluter Herrscher stehen blieb, setzten in Europa die Könige ihre Unabhängigkeit von der Kirche immer mehr durch, bis es dann in der Reformation erst recht zum Bruch kam.
Dabei ist es wichtig zu beobachten, dass die muslimischen Kalifen keineswegs weniger Verbrechen begingen als die «christlichen» Päpste. Der Unterschied ist nur, dass diese dafür nie angeklagt wurden. Mohammed selber hatte ja den Schritt vom Prediger zum Politiker bereits schon vollzogen. Er hatte eigenhändig ungerechte Kriege geführt und Hunderte von Kriegsgefangenen köpfen lassen, während ihre Frauen und Kinder versklavt wurden. Auf welcher Grundlage hätte jemand die Kalifen später für derartige Taten verurteilen wollen?
Jesus dagegen sagte deutlich: «Wäre mein Reich von dieser Welt, so würden meine Jünger kämpfen. Nun aber ist mein Reich nicht von dieser Welt.» Weiter: «Gebt dem Kaiser, was des Kaisers ist, und Gott, was Gottes ist.» Damit hatte er letztlich die Trennung von Kirche und Staat schon angedeutet. Ich erinnere an dieser Stelle daran, dass wir bereits im Judentum eine Abneigung gegen absolute Herrscher gefunden haben. Als das jüdische Volk unbedingt einen König wollte, mit der Begründung, so zu sein wie alle anderen Völker, erklärte Gott: «Mich haben sie verworfen» (1. Samuel 8). Priester und Propheten wurden gemäss den Berichten des AT von Gott selber als Begrenzung der königlichen Macht eingesetzt.
In der europäischen Geschichte waren es von daher nicht überraschend von der Bibel beeinflusste Menschen, welche die Legitimation des politischen Papsttums immer wieder in Frage stellten. Die Vorreformatoren und ihre Anhänger konnten zwar durch Verfolgungen zum Schweigen gebracht werden, doch die Reformatoren hatten deshalb Erfolg, weil sie von den weltlichen Herrschern gestützt wurden. Ohne den Kurfürsten von Sachsen, ohne den Stadtrat von Zürich, ohne die Könige von England, Schweden etc. wäre keine Reformation denkbar. Doch auch sie waren grossenteils von der Bibel dazu motiviert.
Und auch die Reformation war nur eine teilweise Rückkehr zur Bibel. Fortan gab es zwar mehrere Arten von Christentum in Europa, aber immer noch sehr wenig Freiheit. Über Jahrhunderte wurden die Menschen mancherorts genauso zum Protestantismus gezwungen, wie anderswo zum Katholizismus. Dennoch war der Same zu einem freiheitlicheren Denken gesät. Und es sprach auch gar nichts gegen Religionsfreiheit, denn Jesus selber hatte nie jemand gezwungen, ihm nachzufolgen. Als einst viele Menschen weggingen, weil sie seine Worte als «hart» empfanden, liess er sie nicht verfolgen, sondern schien sich eher zu wundern über die, welche geblieben waren (siehe Johannesevangelium 6,66ff).

Wie es in Europa schlussendlich zur totalen Religionsfreiheit kam, haben wir früher bereits schon besprochen. Verschiedene Strömungen haben dazu beigetragen, weltliche genauso wie religiöse. Doch lasst es mich wiederholen: es ist wichtig, zu beachten, dass auch die verweltlichen und literarischen Reformströmungen ohne den biblischen Ursprung nicht denkbar wären. Nirgends sonst auf der Welt ist eine derartige Freiheit entstanden.
Beachte, dass absolute Religionsfreiheit bis heute ein seltenes Gut ist. Es gibt zwar Länder, die sie importiert haben. So etwa Japan. Aber auch in Japan gab es früher Verfolgungen Andersgläubiger. Die Japaner eroberten bis zum zweiten Weltkrieg im Namen ihrer Religion immer mehr asiatische Länder und zwangen die Völker, ihren Kaiser anzubeten. Erst nach dem Zerbruch im zweiten Weltkrieg öffnete sich das Land für freiheitliches Denken, das aus dem Westen inspiriert war.
Den Islam zu verlassen, ist bis heute lebensgefährlich. Dank dem Internet ist es zwar inzwischen möglich, den Islam aus einem Versteck heraus zu kritisieren. Doch Menschenrechtsorganisationen wie Amnesty International oder Open Doors dokumentieren jedes Jahr viele tausend Morde an Ex-Muslimen. Sogar Muslime werden von anderen Muslimen ermordet, weil sie etwas liberaler leben als jene.
Es ist zwar berechtigt, die Verpolitisierung des Christentums in der europäischen Geschichte zu kritisieren, aber dabei darf keineswegs der Eindruck entstehen, dass die Bibel Gewalt nach Europa gebracht habe. Im Gegenteil, diese Gewalt findet sich in allen Religionen weltweit und erst recht dort, wo keine Religion ist. Manche Religionen ermutigen Gewalt, andere warnen, aber so oder so, das Grundproblem liegt im Menschen. Wir sind die Angeklagten, nicht Gott. Jesus hat nicht nur Vergebung, Feindesliebe und Toleranz gelehrt, sondern sie bis zum bitteren Ende vorgelebt. Man stelle sich vor, wie die Menschheit dazu kommt, dieses phantastische pazifistische Vorbild zu einem System umzuformen, das Mord und Totschlag in seinem Namen rechtfertigt, und dass danach dieser selbe Mensch Gott für die Gräuel, die begangen wurden, auch noch anklagt!
Welch eine Katastrophe. Der Mensch will sich selber rechtfertigen und dafür ist er bereit, jede Lüge zu glauben. Aber Tatsache ist, dass die Bibel trotz aller menschlichen Versuche, sie umzudeuten, letztlich einen Frieden nach Europa gebracht hat, wie die Welt ihn nicht kennt. Ohne die Bibel würden wir bis heute noch Kinder umbringen und aussetzen, einander die Frauen stehlen, Sklaven töten, evtl. sogar andere kreuzigen und Menschen opfern. Wir würden es für unsere Pflicht halten, unsere Töchter zu vermeintlich ehrenhaften Ehen zu zwingen, sowie versuchen, durch Blutrache und Ehrenmorde die eingebildete Reinheit unserer Familien wieder herzustellen. Es gäbe weder Menschenrechte noch Demokratie und schon gar keinen Sozialstaat. Dagegen würden wir uns sklavisch bemühen, den Zorn egoistischer Tyrannen abzuleiten, da sie die Macht hätten, jeden von uns jederzeit zu zerstören. Wir würden damit aufwachsen, andere zu verurteilen, und unsere Ehre wäre der Götze, der über allem stünde. Dafür würden wir sogar unser Leben aufs Spiel setzen. Es gäbe keine religiöse Freiheit, vielmehr wäre es unsere Pflicht, alles zu tun, was jene Religion uns befehlen würde, egal wie gross die Kosten sind.
So lebten unsere Vorfahren. Und jeder Versuch zur Veränderung wurde gemäss den Gesetzen der Ehrenkultur als grosse Schande empfunden, bestialisch bestraft und vereitelt.
Niemand hat je einen bleibenden Durchbruch geschafft. Bis die Bibel kam.

Bild: pexels
History changer
Wir haben schon am Anfang dieses Buches (Kapitel 1b) festgestellt, dass die Bibel nicht der Grund ist, weshalb Hexen in Europa verfolgt wurden, sondern vielmehr direkt und indirekt deren Beendigung angeregt hat. Man mag erstaunt sein, zu hören, dass die Kirche derartige Verfolgungen während tausend Jahren verbot. Und genau diese tausend Jahre werden von Unwissenden «das finstere Mittelalter» genannt. Tatsächlich werden bis heute wirkliche oder vermeintliche Hexen weltweit verfolgt. Und das hat durchaus seine Logik. Wenn Hexen und Hexer tatsächlich Menschen sind, welche die Macht haben, Krankheit und Tod über uns zu bringen, dann macht es durchaus Sinn, dass wir versuchen, sie zu stoppen. Würden Sie vielleicht tatenlos zuschauen, wie man Kinder entführt, um sie irgendwo einem Dämonen zu opfern? Es ist nur natürlich, dass man alles versucht, um solche Machenschaften zu verhindern. Doch Christen sind dabei am besten ausgerüstet, um Zauberern friedlich zu begegnen, weil wir ja im Namen von Jesus jeder dämonischen Macht furchtlos gebieten und sie verjagen können. Die Evangelien erzählen eine ganze Reihe von Begegnungen zwischen dem Messias und Besessenen. Die Apostelgeschichte
zeigt, dass auch die ersten Jünger Hexer nicht verfolgten, sondern von Dämonen befreiten. Man könnte erwarten, dass auch Atheisten sich nicht vor Dämonen fürchten. Doch die Realität ist eine andere. Wenn der Dämonenleugner unerwarteten übernatürlichen Phänomenen begegnet, weiss er sich nicht mehr zu helfen. Ein wahrer Christ dagegen wird davon nicht überrascht, da er aus der Bibel weiss, dass es derartige Mächte gibt und dass sie nicht allmächtig sind.
Ohne die Bibel würden wir wohl nach wie vor Hexen verfolgen, denn das ist es, was unsere heidnischen Vorfahren taten und es gibt keinen Grund, anzunehmen, dass es von selber geändert hätte, zumal dieses Phänomen durchaus seine Logik hat und sogar in der modernen Welt in vielen Ländern weiter geschieht.

Bild: pexels / Oscar Ritter
Ein syrischer Asylant, mit dem ich bis heute befreundet bin, hat mich einst darauf aufmerksam gemacht, dass das Rote Kreuz nicht einfach eine Hilfsorganisation wie jede andere ist. Sein Respekt für diese Organisation verblüffte mich. Er kam aus einem Land, in dem Vorurteile und Rassismus mit der Muttermilch eingesaugt werden. Da wurde er völlig überrascht
von einer Organisation, die ihn lehrte, sogar unter Lebensgefahr verhassten Feinden rettende Decken, Nahrungsmittel und Zelte zu bringen.
Tatsächlich hat das Rote Kreuz Millionen von Menschenleben gerettet. Es ist kaum zu glauben: Obwohl seit Urzeiten unzählige Kriege geführt worden waren, hatte bis zum Jahr 1859 kaum jemand ernsthaft daran gedacht, was mit den verwundeten Soldaten geschehen sollte, die nach einer Schlacht hilflos am Boden herumliegen. Nachdem die Armeen aufeinander los gegangen waren, flohen die Einen, während die Anderen den Sieg feierten. Im Laufe der Zeit starben Millionen von Verwundeten - vielfach unnötig. Henry Dunant, der Genfer Kaufmann, welcher an jenem schicksalhaften 24. Juni 1859 völlig unerwartet mitten auf das Schlachtfeld von Solferino geriet, war vielleicht nicht der Erste, der sich über die Verlassenheit der Verletzten entsetzte. Aber im Gegensatz zu vielen Anderen begann er sofort, die Zivilbevölkerung zur Hilfeleistung für die blutenden Soldaten zu motivieren, indem er versprach, alle Kosten zu übernehmen. Doch mehr als das, er gründete in der Folge sogar eine Organisation, die er «Rotes Kreuz» nannte. Diese sollte auf der ganzen Welt in jedem Krieg gegenwärtig sein und neutral zwischen den Fronten operieren können. Es war eine verrückte Idee, an die anfangs niemand glaubte, und deren Umsetzung ihn alles kostete. Aber seine Gedanken waren derart inspirierend, dass in Genf bald unzählige Hilfsorganisationen entstanden, so dass diese kleine unscheinbare Stadt heute de facto die humanitäre Hauptstadt der ganzen Welt genannt werden kann.
Doch was war das Geheimnis von Henry Dunant? Das hervorstechende Merkmal dieses höchst ungewöhnlichen Menschen war seine Neutralität und sein Respekt für das Leben. Sowohl Freunde als auch Feinde, die «Unsrigen» wie auch die «Ihrigen», die «Guten» und die «Bösen» sollten gerettet werden, denn sie alle haben seiner Ansicht nach ein Recht auf Leben. Er machte nie ein Geheimnis daraus, dass er seine Einstellung und Motivation dem Neuen Testament entnommen hatte. Tatsächlich stammte Henry Dunant aus einer tief gläubigen Genfer Familie. Das Rote Kreuz ist effektiv das Resultat einer christlichen Erweckung, die damals in Genf stattgefunden hatte.
Und nicht nur das. Dunant war auch einer der Mitbegründer der schweizerischen evangelischen Allianz. Jesus war sein Vorbild, welcher schon 1800 Jahre zuvor ein Herz für die Kranken und Verachteten, für Versager und Ausgestossene, für Besessene und Verkrüppelte hatte. Dieser lehrte weder
die Steinigung von Ehebrecherinnen noch die Ermordung von Hexen. Vielmehr befreite er sie von ihren schädlichen Kräften und Geistern. Nicht einmal die Juden und Römer, welche ihn einst so undankbar und bösartig behandelten, verfluchte er, sondern vergab und segnete sie noch vom Kreuz herab unter unvorstellbaren Schmerzen.
Heute erscheint es uns selbstverständlich, dass das Rote Kreuz stillschweigend überall auf der Welt, wo ein Konflikt entsteht, zur Stelle ist. Wir unterstützen gerne auch unzählige andere Hilfsorganisationen, welche irgendwo auf diesem Planeten irgendwelchen Not leidenden Menschen oder sogar Tieren helfen. Das war nicht immer so. Früher wurde streng zwischen Freund und Feind unterschieden. Es ist wirklich verblüffend, wie uns Henry Dunant verändert hat. Er musste allerdings hart dafür kämpfen. Um Beziehungen zu Regierungen zu knüpfen und sich Gehör zu verschaffen, reiste er jahrelang in Europa herum. Er hatte keine Zeit, zu heiraten und eine Familie zu gründen. Schliesslich ging ihm das Geld aus. Er fiel in Schulden und wäre beinahe ins Gefängnis gekommen.
«Ein reiner und unbefleckter Gottesdienst vor Gott, dem Vater, ist der: die Waisen und Witwen in ihrer Trübsal zu besuchen…» steht in Jakobus 1:27. Jesus erklärt in Matthäus 25 sogar: «Was ihr einem dieser Geringsten getan habt, habt ihr mir getan.» Welch ein Gegensatz war doch diese Einstellung zum Denken, das in manchen anderen Kulturen vorherrschte! So galt beispielsweise bei den Römern die Armut und das Elend eines Menschen eher als Beweis dafür, dass er das Leben nicht verdiene, denn als Aufforderung, ihm zu helfen.
Zwar sind bekannterweise auch Teile der Christenheit lange Zeit über Leichen gegangen. Wie wir bereits früher feststellten, begann diese Fehlentwicklung mit dem römischen Kaiser Konstantin, welcher Jesus mit einem Kriegsgott verwechselte und ihn verpolitisierte. Gleichzeitig schufen er und seine Nachfolger kirchliche Machtstrukturen, die gar nicht dem entsprachen, was Jesus gelehrt und vorgelebt hatte. In allen Zeitaltern gab es zwar Jünger Jesu, welche die offizielle Kirche oft unter Lebensgefahr auf diese Fehlentwicklungen hinwiesen. Anstatt aber diese Ermahnungen ernst zu nehmen, wurde dem einfachen Volk das Bibellesen von höchster Stelle aus untersagt. Die Übersetzung der Heiligen Schrift in europäische Sprachen war Jahrhunderte lang teilweise unter Höchststrafen verboten. Nur lateinische Bibeln waren für Priester erlaubt.
Doch auf die Dauer konnte die Wahrheit nicht verborgen bleiben. Heute ermutigen alle Denominationen das Lesen der Bibel, und ihr lebensbejahender Inhalt hat sich nicht nur durch Henry Dunant auf alle Welt ausgewirkt. Denken wir nur an die Heilsarmee und unzählige christliche oder weltliche karitative Werke. Diese Bewegung ist eben nicht zufällig zuerst auf dem Kontinent entstanden, der die Bibel nach dem Mittelalter wiederentdeckte.

History changer
Eine alte Geige wird versteigert. Man wischt den Staub weg. Der Auktionator gibt sich alle Mühe: «Diese Violine ist ein Prachtexemplar! Seht: Eine kostbare Fiedel aus alten Zeiten.» Doch niemand beachtet ihn. Keiner will sie. Da tritt ein Mann hervor, ergreift die Violine und spielt eine wunderschöne Melodie. Die Leute sind begeistert. Nun will plötzlich jeder die Geige haben. Es werden Hunderte und Tausende geboten.
Die Berührung durch die Hand eines Meisters hat der Geige Wert gegeben. Ich vergleiche die Fiedel mit der Bibel. Wir modernen Menschen fragen uns, ob die verstaubte Bibel, die wir auf dem Estrich finden, einen objektiven Wert hat. So ging es mir schon im Teenageralter. Als ich mich damals in die ersten Seiten hineinlas, putschte die Schöpfungsgeschichte bereits mit meinen Evolutionsvorstellungen zusammen, die ich damals für unumstössliche Fakten hielt. Als ich anschliessend von den vielen Fragezeichen hinter Darwins Theorien hörte, fiel ich aus allen Wolken. Doch es blieb ein Unbehagen: die Vorstellung, dass Gott Adam und Eva aus Erde erschuf, kam mir ein wenig primitiv vor. Zugleich war mir aber auch bei der Idee, von Affen abzustammen, eigentlich nicht ganz wohl. Ich konnte mir das zwar für die Nachbarn, aber nicht für unsere Familie vorstellen! Doch ist die Bibel echt? Es gibt nichts Wertvolles, was nicht gefälscht worden wäre. Falschgeld, nachgemachte Bilder, Reproduktionen, Falsifikate, Doubletten, Zeitungsenten und Fake-News, Videos, die ganz anderswo aufgenommen wurden als angegeben, gestohlene Pässe, Produktpiraterie, Imitationen, Plagiate,etc.
So ist auch die Bibel nachgemacht worden. Der Koran und das Buch Mormon sind nur zwei Beispiele von Ersatzbibeln. Doch historisch sind derartige Werke völlig wertlos. Wie soll jemand nach Hunderten und Tausenden von Jahren diejenigen korrigieren, welche Augenzeugen waren?
Jeder Philosoph bringt eine neue Theorie. Jede wird nach seinem Tod wieder umgestossen. Tatsächlich gibt es kein Buch und keine Theorie, die im Laufe der Jahrtausende so beständig geblieben sind wie die Bibel. Aber kann ich ihr vertrauen, meine Ewigkeit an sie hängen? Um Ihnen bei diesem Entscheid zu helfen, haben wir auf der Webseite www.historychanger.info und in diesem Buch die Gütesiegel der Bibel aufgezeigt. Sie besteht jeden Test.
Am Ende dieses Buches kommen wir noch kurz auf ein paar weitere Kriterien zu sprechen:
- Die Bibel enthält übernatürliches Wissen. Hier als Beispiel: medizinisches Wissen (4A).
- Sie zeigt uns die Liebe auf, nach der die Menschen überall vergeblich suchen. Die biblische Dimension der Liebe gibt es sonst nirgends (4B).
- «Die Bibel» steht auf vielfältige Weise verblüffend quer über die Weltgeschichte geschrieben, ohne dass wir dies überhaupt nur merken (4C).
- Der ultimative Test: Wenn es ums Sterben geht, sieht alles plötzlich ganz anders aus. Die Wunder, welche die Bibel verspricht, geschehen tatsächlich auch (4D).
- Nach Alledem stehen wir plötzlich nicht mehr als Ankläger der Bibel da, sondern als Verleumder. Falsche Anklagen sind strafbar (4E). Somit sind wir die Angeklagten (4E).
Doch jemand mag nun überzeugt sein, dass die Bibel Gottes Wort ist. Und trotzdem bleibt er auf Distanz. Die Bibel erwacht erst dann zum Leben, wenn der Heilige Geist sie unserem Geist erklärt. Wie bei der Fiedel macht die Berührung durch die Hand des Meisters den Unterschied. Dafür kann man beten und sich öffnen. Seine Liebe wird niemanden im Stich lassen, der ehrlich seine Herzenstüre öffnet.

«Ich bin der Herr, Dein Arzt», sagt Gott in 2. Mose 15:26. Allerdings gibt es im AT noch kaum übernatürliche Krankenheilungen. Diese beginnen hauptsächlich mit Jesus. Um diesen Satz aber richtig zu verstehen, muss man lesen, was dazu gehört: «Wenn du der Stimme des HERRN, deines Gottes, gehorchst und tust, was recht ist vor ihm, seine Gebote beachtest und alle seine Gesetze hältst, so will ich dir keine der Krankheiten auferHistory changer
legen, die ich den Ägyptern auferlegt habe; denn ich bin der HERR, dein Arzt.» Er verspricht also nicht Heilung, sondern Bewahrung. Tatsächlich ist das Gesetz des Moses voll mit Tipps, welche vor Krankheit bewahren. Nehmen wir ein Beispiel: Bei einer einzigen Pestepidemie um 1350 starb ein Drittel der europäischen Bevölkerung. Niemand wusste, was zu tun war.
Die Wissenschaft hatte keine Antwort. Schliesslich fragte man die Kirche, welche im Gesetz des Moses las, dass jemand, der Tote berührt hatte, 7 Tage lang in Quarantäne gehen soll. Gemäss 4. Mose 19:14ff sollten sogar die offenen Geschirre im Raum, worüber kein Deckel gebunden ist, als unrein gelten. Mit derartigen Hygieneregeln begann der Sieg über die Pest.
Ganze sieben Tage soll jeder unrein sein und in Quarantäne gehen, nur weil er kurz einen Toten berührt hat? Das tönt übertrieben.
Nun ja, im Normalfall ist das vom medizinischen Standpunkt her gesehen nicht notwendig. Doch wenn die Person an einer ansteckenden Krankheit gestorben ist, dann wird derjenige, der den Leichnam berührt hat, leicht zum Überträger. Genau so haben sich die grossen Pestepidemien und Kindbettfieber verbreitet, an denen Unzählige ums Leben kamen. Wo die Gebote Mose beachtet wurden, konnten sich derartige Krankheiten aber nicht ausbreiten.
Wussten Sie, dass Juden in vielen Ländern u.a. auch deswegen verhasst waren, weil sie so selten krank wurden? Als die Menschen beobachteten, dass viele sich mit Krankheiten ansteckten, die Juden aber seltener, glaubten sie, diese hätten die Anderen vergiftet oder verflucht. Doch der wahre Grund war ein anderer: Die Juden befolgten im Gegensatz zu den Europäern die Hygieneregeln des Moses. Ja, sie haben richtig gehört: Moses gilt bei Fachleuten als der grösste Hygienelehrer aller Zeiten. Lange bevor die moderne Wissenschaft herausfand, dass gute Hygiene vor vielen Krankheiten schützen kann, hat Moses dies seinem Volk schon beigebracht.
Ein anderes Beispiel: Lepra ist eine der Krankheiten, welche die Menschheit seit Urzeiten verfolgt. Sie wirkt langsam, beginnt an der Hautoberfläche, lässt aber bei vollem Ausbruch den Menschen schlussendlich bei lebendigem Leib sozusagen verfaulen. Einst war es das erklärte Ziel der Weltgesundheitsorganisation, die Lepra bis zum Jahr 2005 auszurotten. (33) Nach wie vor stecken sich jedoch jedes Jahr um die 200 000 Perso -
nen neu damit an. Zwar gilt sie nur als schwach ansteckend. Doch diese Erkenntnis ist verführerisch. Wer sie deshalb für ungefährlich hält, täuscht sich. Denn unzählige Menschenleben sind davon im Laufe der Geschichte zerstört worden.
Doch warum ist es so schwierig, gegen Aussatz anzukämpfen? Gibt es denn keine Medikamente?
Heute gibt es natürlich Medikamente, welche die Lepra stoppen. Doch die Ausrottung der Krankheit ist aus verschiedenen Gründen sehr schwierig. Armut, Unwissenheit und Kriege tragen zur Verbreitung von Lepra bei. Zudem ist die Inkubationszeit ungewöhnlich lang, so dass die Krankheit erst spät erkannt wird.
Moses konnte zwar die Lepra nicht mit Medikamenten bekämpfen, die es damals noch nicht gab. Er rückte der Krankheit mit Hygieneregeln zu Leibe. Im 3. Buch Mose, Kapitel 13, Vers 14 steht das harte, aber einzige wirksame Rezept, das damals möglich war: «Solange das Übel besteht, bleibt er unrein; er ist unrein. Er soll abgesondert wohnen, außerhalb des Lagers soll er sich aufhalten.» Der Kranke musste von seiner Familie und allen gesunden Menschen getrennt werden.
Doch die Hygiene in den Mosebüchern geht noch weiter. Sogar auch Kleider und Häuser mussten untersucht und gereinigt werden. Tatsächlich finden wir in 3. Mose 13 Massnahmen gegen Schimmelpilz an Gebäuden. Der sich ausbreitende Schimmel an Häusern wird in der Bibel mit dem gleichen Wort bezeichnet, das auch die Leprakrankheit und andere Hautkrankheiten beschreibt, die den Menschen befallen. Auch Häuser und Kleider mussten demnach unter Umständen abgerissen oder gar verbrannt werden. Ist das unnötig übertrieben? Könnte man meinen, wenn man unwissend ist. Aber hören Sie mal, was moderne Fachleute zum Thema schreiben: «Schimmelpilze in Wohnräumen, wie zum Beispiel schwarzer Schimmelpilz, sind generell gesundheitsgefährdend. Die Sporen, die gefährliche Enzyme bilden, gelangen über die Atmung und die Haut in den menschlichen Körper. Die gebildeten Giftstoffe, sogenannte Mykotoxine, können eine Vielzahl an Krankheiten auslösen. Meist handelt es sich um Atemwegsprobleme oder allergische Reaktionen, einige Schimmelpilzarten stehen jedoch im Verdacht, Krebs zu verursachen oder können zu schweren Organschäden bis hin zum Tod führen.»
So ist der wissenschaftliche Stand zu Schimmel an Häusern heute. Aber was wussten die Menschen früher darüber? Kaum etwas. Nur wer die Bibel las, wusste mehr.
Kommen wir zum Schluss noch auf eine weitere Hygieneregel zu sprechen. Dabei geht es eigentlich nur um zwei Sätze, welche tatsächlich banal tönen, so als ob es das Selbstverständlichste der Welt wäre, kaum wert, es wiederzugeben, was da im 5. Buch Mose, im 23. Kapitel, von Vers 12-13 steht. Und doch haben diese zwei einfachen Sätze, dort wo sie beherzigt wurden, zweifellos unzählige Menschenleben gerettet. Da steht geschrieben: «Auch sollst du draussen vor dem Lager einen Platz haben, wohin du zur Notdurft hinausgehst. Und du sollst eine Schaufel haben, und wenn du dich draussen setzen willst, sollst du damit graben; und wenn du gesessen hast, sollst du zuscharren, was von dir gegangen ist.» Welche Krankheiten können denn ausbrechen, wenn die Notdurft nicht vergraben wird?
Es geht um Krankheiten wie die Ruhr, Cholera, Typhus und andere. Vielen Menschen wären derartige Leiden erspart geblieben, wenn der Wert dieser zwei simplen Sätze rechtzeitig erkannt worden wäre. Leider wurden aber diese Vorschriften noch bis in die Neuzeit sogar in Europa kaum beachtet. Bis zum Ende des 18. Jahrhunderts waren die hygienischen Vorschriften selbst in den Grossstädten äusserst primitiv. Man warf vielerorts den Kot kurzerhand auf die Strassen. Fliegen fanden ideale Brutstätten, legten ihre Eier in den Schmutz und verbreiteten unmerklich Krankheiten und Seuchen.
Natürlich kann man gut verstehen, dass jene Generationen den Zusammenhang zwischen derartigem Abfall und Seuchen nicht begriffen. Auch ich wäre sicher nie darauf gekommen, hätte ich dies nicht von klein auf so gelernt. Umso bemerkenswerter sind die zwei Sätze aus dem fünften Mosebuch.
Wir könnten hier noch weitere Beispiele anführen, wie z.B. die Unterscheidung zwischen reinen und unreinen Tieren vor Zoonosen (unendlich viele Krankheiten, unter anderem Grippe und Erkältung, aber auch Pocken, Hepatitis und Corona) aber auch die Sexualmoral der mosaischen Gesetze vor Geschlechtskrankheiten (Syphilis, Tripper, Chlamydien etc.) retten.
Die Gesundheitsgesetze, die Moses offensichtlich übernatürlich gegeben wurden, zielten nicht darauf ab, Krankheiten zu behandeln, sondern sie zu vermeiden. «Moses erkannte das wichtige Prinzip, dass die Verhütung von Erkrankungen gewöhnlich leichter und unvergleichlich weit reichender ist als die Heilung von Krankheiten... Seine Lehren (im 3. Buch Mose) könnten mit den Richtlinien heutiger Hygienestandards zusammengefasst werden – reine Nahrung, reines Wasser, reine Luft, reine Körper und reine Wohnräume». (34) Er war offensichtlich seiner Zeit weit voraus. Und das Verblüffendste ist, dass Moses sich keineswegs als Gesundheitsfanatiker präsentiert. Alle diese Regeln werden religiös begründet. Die Juden sollen all dies tun, um rein zu sein, weil Gott rein ist. Die gesundheitliche Komponente ist dabei derart versteckt, dass kaum jemand sie je bemerkt hat.
Wer die Bibel liest, weiss mehr.
33) Andreas Kalk: Die fast vergessene Krankheit. In: Deutsches Ärzteblatt. 97/13 (2000), S. B-714–B-715.
34) Ralph Major in «A History of Medicine» [Eine Geschichte der Medizin], Band 1, Seiten 62-64.

unsplash / Kati Hoel
Ein Mann, den ich persönlich kenne, hat seine eigene 20-jährige Tochter mit dem Messer umgebracht. Er behauptet, dies aus Liebe zu ihr getan zu haben. Denn wenn sie weiter leben würde, so wäre sie noch weiter vom «rechten Weg» abgekommen, und noch schlimmer von Allah bestraft worden.
Dieses Ereignis hat mich tief bewegt, weil es sogar ein Teil unserer Familiengeschichte ist. Ich habe mehrere Tage mit dem Mann verbracht, und versucht, sein Gewissen zu wecken. Es war unmöglich. Welch eine Manipulation! Was für ein Lügengeist! Was die Fehler seiner Tochter angeht, so glaubt er offenbar an einen strengen Richtergott, der sie für ewig für ihre Sünden straft. Doch wenn es um seine eigene Boshaftigkeit geht, die schliesslich durch den Mord gekrönt wurde, behauptet er, Gott sei «Rahman Rahim» d.h. barmherzig, vergebend.
Aber das Problem liegt nicht nur bei jenem Mann. So verlogen ist die Menschheit. Weltweit wird Liebe mit Sex verwechselt. Wenn uns jemand betrügt, schreien wir auf. Wenn wir selber jemanden betrügen, sagen wir, wir müssten halt ehrlich zu unseren Gefühlen stehen.
Der Mensch ist unglaublich anfällig für Manipulation. Um sein Gewissen zu überlisten, gewöhnt er sich daran, mit verschiedenen Massstäben zu messen. Und dabei scheut er nicht zurück, sogar noch Gott einzuspannen, um den eigenen Egoismus zu rechtfertigen.
«Aus Liebe» treibt jemand sein Kind ab, denn es hätte ja ein schwieriges Leben gehabt, wenn es gelebt hätte. So wird behauptet. Aber zugleich verurteilt man die Terroristen, welche unschuldige Menschen umbringen, insbesondere wenn es Kinder sind. Diese wiederum fühlen sich dem Westen moralisch haushoch überlegen, «denn», so sagen sie hinter vorgehaltener Hand, «in Europa leben ganz böse Menschen, welche die eigenen Kinder abtreiben». Jeder erlaubt sich selber genau das, wofür er andere verurteilt.
Wir stehen in grosser Gefahr, Egoismus und Manipulation mit Liebe zu verwechseln. Weil sie gewisse böse Taten nicht tun, die sie an Anderen verurteilen, halten sich die meisten Menschen für besser als jene. Die Religiösen unter ihnen meinen vielfach, Gott sei ihnen nun etwas schuldig und müsste sie dafür belohnen. Manche Menschen glauben, dass Gott im Himmel eine Waage bereithält, auf der er alle unsere guten und schlechten Taten gegen einander abwägt. Falls bei uns das Gute stärker ist, dann kommen wir ins Paradies, ansonsten haben wir verloren.
Doch aufgepasst. Das kann schon alleine aus dem Grund nicht stimmen, weil da Gottes Liebe zu einer Ware degradiert wird. Hängt Gottes Liebe davon ab, dass ich mich abrackere? Ist das nicht eher menschliches Denken, welches Gott zu einem Händler degradieren will?
Gott ist doch kein Buchhalter! Er braucht das gar nicht, was wir da zu tun versuchen. Müssen wir uns Gottes Liebe verdienen, dann ist sie nicht Liebe, sondern Lohn.
Die Bibel erzählt etwas ganz anderes. Bevor Adam ein einziges gutes Werk tun konnte, hatte Gott schon das ganze Paradies und das Weltall für ihn erschaffen. So grosszügig ist Gott. Wir brauchen Ihn wirklich nicht durch unsere Taten dazu zu manipulieren, dass er uns schliesslich dann auch noch etwas Gutes tut! Bevor wir geboren wurden, ist Christus schon am Kreuz für uns gestorben, und alles, was es braucht, ist, unsere Bedürftigkeit zuzugeben, und dies in Demut und Dankbarkeit anzunehmen.
Sehen Sie also, dass wir die Bibel brauchen, um überhaupt zu verstehen, was Liebe ist? Gottes Buch korrigiert die falschen Vorstellungen, die wir uns selber zurecht gelegt haben. So denken viele Menschen, dass Jesus einfach ein guter Mensch gewesen sei. Oder sie stellen sich wie die Zeugen Jehovas vor, dass er ein Mensch gewordener Engel sei. Beide Vorstellungen können nicht stimmen, weil sie Gott zu einem Tyrannen machen würden. Wenn er einem Menschen oder einem Engel befehlen würde, sich für die Sünden der Menschheit zu opfern, dann wäre das etwa so, wie wenn ich meinen Nachbarn dazu verknurren würde, die Schulden meiner Freunde zu bezahlen. Nein, das wäre nicht Liebe. Gott hat die Schulden selber bezahlt. Er kam zwar in der Form eines Menschen, aber er war es selber. Nur das ist absolute Liebe.
Wir meinen, unsere Umwelt durch unsere Stärke beeindrucken zu müssen. Zugleich zittern wir vor dem Tag, an dem unsere Schwächen zum Vorschein kommen. So kämpfen wir uns durch das Leben, ohne uns bewusst zu sein, dass wir echter Liebe damit Tür und Tor verrammelt haben. Gott dagegen scheut sich nicht, sich in Jesus selber ans Kreuz zu geben. Schwächer und tiefer geht es nicht mehr. Beim Kreuz lernen wir jeden Tag neu, was es heisst, zu lieben.
Die Bibel kann schon verwirrend sein. Einmal wird Gott Vater, dann wieder Sohn genannt, einmal ist Jesus der Himmelssohn, dann wieder Menschensohn; einmal gilt er als Herr, dann wieder als Sohn Davids. Jesus wird mal als lebendiges Wasser, dann wieder als Brot beschrieben, dann als Licht und als Hirte, als Weinstock und so weiter. Je mehr man liest, desto mehr Bezeichnungen findet man, die - ehrlich gesagt - teilweise fast widersprüchlich tönen. Auch die Gläubigen werden mit vielen verschiedenen Bezeichnungen versehen. Einmal gelten sie als Gemeinde, dann als Braut, als Tempel, als Freunde, dann wieder als Kinder Gottes, als Jünger, als Kirche, dann wieder als eine Herde Schafe, als Zweige, als Salz und Licht der Welt.
Die Theologen zerbrechen sich die Köpfe und erfinden die verrücktesten Theorien, um all diese Ausdrücke irgendwie doch noch unter einen Hut bringen zu können. Doch das ist gar nicht nötig, denn es handelt sich gar nicht um wissenschaftliche Aussagen, sondern um die Sprache von Verliebten. Wer schon mal verliebt war oder einem Liebespaar zugehört hat, der weiss, dass dort Dinge gesagt werden, die für Aussenstehende keinen
Sinn ergeben. Tatsächlich behauptet die Bibel, dass hinter dem Weltlauf letztendlich eine Liebesgeschichte steckt. Die Liebe eines Gottes, der sich aus der Menschheit sozusagen eine Braut zubereiten will. Damit wird auch die schönste irdische Liebesgeschichte höchstens ein billiger Abglanz jener ewigen kosmischen Liebe, zu der wir alle eingeladen sind. Dies zeigt sich ganz besonders in einem kurzen Abschnitt des Alten Testamentes, dem sogenannten Hohelied der Liebe, aber auch bei den fünf Johannesbüchern im NT. Beim wahren Glauben geht es also nicht um sture Gesetze, nach denen ein strenger Gott uns aburteilen möchte, sondern es geht darum, dass wir, solange uns irgendetwas anderes im Leben wichtiger ist als Er, nicht in jene tiefste Liebesbeziehung eintreten können, und sie am Ende gar für immer verpassen! Wer allerdings den offensichtlichen Liebesgott der Bibel verpasst, der wird es schwer haben, etwas Vergleichbares zu finden. Wo er sich auch anhängt, gibt es Enttäuschung über Enttäuschung.
Wie weiss man, ob man in jene Liebesbeziehung eingeschlossen ist bzw. dazu gehört oder nicht? Ganz einfach: Wer verliebt ist, für den machen alle genannten Bezeichnungen einen Sinn, ja, mehr als das: Sie faszinieren ihn. Wer bei den Äusserlichkeiten und scheinbaren Widersprüchen stehen bleibt, dessen Herz ist noch kalt geblieben und er hat noch gar nicht begriffen, um was es geht!

Die vorgefasste Meinung, bzw. der Wahn, die Bibel sei rückständig und an allem Schlechten schuld, sie sei intolerant, gegen die Moderne und hindere die Wissenschaft, sie sei wertlos und unnötig etc. ist extrem gefährlich und führt uns in den Abgrund. Erstens ist sie überhaupt nicht wahr. Zweitens besteht die Gefahr, dass wir alles, was wir der Bibel zu verdanken haben, wieder verlieren könnten, und dass eines Tages alle diese Errungenschaften gegen uns genutzt werden.
Tatsächlich ist quer über die Geschichte der Menschheit unlöschbar «die Bibel» geschrieben, und dies gleich mehrmals und in verschiedenen Formen. Als Erstes in Form des Wortes «Israel». Zwar wollte man das Volk Israel schon bei seiner Geburt im alten Pharaonenreich vernichten, und später fanden sich immer wieder Feinde, welche es nicht nur bekämpften, sondern regelrecht auslöschen wollten, bis zum heutigen Tag. Aber es war nicht Israel, sondern jene Feinde, welche schliesslich von der Bildfläche verschwanden. So gibt es heute weder Pharaonen, noch Haman oder seine Agagiter, noch Babylonier, oder die SS der Nazis. Aber Israel ist immer noch da. Und auch in der heutigen säkulären Welt in verblüffendem Ausmass das Zentrum weltweiter Aufmerksamkeit. Das sollte uns aufhorchen lassen.
Wie wir in diesem Buch gesehen haben, haben wir praktisch alles Wertvolle unserer Kultur letztlich der Bibel zu verdanken. So etwa auch die Jahreszahlen. Es gab viele Versuche, die Jahre der Weltgeschichte anders zu zählen. Doch wenn man heute eine Jahrzahl nennt, ohne spezielle Erklärungen dazu zu fügen, so weiss jeder, dass er automatisch «nach Christus» ergänzen muss.
Soll die Woche fünf oder zehn Tage haben? Nein, sieben. So hat es die Bibel schon auf den ersten Seiten festgelegt, und weltweit sind sowohl Gläubige als auch Ungläubige gleichermassen überzeugt, dass es so richtig ist, obwohl es durchaus Versuche gab, dies zu ändern (z.B. bei den französischen und russischen Revolutionen).
Auch Christus ist seit 2000 Jahren über die Weltgeschichte geschrieben. Obwohl man meinte, ihn am Kreuz ein für alle mal losgeworden zu sein und es seinen Jüngern bei Todesstrafe verbot, von ihm zu sprechen, wurde er zur bekanntesten Person der Weltgeschichte. Tatsächlich wollten die Römer nicht nur die Juden, sondern auch die Christen ausrotten. Doch es ist ihr Reich, das längst untergegangen ist. Seither haben nicht nur Muslime und Kommunisten, sondern auch machthungrige europäische Staatskirchen versucht, den Einfluss der Bibel zu begrenzen.
Ja, Sie haben richtig gelesen. Denn es waren tatsächlich sogenannt christliche Staaten, welche im späten Mittelalter aus Angst vor Machtverlust Jahrhunderte lang bei Todesstrafe verboten, die Bibel in europäische Sprachen zu übersetzen. Wegen ihrer Liebe zur Bibel wurden William Tyndale, Johannes Hus und viele andere auf dem Scheiterhaufen verbrannt. Aber es war unmöglich, dieses Buch einzusperren. Heute ist es das meistübersetzte und meistverbreitete Buch der Weltgeschichte.
Nicht nur Deutsch und Englisch, nein, viele moderne Sprachen wurden massgebend von Bibelübersetzern geformt. Ohne die Bibel hätten viele Völker bis heute keine Schriftsprachen und wären sogar die meisten Europäer noch heute Analphabeten.
Ohne die Bibel gäbe es auch keine moderne Wissenschaft, wie wir bereits festgestellt haben. Zudem lässt sich sogar die einzigartige Entwicklung der europäischen Literatur im Wesentlichen auf ihre Ursprünge in der Bibel zurückverfolgen.
Im übereifrigen Bestreben, sich selber frömmer darzustellen, hat die katholische Christenheit schon im Mittelalter entgegen dem Rat der Bibel den Priestern das Heiraten verboten, so als ob Heiraten eine Sünde wäre. Doch die biblische Lehre kann nicht ungestraft auf den Kopf gestellt werden. Skandal um Skandal werden nicht aufhören, bis diese Irrlehre wieder abgeschafft wird.
Aus lauter Angst, die Botschaft der Bibel könnte durch die moderne Wissenschaft als lächerlich dargestellt werden, hat die sogenannte liberale Theologie seit 200 Jahren versucht, alles Übernatürliche aus der Bibel zu streichen und symbolisch zu erklären. Auffälligerweise sind es diese Kirchen, die heute an Mitgliederschwund leiden, während die Kirchen verpönter «Fundamentalisten» weltweit zunehmen.
Scheinbar weltliche europäische Geistesbewegungen wie die Aufklärung und Sozialismus sind einzigartig in der Menschheitsgeschichte. In ihren Kernpunkten stehen Ideale, die aus der Bibel stammen, mit der Zeit verweltlicht und von ihren Wurzeln abgeschnitten wurden.
Viele Muslime glauben, dass der Koran die Bibel ersetze. Doch das kann schon alleine aus dem Grund nicht stimmen, weil der Koran erst durch die Bibel wirklich verständlich wird. Gerade jetzt wird ein Grossteil der Hadithen, die man 1400 Jahre anstelle der Bibel gesetzt hat, wieder abgeschafft (sogar im Kernland Saudi Arabien). Tatsächlich verspricht der Koran mit keinem Wort, dass nach ihm noch Hadithen oder Sira kommen werden, verweist aber immer und immer wieder auf die ehrenwerte Thora Mose, die Zabur Davids, das Ingil von Jesus und alle anderen Prophetenbücher. (35)
Seit 200 Jahren meint man, der Glaube an die Evolution öffne den Weg unserer Weiterentwicklung zu einer besseren Menschheit. Doch langsam beginnt der Widerspruch zu dämmern. Evolution führt logischerweise nicht zu Menschenrechten, Demokratie und Sozialwerken, sondern zur Herrschaft des Stärkeren, zu Unterdrückung, Rassismus und endgültiger Ausrottung. Sie kennt weder Liebe noch Gutmütigkeit, sondern ist von Kälte und Gleichgültigkeit geprägt.
Tatsächlich droht heute der gesamten Menschheit der totale Untergang, und dies gleich aus mehreren Gründen wie Atomkatastrophen oder Umweltverschmutzung. Und man kann nur hoffen, dass verantwortungsbewusste Menschen an den entscheidenden Schaltstellen sitzen, welche den Wert alles Lebens kennen, wie die Bibel es lehrt. Diktatoren und Evolutionisten dagegen werden zweifellos über kurz oder lang auf die Idee kommen, einen Teil der Weltbevölkerung auszulöschen sei ein Gewinn, und es gibt nichts an ihrer Lehre, das sie vor erneuten Massenmorden zurückhalten könnte.
Benötigt es noch mehr Beispiele, um zu zeigen, wie wertvoll und unentbehrlich das Buch Gottes ist? Ohne die Bibel werden moralische Standards schrittweise abbröckeln und je nach Standpunkt relativiert werden. Ehre wird wieder wichtiger werden als Wahrheit, denn dies entspricht viel mehr der menschlichen Natur. In der Folge werden allgemeine Menschenrechte mehr und mehr durch Schmiergeld, Unterdrückung und Sklaverei ersetzt werden, Demokratie durch Diktatur und Sozialstaatlichkeit durch Vetternwirtschaft. Die willkürliche Verfolgung von politisch und religiös Andersdenkenden wird auch im Westen wieder unzählige Opfer fordern. Behinderte und Schwache werden ihre Unterstützung verlieren, da sie nicht als kostbare Ergänzung, sondern als Last und Schande empfunden werden. Mord und Ehrenmord wird in vielfältiger Art wieder Einzug halten, weil die Starken ihre Herrschaft nur scheinbar mit Abstimmungen, in Wirklichkeit aber mit Gewalt befestigen werden.
Aber am schlimmsten wird sein, dass die gesamte moderne Wissenschaft in die Hände jener Diktaturen fallen muss und nicht dazu gebraucht wird, uns zu dienen, sondern zu unterdrücken und zu zerstören. Der Segen, den wir der Bibel zu verdanken haben, wird in ihrer Absenz in Fluch verwandelt.
Wird uns der gesunde Menschenverstand und der Glaube an das innewohnende Gute im Menschen retten können? Leider kaum, denn die Geschichte lehrt uns, dass Menschen sich leicht in hemmungslose Fanatiker verwandeln können und ganze Völker wahnsinnigen Ideen nachrennen, auch wenn dies die Ermordung Unzähliger beinhaltet und am Ende der eigene Selbstmord steht.
Darum, tun wir, was uns möglich ist, um die Menschheit zu warnen. Die Lösung ist nicht der Mensch. Er ist das Problem. Und sein schlauster Schachzug ist, Gott für die selbstverschuldeten Fehler anzuklagen. Wer die dunkle Seite des Humanismus übersieht, wird davon überrascht werden. Es ist ein Spiel um Überleben und Untergang.
35) Details dazu siehe mein Buch «Perlen im Koran», ISBN 9783730932438

Es begann mit Husten. Der zog sich immer länger hin. Er war nicht behandelbar. Dazu kam zunehmende Atemnot. Und schlussendlich musste ich schnellstens mit dem Krankenwagen ins Spital eingeliefert werden. Dort stellte man fest, dass mein Herz noch 15% arbeitete. Ohne Blut und Sauerstoff können auch die anderen Organe des Körpers ihre Aufgaben nicht erfüllen. So war auch die Lunge voll Wasser.
Die Ärzte sagten meiner Familie ganz offen, dass sie nicht wüssten, ob ich überlebe. «Die Einen schaffen es, die anderen nicht.» Sie könnten für nichts garantieren. Meine Familie mobilisierte unser Freundesnetz. Von Amerika über Marokko, Ägypten, Deutschland und natürlich an vielen Orten in der Schweiz wurde für mich gebetet.
Der Ultraschall ergab nach etwa drei Monaten schliesslich wieder eine Herzleistung von 45%. «So schnell, so viel» staunte der Arzt. Das sei doch sehr aussergewöhnlich. Er mass es nochmals.
Ich erklärte ihm, dass viele Menschen für mich beten würden. «Damit hat das gar nichts zu tun», schnippte er zurück. Tatsächlich liegt es in der Luft, was mich schlussendlich gerettet hat. Es lässt sich nicht beweisen, wie -
viel die Medizin bzw. das Gebet beigetragen haben. Aber ich bin meinen Freunden dankbar, die gebetet haben.
Es gibt allerdings Fälle, die viel eindeutiger sind. Meine Frau betete einst mit einer Frau, deren Schilddrüse überhaupt nicht mehr funktionierte und deren Herz krank war. Am nächsten Tag staunte der Doktor, dass die Schilddrüse wieder arbeitet und das Herz sei wie neu geboren.
Natürlich sind nicht alle Wundergeschichten wahr. Es gibt Zufälle, und es gibt auch Leute, die übertreiben. Es gibt sogar Leute, die Wunder von A bis Z erfinden, um sich ins Zentrum der Aufmerksamkeit zu rücken. Aber trotzdem haben wir über Jahrzehnte im engsten Freundes- und Verwandtenkreis echte Heilungswunder erlebt. Zwar passiert es oft, dass man betet, ohne dass etwas geschieht. Heilung geschieht nicht automatisch durch Gebete, sondern dann, wenn der Heilige Geist kommt. Dass dies geschieht, ist nicht garantiert, aber es passiert immer wieder. Sie können heute Millionen von Menschen finden, die überzeugt sind, dass sie im Namen von Jesus von Krankheiten geheilt wurden. Sie werden aber kaum jemanden finden, der im Namen von Abraham oder Moses geheilt ist. Sogar der Koran bezeugt, dass Jesus der Prophet sei, und zwar der Einzige, der Kranke heilt. Eine ganze Bibliothek liesse sich mit den Büchern füllen, die von derartigen Heilungen erzählen. Und Bücher sind vertrauenswürdiger als Videos, weil Zeit verstreicht, bis ein Buch veröffentlicht werden kann.
Es gibt Leute, die haben über Jahre erfolglos für Heilung gebetet. Aber weil sie nicht aufgaben, schlug es eines Tages ein: Der Heilige Geist kam und tat das Wunder.
Früher oder später trifft es jeden von uns. Irgendeine Krankheit, die unheilbar ist. Wir winden uns vor Schmerzen. Die Medizin steht vor vielen Rätseln. Irgendwann kann sie nur noch die Schmerzen erträglicher machen. Wer dann Jesus kennt, ist besser dran. Denn bis zum letzten Moment besteht die Möglichkeit, dass er heilt. Und wenn nicht, so gibt er eine Perspektive für das, was nach dem Tod geschieht. Natürlich behaupten auch andere Religionen, derartige Perspektiven zu geben. Doch keine von ihnen lehrt absolute Liebe, keine hat die unendlichen Probleme der Ehrenkultur überwunden, keine ist derart in der Geschichte gegründet nachprüfbar, keine hat auch nur annähernd den Leistungsnachweis der Bibel erreicht. Prüfen Sie es selbst! Es fehlt ihnen der Fingerabdruck des Meisters.
Den Islam muss man winden und drehen, um ihn einigermaßen menschenfreundlich erscheinen zu lassen. Um den Koran als göttlich darzustellen, muss man Wunder erfinden, die sich bei näherer Betrachtung als völlige Manipulation herausstellen. Der Buddhismus kann zwar für Oberflächliche mit ein paar schönen Aussagen aufwarten. Wer aber tiefer gräbt, findet in ihm eine kalte Religion, die keinerlei Erbarmen lehrt, da leidende Personen ja ihr Karma nur durch das Ertragen ihrer Not verbessern können. Wer ihnen hilft, schadet ihnen also gemäss dieser Philosophie nur. Zudem ist die Gottlosigkeit des Buddhismus derart unerträglich, dass die Buddhisten vielerorts wiederum Götter erfunden haben. Schlimmer noch ist der Hinduismus, den Buddha ja zu reformieren versuchte, denn das Kastendenken ist völlig rassistisch und blockiert jede mitmenschliche Regung. Natürlich findet sich in jeder Religion etwas Schönes. Der Zusammenhang wird gefördert, Tänze und Kunstformen entwickelt, das Jahr wird mit Festen gefüllt, die Struktur des Volkes und der Familie geformt. Die meisten Religionen stellen aber eher Fragen, als dass sie Antworten geben. Sie lassen den Menschen im Ungewissen. Er bleibt seinen Ängsten ausgeliefert. Insbesondere die Angst vor Dämonen bleibt.
Die grosse Überraschung: Es gibt nichts mit der Bibel Vergleichbares.

Bild: pexels / Sora Shimazaki History
Manche unserer Zeitgenossen möchten die Bibel in den Abfall schmeissen, weil sie unglaubwürdig geworden sei. Tatsächlich steht das Christentum auf der Anklagebank. Es soll Kriege geführt, Hexen verbrannt und Juden verfolgt haben. Doch aufgepasst: Meinen wir etwa, wenn die Bibel nicht nach Europa gekommen wäre, so wäre Derartiges nicht geschehen? Gab es etwa bei unseren heidnischen Vorfahren keine Religionskriege, keine Hexenverfolgungen und keine Verfolgungen Andersdenkender? Waren es nicht vielmehr die alten Germanen, welche Europa das Verbrennen von Hexen überhaupt beibrachten? Und warum tun wir so, als hätte es etwa auf anderen Kontinenten keine Verfolgungen gegeben und als ob Europa die Judenverfolgung erfunden hätte? Waren die Kinder Israels nicht wegen der Verfolgungen durch die heidnischen Babylonier und Römer überhaupt erst aus ihrem Land geflohen?
Haben nicht alle Völker auf allen Kontinenten seit Urzeiten stolz im Namen ihrer Götter andere Ethnien unterjocht? Tatsächlich noch viel mehr als dies: Unsere keltischen und germanischen Vorfahren brachten ihren Göttern sogar regelmässige Menschenopfer dar. Auch die scheinbar so kultivierten Römer verachteten das Leben in unvorstellbarem Mass. Es war für sie selbstverständlich, uneheliche Säuglinge nach der Geburt zu töten oder auszusetzen, Behinderte und Schwache prinzipiell sterben zu lassen,
unzählige Menschen zu kreuzigen, blutige Gladiatorenkämpfe, Tierhetzen und Hinrichtungen als die köstlichsten Freizeitbeschäftigungen und Jahreshöhepunkte zu betrachten. Das Christentum schaffte nicht nur dies alles ab, sondern bewirkte auch, dass in Europa ganze tausend Jahre lang Hexen nicht verfolgt wurden, und zum ersten Mal in der Geschichte der Menschheit überhaupt pazifistische Bewegungen entstanden. Schon die Urkirche selbst ertrug gemäss dem Vorbild von Jesus die Verfolgungen des Römerreiches während 350 Jahren beeindruckend pazifistisch. Auch später waren manche Freikirchen und mönchischen Bewegungen von verblüffender Gewaltlosigkeit geprägt.
Mit welchem Recht wird dem Christentum alles Böse in der Geschichte Europas zur Last gelegt, das Gute dagegen der sogenannten Vernunft gottloser Menschen zugeschrieben? War es denn nicht in Wirklichkeit gerade umgekehrt? Alles Negative in der Geschichte Europas hätte es auch ohne das Christentum gegeben. Und noch viel mehr dazu. Aber die Geschichte dieses Kontinentes hat einiges aufzuweisen, was es nirgends sonst auf der Welt gibt. Und dieses Aussergewöhnliche, Einzigartige, das ist der Bibel zu verdanken. Früher habe auch ich geglaubt, mit Renaissance und Humanismus sei der Übergang zum modernen Zeitalter nur dank der Abkehr von der Bibel möglich geworden. Doch wenn die Bibel wirklich das grosse Hindernis gewesen wäre, dann hätten ja diese Entwicklungen schon längst in anderen Kontinenten stattfinden müssen!
Gerade umgekehrt ist es. Warum wird mit Gewalt übersehen, dass das Wiederaufblühen der alten griechischen Kultur in der Renaissance nur deshalb möglich war, weil die Kirche dies mit unglaublicher Toleranz ermutigte, ja grossenteils sogar finanzierte? Wie kann man die Kirche anklagen, fortschrittsfeindlich gewesen zu sein, wenn doch die allgemeine Schulpflicht erstmals in der Menschheitsgeschichte von der Reformation erfunden und anfangs von der Kirche dem Staat aufgedrängt wurde? Zudem entwickelten sich ja alle frühen Universitäten auffällig aus Klöstern. Und sogar die in der Menschheitsgeschichte einzigartige sog. «Aufklärung» (obwohl der Name, wie gesagt, unglücklich gewählt ist) wäre undenkbar ohne ihre christlich motivierten Vorgängerbewegungen wie die gregorianische Reform und die Devotio Moderna. Die Forderungen der Aufklärer sind einfach eine verweltlichte Form eines Standards von Gerechtigkeit, der schon seit Jahrtausenden in der Bibel steht und auch nachweislich von dort ins europäische Denken übergeschwappt ist.
Nur wer mit grossen Vorurteilen an die Geschichte Europas herangeht, kann leugnen, dass Humanismus, allgemeine Menschenrechte, Demokratie, sog. Aufklärung, Abschaffung der Sklaverei und moderne Wissenschaft ihre Wurzeln im Christentum haben und erst später von diesem entfremdet wurden. Falls die Kirche wirklich prinzipiell gegen die Wissenschaft gewesen wäre, so hätte sie diese leicht blockieren können, genauso wie es zuvor im islamischen Raum geschah. Natürlich gab es hier und dort Reibereien, wie mit Galileo Galilei. Wissenschaftsblockierend wirkten aber keineswegs Bibelverse, sondern längst überholte Aussagen der altgriechischen Philosophen, insbesondere Aristoteles, welche man meinte, im Rahmen der damaligen Respektkultur nicht anzweifeln zu dürfen. Durchbrochen wurden sie erstmals von der «Royal Society of London for Improving Natural Knowledge», welche 1662 Irrtümer Aristoteles` nachwies. Ihre Mitglieder waren wohlgemerkt allesamt Priester und Mönche. Mit biblisch beeinflussten Menschen begann die einzigartige Entwicklung Europas. Nicht nur Universitäten, sondern auch Spitäler entwickelten sich in Klöstern. Notabene die ersten Spitäler der Weltgeschichte. Die Idee der Demokratie und allgemeine Menschenrechte wurden spätestens von John Locke ausdrücklich aus der Bibel abgeleitet und völlige Religionsfreiheit von überwiegend freikirchlich geprägten Asylanten in Rhode Island zum ersten Mal in der Menschheitsgeschichte in der Verfassung als Volkswille verankert.
Will ich damit die Fehler der Kirche verleugnen? Natürlich hat die Kirche auch Fehler, wie jede menschliche Gesellschaft, besonders weil unbiblische Machtstrukturen gebaut wurden und weil sie es verpasste, die Bibel ernster zu nehmen, und schon viel früher in Europa mehr Gerechtigkeit zu fordern. Dann hätte es gar keine «Aufklärung» geben müssen.
Doch auch daran ist nicht die Bibel schuld, sondern der Mensch. Der Humanismus will aber ausgerechnet gerade die kostbare Bibel durch die unberechenbare, verkorkste, unbegreiflich egoistische und subjektive «Vernunft» des Menschen ersetzen, obwohl wir doch all die Katastrophen der europäischen Geschichte genau dieser menschlichen Logik zu verdanken haben. Dagegen ist nachweislich praktisch alles, was uns heute lieb und teuer ist, letztlich durch die Bibel gekommen. Wenn wir uns von dieser Grundlage lösen, wird der Ast abgesägt, auf dem wir sitzen. Die Vorwürfe an das Christentum sind geradezu lächerlich, wenn wir uns seiner Errungenschaften bewusst sind. Ausserhalb der westlichen Welt sind
bis heute allgemeine Menschenrechte und echte Demokratien praktisch überall Wunschdenken geblieben, und auch wir gehen mit jedem Schritt von der Bibel weg, dem erneuten Chaos entgegen. Wir werden uns damit immer mehr in Widersprüche, wie demjenigen zwischen Aufklärung und Darwin verstricken. Der Glaube an die Evolution wird niemals mit den aufklärerischen, letztlich aus christlichen Wurzeln stammenden Forderungen nach Menschenrechten, Demokratie und Sozialstaat zu vereinen sein. Die Folge sind Paradoxons, wie etwa, dass wir einerseits alles tun, um Behinderte als vollwertige Menschen mit gleichen oder sogar mehr Rechten zu behandeln, aber andererseits ebenfalls alles tun, um Behinderte bereits schon vor der Geburt zu entdecken und abzutreiben.
Tatsächlich stehen wir dank dem unbegrenzten Vertrauen in die humanistischen Fähigkeiten des Menschen in Gefahr, über kurz oder lang alles wieder zu verlieren, worauf wir heute stolz sind. Wie gefährlich es wird, wenn man meint, die biblischen Inhalte vom Gott der Bibel trennen und mit reiner menschlicher Logik umsetzen zu können, zeigen die Experimente mit der französischen Revolution und ihren Folgen, wie die napoleonischen Kriege (über 5 Mio. Tote), 1. Weltkrieg und 2. Weltkrieg (9,5 Mio. Tote bzw. ca. 75 Mio. Tote) und dem Kommunismus (bisher ca.100 Mio. Tote).
Wenn ich meinen Nachbarn anklage, mich bestohlen zu haben, und es sich herausstellt, dass er unschuldig ist, werde ich bestraft. Auch falsche Zeugenaussagen werden strafrechtlich geahndet. Wieviel mehr ist Strafe zu erwarten, wenn wir den wahren Gott und sein Wort verleumden und falsch anklagen?
Doch uns zu strafen ist gar nicht Gottes Absicht. Dies zeigt er uns mit dem Kreuz. Die Arme des Gekreuzigten sind weit offen. Er umarmt eine verlorene Welt. Seine Augen sind auf alle Menschen gerichtet. Jeder, egal wie weit weg er war, darf jederzeit zu diesem Kreuz kommen. Es hat Platz genug. Auch für Sie und mich. Da dürfen wir hinknien und Rettung finden. Kehren wir uns weg von unseren eigenen Wegen. Bitten wir um Vergebung. Er macht niemandem Vorwürfe. Vielmehr tropft das Blut aus seinen Wunden auf uns und reinigt uns.
Da beginnt ein neues Leben.

Hat Allah befohlen - dass man Frauen missbrauchen soll? Stimmt es - dass Mohammed sich von Dämonen inspirieren ließ und zudem eine Minderjährige heiratete? Was bedeuten Schariagesetze - Ehrenmorde oder Heilige Kriege? Hält sich der Islam an die Menschenrechte oder bedroht er unsere europäische Gesetzgebung - wenn wir muslimische Lebensformen im Sinne der Toleranz dulden? Wer den Islam verstehen will - der muss auch die Hintergründe kennen. Hier liegen wertvolle Informationen für jedermann vor. Ein praxisnahes Buch über eine Religion - mit der wir Europäer uns in den kommenden Jahren noch vermehrt beschäftigen müssen.

In 99 kurzen Kapiteln beleuchtet Kurt Beutler inspirierende und irritierende Seiten des Korans. Positives und Negatives. Überraschende Aussagen über Jesus, Maria, die Christen und die Bibel wie auch unverständliche und ärgerliche Aussagen über den heiligen Krieg (Dschihad), die Rolle der Frau, über Himmel und Hölle. Spannende und kenntnisreiche Fakten über den Islam, aber auch Wundersames und Staunenswertes.Dieses Buch versucht, Brücken zu schlagen. Der Leser wird oft schmunzeln über die originellen Ideen und Auslegungen manch eines Koranverses. Beim Lesen wird jedem klar, dass hier kein Theoretiker spricht. Diese Gedanken wurden durch jahrelange Gespräche mit muslimischen Freunden geformt und geläutert.

„Christ“ und „Koran“ - das scheint nicht zusammenzupassen. Und doch sagt der Koran ganz viel über Jesus, die Bibel und die Christen.Dieses Buch versucht, Brücken zu schlagen. Der Leser wird oft schmunzeln über die originellen Ideen und Auslegungen manch eines Koranverses. Beim Lesen wird jedem klar, dass hier kein Theoretiker spricht. Diese Gedanken sind im jahrelangen Gespräch mit muslimischen Freunden geläutert.Liebe und Vergebung spricht aus diesen Seiten. Ein Buch für alle, welche die Nase voll haben von sinnlosen Religionskriegen und Hassparolen. Ob die vollständige Versöhnung gelingt und ob die beiden Religionen sich gänzlich unter einen Hut bringen lassen, das zeigt sich allerdings erst im letzten Teil des Buches. Der Schweizer Islamforscher Kurt Beutler ist mit einer Ägypterin verheiratet und Vater zweier Töchter. Der Autor einiger Bücher lebte mehrere Jahre in Ägypten und im Libanon und ist heute als interkultureller Berater für arabisch sprechende Ausländer im Großraum Zürich tätig.


Dieses Buch macht die Hintergründe für Ehrenmorde klar. Wir sollten das Thema nicht Rassisten und Neonazis überlassen. Kurt Beutler wirbt engagiert dafür, sich mit dieser Parallelkultur auseinanderzusetzen und den Schutz für bedrohte Frauen und Mädchen bei uns zu verbessern.
Gibt es einen europäischen Islam? Ist der Islam die Religion der friedlichen Familie oder des Ehrenmordes? Der Barmherzigkeit oder des brutalsten Terrors? Um die Lösung dieses Rätsels bemühen sich immer mehr Politiker weltweit. Denn es geht nicht nur darum, viele Menschen vor Terror zu schützen. Es geht um die Zukunft unserer Kinder. Finden Sie heraus, warum es zur Reform des Islam mehr benötigt als eine neue Interpretation des Korans und was der Preis ist, den wir dafür bezahlen müssen.

In „Die Schweiz und ihr Geheimnis“ geht der Schweizer Kurt Beutler der Identität seines Landes auf den Grund, beschäftigt sich mit dem Gesicht und der Seele der Schweiz. Wie stellt sich dieses Land heute dar? Wo hat es seine Wurzeln? Was ist sein Weg? Und was seine Mitte? Beutler sagt es in deutlichen Worten: „Der Einfluss des christlichen Glaubens in der Schweizer Geschichte ist riesig. Ich glaube, dass eine Rückbesinnung jetzt dran ist, weil es bei der gegenwärtigen Bedrohung nicht mehr angeht, dass wir unseren eigenen Glauben und die eigenen Wurzeln mit Füßen treten. Es geht darum, zu einer neuen Wertschätzung zu finden, um anderen Religionen und Immigranten mit Selbstbewusstsein begegnen zu können. Fest und stark in dem Wissen, was uns im Tiefsten zusammenhält.“„Die Schweiz und ihr Geheimnis“ ist eine moderne Liebeserklärung ein Land, das so viel mehr zu bieten hat als hohe Berge, Käsefondue und zartschmelzende Schokolade.
Hinweis:
Wenn du auf den entsprechenden Buchumschlag draufklickst kommst du direkt zum Webshop medien.meos.ch

Warum dieses Buch?
Schulen, Medien, Journalisten und Wissenschaftler berieseln uns leider täglich mit angeblichen Fakten zur Geschichte Europas. An allem Negativen soll das Christentum schuld sein, an allem Fortschritt und Menschenrechten dagegen der Humanismus. Klar, dass die Menschen das Vertrauen in die Bibel verlieren.
Dabei sagen die historischen Fakten das genaue Gegenteil, wenn man ohne Vorurteile hinschaut. Es ist höchste Zeit, diese Lügen aufzudecken.
Dieses Buch ergänzt die kurz gehaltene Webseite. Es ist für Leser, die in zusammengefasster Form noch mehr Details und Zusammenhänge verstehen wollen. Danke für deine Aufmerksamkeit.
Kurt Beutler